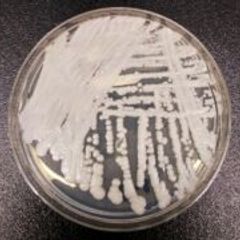

| |
Current News Review at 1 p.m. EST Daily
Current News: https://www.inoreader.com/stream/user/1006407045/tag/Current%20News/view/html?cs=m&sb=y
The News And Times - https://thenewsandtimes.blogspot.com/
Current Selected Articles: https://www.inoreader.com/stream/user/1006407045/tag/user-favorites/view/html
All Current Articles: https://www.inoreader.com/stream/user/1006407045/tag/all-articles/view/html |
|
|
|
| BJP most important, least understood foreign national party: Report | Mint - Mint |
| BJP most important, least understood foreign national party: Report | Mint Mint |
 "Putin seeks foreign volunteers" - Google News "Putin seeks foreign volunteers" - Google News | 1m | |
|
|
|
 | Special Rapporteur's Mandate on Foreign Interference Probe Released |
| Prime Minister Justin Trudeau's office announced the mandate of Independent Special Rapporteur David... |
 The Epoch Times | The Epoch Times The Epoch Times | The Epoch Times | 1m | |
|
|
|
 | LIVE 1:45 PM ET: Biden Speaks at White House Conservation Summit |
| President Joe Biden delivers remarks at the White House conservation summit at 1:45 p.m. ET on March... |
 The Epoch Times | The Epoch Times The Epoch Times | The Epoch Times | 1m | |
|
|
|
 | Inflation Falls Sharpest in February Since Covid Recession |
| Inflation in Canada saw a sharp deceleration in the month of February to reach a 5.2 percent year-over-year... |
 The Epoch Times | The Epoch Times The Epoch Times | The Epoch Times | 1m | |
|
|
|
 | HK Falls to 33Rd in World's Best Airport Rankings, Seattle-Tacoma International of... |
| British aviation rating agency Skytrax released on March 15 the "World Airport Awards 2023." Hong Kong... |
 The Epoch Times | The Epoch Times The Epoch Times | The Epoch Times | 1m | |
|
|
|
 | Tory Councillor Suspended for Saying She Doesn't Want 'Pride Sex' or 'Heterosexual'... |
| A Tory councillor who said she didn't want "Pride sex flags" along her local high street and that "sex... |
 The Epoch Times | The Epoch Times The Epoch Times | The Epoch Times | 1m | |
|
|
|
 | US Beef Prices Expected to Jump due to Supply Concerns |
| Beef prices are expected to jump in the coming months as domestic supplies continue to shrink, according... |
 The Epoch Times | The Epoch Times The Epoch Times | The Epoch Times | 1m | |
|
|
|
 | How to Protect Your Money in a Bank Failure |
| Two large banks in the United States, Silicon Valley Bank and Signature Bank, have recently failed. Most... |
 The Epoch Times | The Epoch Times The Epoch Times | The Epoch Times | 1m | |
|
|
|
 | Canadian Government Paid Half a Billion in Bonuses During Pandemic: Taxpayer Federation |
| Almost every executive in the federal government—98 percent—received bonuses last year totalling just... |
 The Epoch Times | The Epoch Times The Epoch Times | The Epoch Times | 1m | |
|
|
|
 | Bill Gates Plots a Global Pandemic Prison State |
| Commentary An epic disaster like the COVID response, one might suppose, should inspire some humility... |
 The Epoch Times | The Epoch Times The Epoch Times | The Epoch Times | 1m | |
|
|
|
 | Coping With Connections |
| Today's giant airlines—as well as many smaller ones—make their business on connections. The pervasive... |
 The Epoch Times | The Epoch Times The Epoch Times | The Epoch Times | 1m | |
|
|
|
 | Fighting 'Donorism': Will DeSantis Fall Behind Ramaswamy? |
| Commentary The question "Will Ron DeSantis soon fall behind Vivek Ramaswamy?" may be premature—for now—but... |
 The Epoch Times | The Epoch Times The Epoch Times | The Epoch Times | 1m | |
|
|
|
| Radio Station WHMI 93.5 FM — Livingston County Michigan News ... - WHMI |
| Radio Station WHMI 93.5 FM — Livingston County Michigan News ... WHMI |
 "National security adviser Jake Sullivan" - Google News "National security adviser Jake Sullivan" - Google News | 1m | |
|
|
|
| Russia blasts UK move to send ammo with depleted uranium to ... - Reuters |
| Russia blasts UK move to send ammo with depleted uranium to ... Reuters |
 "shoigu" - Google News "shoigu" - Google News | 4m | |
|
|
|
| Russian defense minister warns of possible 'nuclear collision': Report - Al Arabiya... |
| Russian defense minister warns of possible 'nuclear collision': Report Al Arabiya English |
 "shoigu" - Google News "shoigu" - Google News | 4m | |
|
|
|
| Japan's PM Kishida visits Bucha: feels “great anger at the atrocity”... |
| Japan's PM Kishida visits Bucha: feels "great anger at the atrocity" Euromaidan Press |
 "Bucha" - Google News "Bucha" - Google News | 5m | |
|
|
|
| Japanese Prime Minister Kishida mourns civilian victims in Bucha | NHK WORLD-JAPAN... |
| Japanese Prime Minister Kishida mourns civilian victims in Bucha | NHK WORLD-JAPAN News NHK WORLD |
 "Bucha" - Google News "Bucha" - Google News | 5m | |
|
|
|
| Japanese PM Kishida offers Ukraine support as China's president ... - Independent.ie |
| Japanese PM Kishida offers Ukraine support as China's president ... Independent.ie |
 "Bucha" - Google News "Bucha" - Google News | 5m | |
|
|
|
| Student's photos from Ukraine featured in local museum - News 13 Orlando |
| Student's photos from Ukraine featured in local museum News 13 Orlando |
 "Bucha" - Google News "Bucha" - Google News | 5m | |
|
|
|
| Putin's soldiers 'who shot dead three young volunteers are unmasked' - Daily Mail |
| Putin's soldiers 'who shot dead three young volunteers are unmasked' Daily Mail |
 "Bucha" - Google News "Bucha" - Google News | 5m | |
|
|
|
| |
| Russian and Ukrainian officials on Tuesday gave conflicting accounts of what appeared to be a brazen... |
 The Associated Press (Twitter) The Associated Press (Twitter) | 5m | |
|
|
|
 | |
| Keanu Reeves mourns the death of his friend and co-star Lance Reddick while at the "John Wick: Chapter... |
 The Associated Press (Twitter) The Associated Press (Twitter) | 5m | |
|
|
|
| |
| "Succession" star Sarah Snook had a surprise reveal at the show's season four premiere — she is pregnant... |
 The Associated Press (Twitter) The Associated Press (Twitter) | 5m | |
|
|
|
| |
| The Associated Press retweeted: Sticking to his roots: Police said that... |
 The Associated Press (Twitter) The Associated Press (Twitter) | 5m | |
|
|
|
| |
| MacKenzie Scott is launching a $250 million "open call" for community-focused nonprofits that the billionaire... |
 The Associated Press (Twitter) The Associated Press (Twitter) | 5m | |
|
|
|
| |
| U.S. cases of a dangerous fungus tripled over just three years, and more than half of states have now... |
 The Associated Press (Twitter) The Associated Press (Twitter) | 5m | |
|
|
|
| Australia PM visits Fiji to discuss nuclear submarines, regional security - Yahoo... |
| Australia PM visits Fiji to discuss nuclear submarines, regional security Yahoo Finance |
 "covid -19 origins" - Google News "covid -19 origins" - Google News | 5m | |
|
|
|
| Trump throws GOP retreat off course - Yahoo News |
| Trump throws GOP retreat off course Yahoo News |
 "Election 2016 Investigations" - Google News "Election 2016 Investigations" - Google News | 5m | |
|
|
|
| 'We call him Emperor Putin': Beijingers share views as Xi visits Russia - FRANCE... |
| 'We call him Emperor Putin': Beijingers share views as Xi visits Russia FRANCE 24 English |
 "Putin in Beijing" - Google News "Putin in Beijing" - Google News | 6m | |
|
|
|
| Russia-Ukraine war: Wagner Group to lose significant number of troops, informs UK... |
| Russia-Ukraine war: Wagner Group to lose significant number of troops, informs UK Intel Republic World |
 "russia-ukraine war news" - Google News "russia-ukraine war news" - Google News | 6m | |
|
|
|
| U.S. Speeds Up Abrams Tank Delivery To Ukraine War Zone - HuffPost |
| U.S. Speeds Up Abrams Tank Delivery To Ukraine War Zone HuffPost |
 "russia-ukraine war" - Google News "russia-ukraine war" - Google News | 6m | |
|
|
|
| Putin, Xi agree 'strategic cooperation' in Kremlin talks - The Economic Times |
| Putin, Xi agree 'strategic cooperation' in Kremlin talks The Economic Times |
 "Russia - China new strategic alliance by Putin and Xi" - Google News "Russia - China new strategic alliance by Putin and Xi" - Google News | 7m | |
|
|
|
| Chinese public not buying Beijing's rosy view of Xi-Putin meeting following arrest... |
| Chinese public not buying Beijing's rosy view of Xi-Putin meeting following arrest warrant Yahoo! Voices |
 "Russia - China new strategic alliance by Putin and Xi" - Google News "Russia - China new strategic alliance by Putin and Xi" - Google News | 7m | |
|
|
|
| Producer claims Fox coerced testimony in Dominion libel case |
| |
 All Stories All Stories | 7m | |
|
|
|
| What to know about Alvin Bragg, Manhattan district attorney |
| |
 All Stories All Stories | 7m | |
|
|
|
| How to Fly a Fighter Jet and Channel Your Inner Maverick - Barron's |
| How to Fly a Fighter Jet and Channel Your Inner Maverick Barron's |
 "Air Superiority Over Ukraine" - Google News "Air Superiority Over Ukraine" - Google News | 7m | |
|
|
|
| Marjorie Taylor Greene sells T-shirts claiming monkeypox is a hoax - The Independent |
| Marjorie Taylor Greene sells T-shirts claiming monkeypox is a hoax The Independent |
 "monkeypox" - Google News "monkeypox" - Google News | 7m | |
|
|
|
| Vladimir Putin, Xi Jinping sign economic deal in latest demonstration of 'friendship... |
| Vladimir Putin, Xi Jinping sign economic deal in latest demonstration of 'friendship without limits' Fox... |
 "Putin and Xi Jinping" - Google News "Putin and Xi Jinping" - Google News | 8m | |
|
|
|
| Putin, Xi Jinping wrap up talks in the Kremlin - Trend News Agency |
| Putin, Xi Jinping wrap up talks in the Kremlin Trend News Agency |
 "Putin and Xi Jinping" - Google News "Putin and Xi Jinping" - Google News | 8m | |
|
|
|
| Trump's Biggest Problem Isn't In New York: 'Like Dominos Falling' - Newsweek |
| Trump's Biggest Problem Isn't In New York: 'Like Dominos Falling' Newsweek |
 trump - Google News trump - Google News | 9m | |
|
|
|
| Donald Trump Lands His First No. 1 Hit On A Billboard Chart - Forbes |
| Donald Trump Lands His First No. 1 Hit On A Billboard Chart Forbes |
 trump - Google News trump - Google News | 9m | |
|
|
|
| Bomb Threat Called In to New York Court Where Trump Hearing Held - Bloomberg |
| Bomb Threat Called In to New York Court Where Trump Hearing Held Bloomberg |
 trump - Google News trump - Google News | 9m | |
|
|
|
| If They Can Come for Trump, They Can Come for Everyone - The Atlantic |
| If They Can Come for Trump, They Can Come for Everyone The Atlantic |
 trump - Google News trump - Google News | 9m | |
|
|
|
| Manhattan DA targeting Trump a historic 'abuse of prosecutorial discretion': Harvard... |
| Manhattan DA targeting Trump a historic 'abuse of prosecutorial discretion': Harvard Law professor emeritus Fox... |
 trump - Google News trump - Google News | 9m | |
|
|
|
| In Trump case, NY grand jury appears near end of its work - FOX 5 New York |
| In Trump case, NY grand jury appears near end of its work FOX 5 New York |
 trump - Google News trump - Google News | 9m | |
|
|
|
| DeSantis opposes more aid in Ukraine. Zelensky says that's short-sighted. - Tampa... |
| DeSantis opposes more aid in Ukraine. Zelensky says that's short-sighted. Tampa Bay Times |
 "zelensky" - Google News "zelensky" - Google News | 10m | |
|
|
|
| N.B. adds 8 more COVID-19 deaths, test positivity rate hits nearly year-long high... |
| N.B. adds 8 more COVID-19 deaths, test positivity rate hits nearly year-long high CBC.ca |
 "XBB.1.5" - Google News "XBB.1.5" - Google News | 10m | |
|
|
|
 | Hunter Biden Has Big Problems – This Time With China |
| Hunter Biden is one inconvenient presidential son. Whether it's his business dealings, a cursed laptop,... |
 19FortyFive 19FortyFive | 11m | |
|
|
|
 | Watch: Ukraine's Farmers Keep Stealing Russian Tanks with Tractors |
| Last week, Ukraine's armed forces claimed that Russia had lost 21 tanks in a single day. In addition... |
 19FortyFive 19FortyFive | 11m | |
|
|
|
| Biden is Competing with Republicans on China - Inkstick |
| Biden is Competing with Republicans on China Inkstick |
 "Avril Haines" - Google News "Avril Haines" - Google News | 12m | |
|
|
|
| Trumped-Up Charges? - The Dispatch |
| Trumped-Up Charges? The Dispatch |
 "Avril Haines" - Google News "Avril Haines" - Google News | 12m | |
|
|
|
| Continuous Intelligence Platform Market (New Report) Revenue ... - Digital Journal |
| Continuous Intelligence Platform Market (New Report) Revenue ... Digital Journal |
 "Intelligence Assessments of Russia Ukraine War 2022" - Google News "Intelligence Assessments of Russia Ukraine War 2022" - Google News | 12m | |
|
|
|
| Just Eat Takeaway lays off 1,700 couriers in employment U-turn |
| Group previously sought to set itself apart in UK by moving away from gig economy |
 Markets and Business News Review Markets and Business News Review | 13m | |
|
|
|
| How a warrant for Putin puts new spin on Xi visit to Russia - The Associated Press |
| How a warrant for Putin puts new spin on Xi visit to Russia The Associated Press |
 "Putin and Xi" - Google News "Putin and Xi" - Google News | 14m | |
|
|
|
| David Hunter trial: Coal miner's confession he killed wife was lawfully obtained,... |
| David Hunter trial: Coal miner's confession he killed wife was lawfully obtained, Cyprus court rules Yahoo... |
 "Is Putin ill with blood cancer?" - Google News "Is Putin ill with blood cancer?" - Google News | 14m | |
|
|
|
| Top Republican says he returned donations from a recent fundraiser at Signature Bank... |
| Top Republican says he returned donations from a recent fundraiser at Signature Bank headquarters AOL |
 "Crimean Bridge explosion" - Google News "Crimean Bridge explosion" - Google News | 15m | |
|
|
|
| Home sales spike 14.5% in February as the median price drops for the first time in... |
| Home sales spike 14.5% in February as the median price drops for the first time in over a decade AOL |
 "Crimean Bridge explosion" - Google News "Crimean Bridge explosion" - Google News | 15m | |
|
|
|
| Day four of demonstrators showing support for Trump amid possible indictment - WPEC |
| Day four of demonstrators showing support for Trump amid possible indictment WPEC |
 "Mar-a-Lago" - Google News "Mar-a-Lago" - Google News | 15m | |
|
|
|
| Trump supporters gather near Mar-a-Lago ahead of his possible indictment - WFTV Orlando |
| Trump supporters gather near Mar-a-Lago ahead of his possible indictment WFTV Orlando |
 "Mar-a-Lago" - Google News "Mar-a-Lago" - Google News | 15m | |
|
|
|
| Trump Braces for Indictment as Supporters Rally Outside Mar-a-Lago - NewsRadio WFLA |
| Trump Braces for Indictment as Supporters Rally Outside Mar-a-Lago NewsRadio WFLA |
 "Mar-a-Lago" - Google News "Mar-a-Lago" - Google News | 15m | |
|
|
|
| Gwyneth Paltrow's trial begins for Deer Valley ski crash |
| AP correspondent Margie Szaroleta reports on Gwyneth Paltrow-Skiing Lawsuit. |
 AP Audio Wire AP Audio Wire | 16m | |
|
|
|
| A Florida bill could ban schoolgirls under 11 learning about periods - AOL |
| A Florida bill could ban schoolgirls under 11 learning about periods AOL |
 "US Intel: Putin gave orders to invade Ukraine" - Google News "US Intel: Putin gave orders to invade Ukraine" - Google News | 17m | |
|
|
|
| West should take China's peace proposal for Ukraine seriously, Putin says - CBC News |
| West should take China's peace proposal for Ukraine seriously, Putin says CBC News |
 "G7 and Russia Ukraine war" - Google News "G7 and Russia Ukraine war" - Google News | 18m | |
|
|
|
| Brace yourselves, the oil war is here - Philstar.com |
| Brace yourselves, the oil war is here Philstar.com |
 "G7 and Russia Ukraine war" - Google News "G7 and Russia Ukraine war" - Google News | 18m | |
|
|
|
| Biden signs bill declassifying information on the origin of COVID-19 ... - Tennessee... |
| Biden signs bill declassifying information on the origin of COVID-19 ... Tennessee Lookout |
 "COVID" - Google News "COVID" - Google News | 18m | |
|
|
|
 | US to send Patriot missile systems to Ukraine faster than originally planned |
| • Exclusive: Russian soldier accused of war crimes in absentia after audio files intercepted • See the... |
 CNN.com - Top Stories CNN.com - Top Stories | 18m | |
|
|
|
 | Shaquille O'Neal shares reason for his hospitalization |
| Shaquille O'Neal's followers were worried when they saw on social media that he was in a hospital bed. |
 CNN.com - Top Stories CNN.com - Top Stories | 18m | |
|
|
|
| Putin has 'aggressively' tried to make China his ally because Russia ... - msnNOW |
| Putin has 'aggressively' tried to make China his ally because Russia ... msnNOW |
 "hostomel airport" - Google News "hostomel airport" - Google News | 18m | |
|
|
|
 | What to know about Alvin Bragg, Manhattan district attorney |
| A New York grand jury investigating hush payments made on Donald Trump's behalf during the 2016 presidential... |
 Associated Press News: Breaking News | Latest News Today Associated Press News: Breaking News | Latest News Today | 19m | |
|
|
|
| The Hill's 12:30 Report — Xi invites Putin to visit China - The Hill |
| The Hill's 12:30 Report — Xi invites Putin to visit China The Hill |
 "Putin Biden summit" - Google News "Putin Biden summit" - Google News | 20m | |
|
|
|
| Putin accuses Ukraine of not wanting Chinese peace plan - Euronews |
| Putin accuses Ukraine of not wanting Chinese peace plan Euronews |
 "Putin Biden summit" - Google News "Putin Biden summit" - Google News | 20m | |
|
|
|
| What's up with… AWS, Telecom Italia, Telenet, Liberty Global - TelecomTV |
| What's up with… AWS, Telecom Italia, Telenet, Liberty Global TelecomTV |
 "global threats to U.S. security 2023" - Google News "global threats to U.S. security 2023" - Google News | 22m | |
|
|
|
| Possible NYC protests: In case of Donald Trump indictment, New ... - KFSN-TV |
| Possible NYC protests: In case of Donald Trump indictment, New ... KFSN-TV |
 "Mar-a-Lago searched by FBI 2022" - Google News "Mar-a-Lago searched by FBI 2022" - Google News | 24m | |
|
|
|
| Will Trump be arrested today? What you need to know - AL.com |
| Will Trump be arrested today? What you need to know AL.com |
 "Mar-a-Lago searched by FBI 2022" - Google News "Mar-a-Lago searched by FBI 2022" - Google News | 24m | |
|
|
|
| NATO to hold Ukraine meeting despite Hungary's objections - The Hill |
| NATO to hold Ukraine meeting despite Hungary's objections The Hill |
 "Ukraine" - Google News "Ukraine" - Google News | 25m | |
|
|
|
| US to send Patriot missile systems to Ukraine faster than originally planned - CNN |
| US to send Patriot missile systems to Ukraine faster than originally planned CNN |
 "Ukraine" - Google News "Ukraine" - Google News | 25m | |
|
|
|
| US speeds up Abrams tank delivery to Ukraine war zone - The Associated Press |
| US speeds up Abrams tank delivery to Ukraine war zone The Associated PressUS to accelerate delivery... |
 "Ukraine" - Google News "Ukraine" - Google News | 25m | |
|
|
|
| Statement by the Members of the European Council - Présidence française... |
| Statement by the Members of the European Council Présidence française du Conseil de l'Union européenne... |
 "Ukraine" - Google News "Ukraine" - Google News | 25m | |
|
|
|
| Rally for Life in Denison to feature nationally known speaker Luana ... - Denison... |
| Rally for Life in Denison to feature nationally known speaker Luana ... Denison Bulletin Review |
 "Stoltenberg" - Google News "Stoltenberg" - Google News | 25m | |
|
|
|
| Alterra Mountain Company Plans to Invest Nearly Half a Billion ... - businesswire.com |
| Alterra Mountain Company Plans to Invest Nearly Half a Billion ... businesswire.com |
 "project raven" - Google News "project raven" - Google News | 26m | |
|
|
|
| Japan's Kishida Visits Ukraine to Meet with Zelensky | Time – TIME |
| Japan's Kishida Visits Ukraine to Meet with Zelensky | Time TIME The post Japan's Kishida Visits Ukraine... |
 Russia - Ukraine War | The Russia News Russia - Ukraine War | The Russia News | 26m | |
|
|
|
| Jens Stoltenberg: 'President Putin wants a different Europe' – DW – 03/21/2023 –... |
| Jens Stoltenberg: 'President Putin wants a different Europe' – DW – 03/21/2023 DW (English) The post... |
 Russia - Ukraine War | The Russia News Russia - Ukraine War | The Russia News | 26m | |
|
|
|
| NATO to hold Ukraine meeting despite Hungary's objections – Yahoo! Voices |
| NATO to hold Ukraine meeting despite Hungary's objections Yahoo! Voices The post NATO to hold Ukraine... |
 Russia - Ukraine War | The Russia News Russia - Ukraine War | The Russia News | 26m | |
|
|
|
| NATO to hold Ukraine meeting despite Hungary's objections – Danbury News Times |
| NATO to hold Ukraine meeting despite Hungary's objections Danbury News Times The post NATO to hold... |
 Russia - Ukraine War | The Russia News Russia - Ukraine War | The Russia News | 26m | |
|
|
|
| NATO to hold Ukraine meeting despite Hungary's objections – WHIO |
| NATO to hold Ukraine meeting despite Hungary's objections WHIO The post NATO to hold Ukraine meeting... |
 Russia - Ukraine War | The Russia News Russia - Ukraine War | The Russia News | 26m | |
|
|
|
| UPDATE 1-Seven out of 30 allies met NATO military spending target in 2022-Stoltenberg... |
| UPDATE 1-Seven out of 30 allies met NATO military spending target in 2022-Stoltenberg Yahoo Finance... |
 Russia - Ukraine War | The Russia News Russia - Ukraine War | The Russia News | 26m | |
|
|
|
| Ukraine Drone Strikes Major Oil Pipeline Inside Russian Territory: Official – Newsweek |
| Ukraine Drone Strikes Major Oil Pipeline Inside Russian Territory: Official Newsweek The post Ukraine... |
 Russia - Ukraine War | The Russia News Russia - Ukraine War | The Russia News | 26m | |
|
|
|
| NATO to hold Ukraine meeting despite Hungary's objections – WTOP |
| NATO to hold Ukraine meeting despite Hungary's objections WTOP The post NATO to hold Ukraine meeting... |
 Russia - Ukraine War | The Russia News Russia - Ukraine War | The Russia News | 26m | |
|
|
|
| US to send Ukraine USD 350 million in weapons, equipment as … – ANI News |
| US to send Ukraine USD 350 million in weapons, equipment as … ANI News The post US to send Ukraine... |
 Russia - Ukraine War | The Russia News Russia - Ukraine War | The Russia News | 26m | |
|
|
|
| Ukraine news – live: Nato warns of signs Putin has asked China for lethal weapons... |
| Ukraine news – live: Nato warns of signs Putin has asked China for lethal weapons Yahoo News The post... |
 Russia - Ukraine War | The Russia News Russia - Ukraine War | The Russia News | 26m | |
|
|
|
| Orthodox Church Accused by Kyiv of Moscow Links Faces Eviction - U.S. News & World... |
| Orthodox Church Accused by Kyiv of Moscow Links Faces Eviction U.S. News & World Report |
 "kyiv" - Google News "kyiv" - Google News | 27m | |
|
|
|
| Orthodox Church accused by Kyiv of Moscow links faces eviction - Reuters |
| Orthodox Church accused by Kyiv of Moscow links faces eviction Reuters |
 "kyiv" - Google News "kyiv" - Google News | 27m | |
|
|
|
| Putin: China peace plan to be basis for settlement when Kyiv and west are ready -... |
| Putin: China peace plan to be basis for settlement when Kyiv and west are ready ForexLive |
 "kyiv" - Google News "kyiv" - Google News | 27m | |
|
|
|
| Kyiv Hails 'Historic' Japan PM Kishida Visit As 'Sign Of Solidarity' - Barron's |
| Kyiv Hails 'Historic' Japan PM Kishida Visit As 'Sign Of Solidarity' Barron's |
 "kyiv" - Google News "kyiv" - Google News | 27m | |
|
|
|
| Japan's PM offers Ukraine support as China's Xi backs Russia - KOLN |
| Japan's PM offers Ukraine support as China's Xi backs Russia KOLN |
 "kyiv" - Google News "kyiv" - Google News | 27m | |
|
|
|
| US Speeds Up Abrams Tank Delivery to Ukraine War Zone - Military.com |
| US Speeds Up Abrams Tank Delivery to Ukraine War Zone Military.com |
 "Russia-Ukraine war" - Google News "Russia-Ukraine war" - Google News | 27m | |
|
|
|
| Pentagon speeds up tank delivery to Ukraine war zone - WKRC TV Cincinnati |
| Pentagon speeds up tank delivery to Ukraine war zone WKRC TV Cincinnati |
 "Russia-Ukraine war" - Google News "Russia-Ukraine war" - Google News | 27m | |
|
|
|
 | Wall St climbs as bank contagion fears ebb, focus on Fed meet |
| 2023-03-21T16:05:16ZInvestors on Tuesday (March 21) took some heart from the rescue of troubled lender... |
| |
|
|
|
 | Asteroid discovery suggests ingredients for life on Earth came from space |
| 2023-03-21T16:06:21ZTwo organic compounds essential for living organisms have been found in samples retrieved... |
| |
|
|
|
 | China"s Xi appeared more relaxed than Putin in first Moscow meeting, experts say |
| 2023-03-21T16:09:25ZBody language experts say Chinese President Xi Jinping came across as more relaxed... |
| |
|
|
|
 | Kremlin says Putin and Xi discussed Chinese peace proposal |
| 2023-03-21T10:10:38ZRussian President Vladimir Putin and Chinese President Xi Jinping attend a meeting... |
| |
|
|
|
| Vladimir Putin's defiance in the face of an international arrest warrant - Yahoo... |
| Vladimir Putin's defiance in the face of an international arrest warrant Yahoo Life |
 "International criminal court issues arrest warrant for Putin" - Google News "International criminal court issues arrest warrant for Putin" - Google News | 28m | |
|
|
|
| ICC issues arrest warrant against Vladimir Putin amid Ukraine-Russia war - What are... |
| ICC issues arrest warrant against Vladimir Putin amid Ukraine-Russia war - What are the charges? | Mint Mint |
 "International criminal court issues arrest warrant for Putin" - Google News "International criminal court issues arrest warrant for Putin" - Google News | 28m | |
|
|
|
 | Garbage collectors return as trash piles up in Paris |
| (21 Mar 2023) Garbage. Heaps, mounds and piles of it are growing daily and in some places standing as... |
 Associated Press Associated Press | 29m | |
|
|
|
 | Paris protesters set garbage on fire following Pres. Macron's retirement bill push.... |
| The Associated Press is the essential global news network, delivering fast, unbiased news from every... |
 Associated Press Associated Press | 29m | |
|
|
|
 | Los altos precios de los alimentos afectan a los preparativos del Ramadán en el Líbano |
| (21 Mar 2023) La crisis económica del Líbano ensombrece el mes sagrado del ramadán, en que los fieles... |
 Associated Press Associated Press | 29m | |
|
|
|
 | Keanu Reeves mourns the death of his friend and co-star Lance Reddick. #shorts |
| Keanu Reeves mourns the death of his friend and co-star Lance Reddick while at the "John Wick: Chapter... |
 Associated Press Associated Press | 29m | |
|
|
|
 | Gwyneth Paltrow is scheduled to stand trial Tuesday in a lawsuit filed for a 2016... |
| Gwyneth Paltrow is scheduled to stand trial on Tuesday in a lawsuit filed by a retired optometrist claiming... |
 Associated Press Associated Press | 29m | |
|
|
|
 | Cherry blossoms open ahead of annual festival in Washington, D.C. | LIVE |
| Tourists and residents alike flock to see the cherry blossoms at the Tidal Basin in West Potomac Park,... |
 Associated Press Associated Press | 29m | |
|
|
|
| ABC News Live: Officials prepare for fallout of possible Trump indictment - Yahoo!... |
| ABC News Live: Officials prepare for fallout of possible Trump indictment Yahoo! Voices |
 "Russia plans to annex parts of eastern Ukraine" - Google News "Russia plans to annex parts of eastern Ukraine" - Google News | 29m | |
|
|
|
| NCAA Sweet 16 Preview: Arkansas vs UConn - Razorbacks Arkansas |
| NCAA Sweet 16 Preview: Arkansas vs UConn Razorbacks Arkansas |
 "g-7 2022" - Google News "g-7 2022" - Google News | 30m | |
|
|
|
 | |
| March 20 Assessment Highlight: #Ukrainian Main Intelligence Directorate (GUR) Spokesperson Andriy... |
 ISW (Twitter) ISW (Twitter) | 30m | |
|
|
|
| |
| The deal comes as #Russia grows concerned at a #Ukrainian counter-offensive near #Bakhmut or in southern... |
 ISW (Twitter) ISW (Twitter) | 30m | |
|
|
|
| General Staff: Explosions in Dzhankoi aim to complicate enemy's logistics in Melitopol... |
| General Staff: Explosions in Dzhankoi aim to complicate enemy's logistics in Melitopol and Kherson Ukrinform |
 "kherson" - Google News "kherson" - Google News | 31m | |
|
|
|
| Belarus says it's discovered weapons for 'terrorist' attacks - The Associated Press |
| Belarus says it's discovered weapons for 'terrorist' attacks The Associated Press |
 "weapons for ukraine" - Google News "weapons for ukraine" - Google News | 31m | |
|
|
|
| Ukraine to receive Abrams tanks from US as soon as this fall-sources - Reuters.com |
| Ukraine to receive Abrams tanks from US as soon as this fall-sources Reuters.com |
 "weapons for ukraine" - Google News "weapons for ukraine" - Google News | 31m | |
|
|
|
| Multiple COVID variants found in New York rats: study - The Hill |
| Multiple COVID variants found in New York rats: study The Hill |
 "omicron in rats" - Google News "omicron in rats" - Google News | 32m | |
|
|
|
| |
| I spoke with Azerbaijani President Aliyev today to convey my support for a sustainable peace with Armenia... |
 Secretary Antony Blinken (Twitter) Secretary Antony Blinken (Twitter) | 33m | |
|
|
|
 | Japan PM Kishida visits Bucha in 'historic' Ukraine trip - The Straits Times |
| The Straits Times |
 "Bucha" - Google News "Bucha" - Google News | 34m | |
|
|
|
 | Putin: China has peace plan for Ukraine when West is ready - Greenwich Time |
| Greenwich Time |
 "Bucha" - Google News "Bucha" - Google News | 34m | |
|
|
|
| 🔴Live: Xi says ties with Russia are a priority during Moscow trip - Yahoo News UK |
| 🔴Live: Xi says ties with Russia are a priority during Moscow trip Yahoo News UK |
 "Bucha" - Google News "Bucha" - Google News | 34m | |
|
|
|
 | Russian attacks against civilians in Ukraine amount to war crimes ... - St. Louis... |
| St. Louis Post-Dispatch |
 "Bucha" - Google News "Bucha" - Google News | 34m | |
|
|
|
| Anadolu Agency's Morning Briefing - March 21, 2023 - Anadolu Agency | English |
| Anadolu Agency's Morning Briefing - March 21, 2023 Anadolu Agency | English |
 "Russians halt their offensive in Ukraine" - Google News "Russians halt their offensive in Ukraine" - Google News | 34m | |
|
|
|
 | |
| Hundreds of protesters set garbage bins and plastic bags on fire in the streets of Paris, following the... |
 The Associated Press (Twitter) The Associated Press (Twitter) | 35m | |
|
|
|
| |
| TikTok has rolled out updated rules and standards for content and users as it faces increasing pressure... |
 The Associated Press (Twitter) The Associated Press (Twitter) | 35m | |
|
|
|
| |
| Medical experts made repeated efforts to kickstart plans for exiting China's zero-COVID measures. Those... |
 The Associated Press (Twitter) The Associated Press (Twitter) | 35m | |
|
|
|
| Putin, Xi agree 'strategic cooperation' in Kremlin talks - ThePrint |
| Putin, Xi agree 'strategic cooperation' in Kremlin talks ThePrint |
 "Russia - China new strategic alliance by Putin and Xi" - Google News "Russia - China new strategic alliance by Putin and Xi" - Google News | 37m | |
|
|
|
| Traffic deaths avoidable tragedies - Odessa American |
| Traffic deaths avoidable tragedies Odessa American |
 "Odessa" - Google News "Odessa" - Google News | 37m | |
|
|
|
| Superbug fungus cases rose dramatically during pandemic |
| |
 All Stories All Stories | 38m | |
|
|
|
| Mountain lion claws man hot-tubbing in Colorado high country |
| |
 All Stories All Stories | 38m | |
|
|
|
| Putin says British plans to deliver ammunition with depleted uranium to Ukraine would... |
| |
 All Stories All Stories | 38m | |
|
|
|
| Russia's Putin says China's proposal could be the basis for a peaceful settlement... |
| |
 All Stories All Stories | 38m | |
|
|
|
| US Sends More Ammo to Ukraine as Russia and China Meet - VICE |
| US Sends More Ammo to Ukraine as Russia and China Meet VICE |
 "Air Superiority Over Ukraine" - Google News "Air Superiority Over Ukraine" - Google News | 38m | |
|
|
|
| Trump Is Taking His Looming Criminal Indictment in Typical Stride—By Losing His Mind... |
| Trump Is Taking His Looming Criminal Indictment in Typical Stride—By Losing His Mind Vanity Fair |
 trump - Google News trump - Google News | 38m | |
|
|
|
| Sex, Shark Week, and Hush Money: A Trump and Stormy Daniels Timeline - Rolling Stone |
| Sex, Shark Week, and Hush Money: A Trump and Stormy Daniels Timeline Rolling Stone |
 trump - Google News trump - Google News | 38m | |
|
|
|
| Trump news live updates: N.Y. grand jury could render indictment in hush money case... |
| Trump news live updates: N.Y. grand jury could render indictment in hush money case NBC News |
 trump - Google News trump - Google News | 38m | |
|
|
|
| McCarthy again slams Manhattan DA in defense of Trump - ABC News |
| McCarthy again slams Manhattan DA in defense of Trump ABC News |
 trump - Google News trump - Google News | 38m | |
|
|
|
| What being 'Soros-backed' means, as Trump called DA Alvin Bragg - The Washington... |
| What being 'Soros-backed' means, as Trump called DA Alvin Bragg The Washington Post |
 trump - Google News trump - Google News | 38m | |
|
|
|
| Pilot Who Bombed Kharkiv TV Tower Convicted | Institute for War ... - Institute for... |
| Pilot Who Bombed Kharkiv TV Tower Convicted | Institute for War ... Institute for War & Peace Reporting... |
 "kharkiv" - Google News "kharkiv" - Google News | 39m | |
|
|
|
| Ukraine returns home 15 more children - Ombudsman - Euromaidan Press |
| Ukraine returns home 15 more children - Ombudsman Euromaidan Press |
 "kharkiv" - Google News "kharkiv" - Google News | 39m | |
|
|
|
| Характеристика главных и второстепенных персонажей комедии ... - Форпост-Севастополь... |
| Характеристика главных и второстепенных персонажей комедии ... Форпост-Севастополь - информационный... |
 "русско украинские мирные переговоры" - Google Новости "русско украинские мирные переговоры" - Google Новости | 39m | |
|
|
|
| Father charged months after 2-year-old son drowns in neighbors' pool, Tennessee cops... |
| Father charged months after 2-year-old son drowns in neighbors' pool, Tennessee cops say Idaho Statesman |
 "Idaho murders" - Google News "Idaho murders" - Google News | 39m | |
|
|
|
| 'You're a street fighter,' McClain counseled Madigan: wiretapped call - WGEM |
| 'You're a street fighter,' McClain counseled Madigan: wiretapped call WGEM |
 "FBI and election 2016" - Google News "FBI and election 2016" - Google News | 39m | |
|
|
|
| vladimir putin: Putin-Xi Jinping meet: China seeks political solution ... - The Economic... |
| vladimir putin: Putin-Xi Jinping meet: China seeks political solution ... The Economic Times |
 "Putin and Xi Jinping" - Google News "Putin and Xi Jinping" - Google News | 39m | |
|
|
|
| China's Xi arrives in Moscow for first visit since Russia invaded Ukraine - CNN International |
| China's Xi arrives in Moscow for first visit since Russia invaded Ukraine CNN International |
 "Putin and Xi Jinping" - Google News "Putin and Xi Jinping" - Google News | 39m | |
|
|
|
| Prigozhin throws down another gauntlet to Shoigu and the General ... - en.thebell.io |
| Prigozhin throws down another gauntlet to Shoigu and the General ... en.thebell.io |
 "general. gerasimov" - Google News "general. gerasimov" - Google News | 39m | |
|
|
|
 | Chinese Consulate Worker Recounts Escape to Freedom |
| It has been five years since Dong Luobin told New Zealand police "If you send me back to the consulate... |
 The Epoch Times | The Epoch Times The Epoch Times | The Epoch Times | 40m | |
|
|
|
 | US, China, and Russia Clash Over North Korea's Missile Launches at UN Meeting |
| The United States urged China and Russia to "stop shielding" North Korea from any sanctions by the United... |
 The Epoch Times | The Epoch Times The Epoch Times | The Epoch Times | 40m | |
|
|
|
| Japan's PM offers Ukraine support as China's Xi backs Russia - WCJB |
| Japan's PM offers Ukraine support as China's Xi backs Russia WCJB |
 "Russia Ukraine peace talks" - Google News "Russia Ukraine peace talks" - Google News | 42m | |
|
|
|
| Prescott Group Capital Management Now Owns 20.9% of Performant Financial |
| Fintel reports that Prescott Group Capital Management, L.l.c. has filed a 13D/A form with the SEC disclosing... |
 Markets and Business News Review Markets and Business News Review | 43m | |
|
|
|
 | With Credit Suisse Investors The Latest To See Massive Losses, Are More Bank Failures... |
| The sale price will be just $3.25 billion, despite Credit Suisse having a market cap of $8.6 billion... |
 Markets and Business News Review Markets and Business News Review | 43m | |
|
|
|
| Edenbrook Capital Now Owns 14.36% of Brightcove |
| Fintel reports that Edenbrook Capital has filed a 13D/A form with the SEC disclosing ownership of 6.08MM... |
 Markets and Business News Review Markets and Business News Review | 43m | |
|
|
|
 | The Week in Business: A Banking Crisis |
| Meta conducts another round of layoffs. Fresh inflation data shows price increases remain stubborn. And... |
 Markets and Business News Review Markets and Business News Review | 43m | |
|
|
|
| Amid Industry Turmoil, Regional Banking ETF Leads Unusual Options Activity |
| Many investors don't pay attention to options because they find them too confusing and there can be multiple... |
 Markets and Business News Review Markets and Business News Review | 43m | |
|
|
|
 | Pentagon Plan For Amphibious Warships Would Violate Law, Hobble Crisis Response |
| The Pentagon's apparent plan for amphibious warships would derail modernization of an aging fleet. |
 Markets and Business News Review Markets and Business News Review | 43m | |
|
|
|
| Earnings Previews: Accenture, Darden Restaurants, General Mills |
| In the mid-morning trading on Tuesday, the Dow Jones industrials were up 0.64%, the S&P 500 up 0.71%... |
 Markets and Business News Review Markets and Business News Review | 43m | |
|
|
|
 | Netflix Ad Supported Tier Is Getting Traction |
| Six months after Netflix debuted its ad supported tier, the streaming giant has been improving their... |
 Markets and Business News Review Markets and Business News Review | 43m | |
|
|
|
 | Will The Cleveland Browns' Defensive Overhaul Make A Difference In 2023? |
| A new coordinator and several new players have been added to a defense that needed a rebuild. |
 Markets and Business News Review Markets and Business News Review | 43m | |
|
|
|
 | Trump Hits No. 1 With 'Justice For All' Song Made With Jan. 6 Arrestees |
| The tune was downloaded over 30,000 times. |
 Markets and Business News Review Markets and Business News Review | 43m | |
|
|
|
 | Lionel Messi Makes Decision On Post-Paris Saint Germain Contract Future - Reports |
| Lionel Messi has made the first decision on his future after his current Paris Saint Germain contract... |
 Markets and Business News Review Markets and Business News Review | 43m | |
|
|
|
| |
| High-speed internet isn't a luxury anymore – it's a necessity. For schoolwork, telemedicine, remote... |
 President Biden (Twitter) President Biden (Twitter) | 45m | |
|
|
|
| Fox News producer alleges network coerced her to give misleading testimony on Dominion... |
| Fox News producer alleges network coerced her to give misleading testimony on Dominion AOL |
 "Crimean Bridge explosion" - Google News "Crimean Bridge explosion" - Google News | 45m | |
|
|
|
| xi jinping: Putin-Xi Jinping, a friendship of convenience? Experts ... - The Economic... |
| xi jinping: Putin-Xi Jinping, a friendship of convenience? Experts ... The Economic Times |
 "Putin and Xi" - Google News "Putin and Xi" - Google News | 46m | |
|
|
|
| Xi Meets Russian Prime Minister After Long Chat With Putin - Bloomberg |
| Xi Meets Russian Prime Minister After Long Chat With Putin Bloomberg |
 "Putin and Xi" - Google News "Putin and Xi" - Google News | 46m | |
|
|
|
 | France: Protests continue after Macron's pension plan push |
| PARIS (AP) — Paris police said Tuesday that 234 people were arrested overnight in the capital mostly... |
 Associated Press News: Breaking News | Latest News Today Associated Press News: Breaking News | Latest News Today | 46m | |
|
|
|
 | Column: Memories abound from 20-plus years of Match Play |
| AUSTIN, Texas (AP) — The end of the World Golf Championships was a matter of time, especially with the... |
 Associated Press News: Breaking News | Latest News Today Associated Press News: Breaking News | Latest News Today | 46m | |
|
|
|
| Trump watch outside Mar-a-Lago and Palm Beach International Airport - Palm Beach... |
| Trump watch outside Mar-a-Lago and Palm Beach International Airport Palm Beach Post |
 "Mar-a-Lago" - Google News "Mar-a-Lago" - Google News | 46m | |
|
|
|
| As world waits to see if Trump is indicted, die-hard fans begin heading to Mar-a-Lago... |
| As world waits to see if Trump is indicted, die-hard fans begin heading to Mar-a-Lago South Florida... |
 "Mar-a-Lago" - Google News "Mar-a-Lago" - Google News | 46m | |
|
|
|
| Papal message to focus on people's right not to migrate - Detroit Catholic |
| Papal message to focus on people's right not to migrate Detroit Catholic |
 "pope francis" - Google News "pope francis" - Google News | 48m | |
|
|
|
 | Supreme Court rules for deaf student in education case |
| WASHINGTON (AP) — The Supreme Court ruled unanimously Tuesday for a a deaf student who sued his public... |
 Associated Press News: Breaking News | Latest News Today Associated Press News: Breaking News | Latest News Today | 48m | |
|
|
|
| Moderna CEO Will Face Sen. Bernie Sanders About Covid Vaccine Pricing at Hearing... |
| Moderna CEO Will Face Sen. Bernie Sanders About Covid Vaccine Pricing at Hearing Barron's |
 "COVID" - Google News "COVID" - Google News | 49m | |
|
|
|
| Efficacy of COVID-19 Vaccines against Severe Illness and Death Reviewed in the Journal... |
| Efficacy of COVID-19 Vaccines against Severe Illness and Death Reviewed in the Journal of American Physicians... |
 "COVID" - Google News "COVID" - Google News | 49m | |
|
|
|
| 'Negative Evidence' on COVID-19 Vaccines and Cancer Reviewed in the Journal of American... |
| 'Negative Evidence' on COVID-19 Vaccines and Cancer Reviewed in the Journal of American Physicians and... |
 "COVID" - Google News "COVID" - Google News | 49m | |
|
|
|
| Dr. Siegel on importance of getting answers on COVID origins - Fox News |
| Dr. Siegel on importance of getting answers on COVID origins Fox News |
 "COVID" - Google News "COVID" - Google News | 49m | |
|
|
|
| Asian art fair aims to bounce back after COVID years - Reuters |
| Asian art fair aims to bounce back after COVID years Reuters |
 "COVID" - Google News "COVID" - Google News | 49m | |
|
|
|
| 12 Project Roomkey trailers to open for San Diego homeless - The San Diego Union-Tribune |
| 12 Project Roomkey trailers to open for San Diego homeless The San Diego Union-Tribune |
 "COVID" - Google News "COVID" - Google News | 49m | |
|
|
|
| Japan's Kishida Visits Ukraine to Meet with Zelensky | Time - TIME |
| Japan's Kishida Visits Ukraine to Meet with Zelensky | Time TIME |
 "Zelensky and Putin" - Google News "Zelensky and Putin" - Google News | 49m | |
|
|
|
 | Restaurant Wine Prices and Obscurity |
| As the COVID-19 pandemic began to wind down over the last year, I noticed a sad trend in some upscale... |
 The Epoch Times | The Epoch Times The Epoch Times | The Epoch Times | 50m | |
|
|
|
| London police chief 'humbled' by withering report on force |
| A scathing study heavily criticises London police on multiple fronts. AP correspondent Charles de Ledesma... |
 AP Audio Wire AP Audio Wire | 53m | |
|
|
|
| Belarus Says It's Discovered Weapons for 'Terrorist' Attacks - U.S. News & World... |
| Belarus Says It's Discovered Weapons for 'Terrorist' Attacks U.S. News & World Report |
 "global threats to U.S. security 2023" - Google News "global threats to U.S. security 2023" - Google News | 53m | |
|
|
|
| Sens. Rick Scott, Mark Warner Introduce Legislation to Ban ... - Senator Rick Scott |
| Sens. Rick Scott, Mark Warner Introduce Legislation to Ban ... Senator Rick Scott |
 "global threats to U.S. security 2023" - Google News "global threats to U.S. security 2023" - Google News | 53m | |
|
|
|
| Stranger shoves man into moving NYC train - New York Post |
| Stranger shoves man into moving NYC train New York Post |
 "Sunset park brooklyn" - Google News "Sunset park brooklyn" - Google News | 54m | |
|
|
|
| NATO to hold Ukraine meeting despite Hungary's objections - Danbury News Times |
| NATO to hold Ukraine meeting despite Hungary's objections Danbury News Times |
 "Stoltenberg" - Google News "Stoltenberg" - Google News | 54m | |
|
|
|
| NATO to hold Ukraine meeting despite Hungary's objections - WHIO |
| NATO to hold Ukraine meeting despite Hungary's objections WHIO |
 "Stoltenberg" - Google News "Stoltenberg" - Google News | 54m | |
|
|
|
| NATO to hold Ukraine meeting despite Hungary's objections - Yahoo! Voices |
| NATO to hold Ukraine meeting despite Hungary's objections Yahoo! Voices |
 "Stoltenberg" - Google News "Stoltenberg" - Google News | 54m | |
|
|
|
| Jens Stoltenberg: 'President Putin wants a different Europe' – DW – 03/21/2023... |
| Jens Stoltenberg: 'President Putin wants a different Europe' – DW – 03/21/2023 DW (English) |
 "Stoltenberg" - Google News "Stoltenberg" - Google News | 54m | |
|
|
|
| UPDATE 1-Seven out of 30 allies met NATO military spending target in 2022-Stoltenberg... |
| UPDATE 1-Seven out of 30 allies met NATO military spending target in 2022-Stoltenberg Yahoo Finance |
 "Stoltenberg" - Google News "Stoltenberg" - Google News | 54m | |
|
|
|
 | AP Headline News - Mar 21 2023 12:00 (EDT) |
| |
 Associated Press Bulletins Associated Press Bulletins | 55m | |
|
|
|
| Dozens of US generals urge Biden to arm Israel against Iran, as ... - The Times of... |
| Dozens of US generals urge Biden to arm Israel against Iran, as ... The Times of Israel |
 "Biden in Israel" - Google News "Biden in Israel" - Google News | 56m | |
|
|
|
| Alterra Mountain Company Plans to Invest Nearly Half a Billion Dollars in Transformational... |
| Alterra Mountain Company Plans to Invest Nearly Half a Billion Dollars in Transformational Changes in... |
 "project raven" - Google News "project raven" - Google News | 56m | |
|
|
|
| New Miss Poway queens, princesses to begin year of community ... - The San Diego... |
| New Miss Poway queens, princesses to begin year of community ... The San Diego Union-Tribune |
 "project raven" - Google News "project raven" - Google News | 56m | |
|
|
|
| Russia Is Expected To Free Violent Offenders Who Fought In Ukraine, UK Claims – Yahoo... |
| Russia Is Expected To Free Violent Offenders Who Fought In Ukraine, UK Claims Yahoo Eurosport UK The... |
 Russia - Ukraine War | The Russia News Russia - Ukraine War | The Russia News | 57m | |
|
|
|
| Revenue Cycle Management (RCM) Global Market Report 2023 – GlobeNewswire |
| Revenue Cycle Management (RCM) Global Market Report 2023 GlobeNewswire The post Revenue Cycle Management... |
 Russia - Ukraine War | The Russia News Russia - Ukraine War | The Russia News | 57m | |
|
|
|
| Spinal Imaging Global Market Report 2023 – GlobeNewswire |
| Spinal Imaging Global Market Report 2023 GlobeNewswire The post Spinal Imaging Global Market Report... |
 Russia - Ukraine War | The Russia News Russia - Ukraine War | The Russia News | 57m | |
|
|
|
 | Trump 2024 Campaign: More Professional and Disciplined? |
| Former President Donald Trump's 2024 presidential campaign is more professional and disciplined than... |
 Russia - Ukraine War | The Russia News Russia - Ukraine War | The Russia News | 57m | |
|
|
|
| NATO to hold Ukraine meeting despite Hungary's objections - WTOP |
| NATO to hold Ukraine meeting despite Hungary's objections WTOP |
 "Ukraine" - Google News "Ukraine" - Google News | 57m | |
|
|
|
| Ukraine Drone Strikes Major Oil Pipeline Inside Russian Territory: Official - Newsweek |
| Ukraine Drone Strikes Major Oil Pipeline Inside Russian Territory: Official Newsweek |
 "Ukraine" - Google News "Ukraine" - Google News | 57m | |
|
|
|
| Republican says he returned donations from Signature Bank fundraiser - NBC News |
| Republican says he returned donations from Signature Bank fundraiser NBC News |
 "Investigations of US Elections 2016" - Google News "Investigations of US Elections 2016" - Google News | 58m | |
|
|
|
| Mexican border state launches search for two missing American minors |
| 2023-03-21T15:35:27ZThe Mexican northern border state of Nuevo Leon has begun a search for two American... |
| |
|
|
|
 | Fox News producer"s lawsuit claims network coerced her to mislead in Dominion testimony |
| 2023-03-21T15:33:02ZNEW YORK (Reuters) - A Fox News producer filed a lawsuit accusing network lawyers... |
| |
|
|
|
 | US targets network supporting Iran"s drone, weapons programs |
| 2023-03-21T15:26:08ZUSA and Iranian flags are seen in this illustration taken, September 8, 2022. REUTERS/Dado... |
| |
|
|
|
| Joe Biden hails decision to issue ICC arrest warrant against Vladimir Putin - The... |
| Joe Biden hails decision to issue ICC arrest warrant against Vladimir Putin The Guardian |
 "International criminal court issues arrest warrant for Putin" - Google News "International criminal court issues arrest warrant for Putin" - Google News | 59m | |
|
|
|
| The Day with Brent Goff: Arrest Warrant for Putin - DW (English) |
| The Day with Brent Goff: Arrest Warrant for Putin DW (English) |
 "International criminal court issues arrest warrant for Putin" - Google News "International criminal court issues arrest warrant for Putin" - Google News | 59m | |
|
|
|
| ICC issues arrest warrant against Putin - Daily Trust |
| ICC issues arrest warrant against Putin Daily Trust |
 "International criminal court issues arrest warrant for Putin" - Google News "International criminal court issues arrest warrant for Putin" - Google News | 59m | |
|
|
|
| Reactions to ICC's arrest warrant for Putin citing Ukraine war crimes - SaltWire... |
| Reactions to ICC's arrest warrant for Putin citing Ukraine war crimes SaltWire Halifax powered by The... |
 "International criminal court issues arrest warrant for Putin" - Google News "International criminal court issues arrest warrant for Putin" - Google News | 59m | |
|
|
|
 | Energy Support Schemes Drive UK Government Borrowing to February Record |
| The cost of the UK government's energy support scheme caused public sector borrowing to soar to a record... |
 The Epoch Times | The Epoch Times The Epoch Times | The Epoch Times | 1h | |
|
|
|
 | Trump Says Key Witness 'Told the Truth' and Left 'Great' Impression on Manhattan... |
| Former President Donald Trump said that his former attorney, Michael Cohen, isn't a credible witness... |
 The Epoch Times | The Epoch Times The Epoch Times | The Epoch Times | 1h | |
|
|
|
 | No Confidence Vote on Tory's Foreign Interference Motion to Have Telford Testify,... |
| A Conservative Party motion that seeks to order Prime Minister Justin Trudeau's top adviser to testify... |
 The Epoch Times | The Epoch Times The Epoch Times | The Epoch Times | 1h | |
|
|
|
 | Teacher Shot by 6-Year-Old Describes Challenging Recovery |
| RICHMOND, Va.—A Virginia teacher who was shot and wounded by her 6-year-old student said she has had... |
 The Epoch Times | The Epoch Times The Epoch Times | The Epoch Times | 1h | |
|
|
|
 | LIVE NOW: NTD News Today (March 21): Dr. Fauci Confronted by Man While Promoting... |
| Former Assistant District Attorney Marc Ruskin weighs in on the possible indictment of former President... |
 The Epoch Times | The Epoch Times The Epoch Times | The Epoch Times | 1h | |
|
|
|
 | Glitzy Positano: Not Just a Pretty Facade |
| For most, Positano is simply the most romantic and chic stop on Italy's Amalfi Coast. South of Naples,... |
 The Epoch Times | The Epoch Times The Epoch Times | The Epoch Times | 1h | |
|
|
|
 | Shen Yun Moved Me to Tears, Says Brazilian Doctor to the Stars |
| SAO PAULO, Brazil—Dr. Francisco Sampaio, a doctor to stars like Rei Pelé who was named Athlete of the... |
 The Epoch Times | The Epoch Times The Epoch Times | The Epoch Times | 1h | |
|
|
|
 | Gargantuan Seaweed 'Island' Crossing Atlantic, Headed Toward Florida's Gulf Coast |
| While a toxic red tide algal bloom is invading Florida's beaches, a vast island of seaweed—spanning twice... |
 The Epoch Times | The Epoch Times The Epoch Times | The Epoch Times | 1h | |
|
|
|
| Ukraine news – live: Nato warns of signs Putin has asked China for lethal weapons... |
| Ukraine news – live: Nato warns of signs Putin has asked China for lethal weapons Yahoo News |
 "weapons for ukraine" - Google News "weapons for ukraine" - Google News | 1h | |
|
|
|
| US to send Ukraine USD 350 million in weapons, equipment as ... - ANI News |
| US to send Ukraine USD 350 million in weapons, equipment as ... ANI News |
 "weapons for ukraine" - Google News "weapons for ukraine" - Google News | 1h | |
|
|
|
| Yellen says bank situation 'stabilizing,' system is 'sound' |
| AP Washington correspondent Sagar Meghani reports on Bank Collapse-Yellen. |
 AP Audio Wire AP Audio Wire | 1h | |
|
|
|
| Army of lobbyists helped water down banking regulations |
| AP correspondent Jennifer King reports on Bank Collapse Lobbying. |
 AP Audio Wire AP Audio Wire | 1h | |
|
|
|
| Ukraine thanks US for new military aid as it announces ... - msnNOW |
| Ukraine thanks US for new military aid as it announces ... msnNOW |
 "kherson" - Google News "kherson" - Google News | 1h | |
|
|
|
| Smart Solar Power Market Size, Share, Global Outlook, Key Driver and Analysis by... |
| Smart Solar Power Market Size, Share, Global Outlook, Key Driver and Analysis by GE Energy, Calico Energy... |
 "intelligence assessments and analysis of the Russia - Ukraine War 2022" - Google News "intelligence assessments and analysis of the Russia - Ukraine War 2022" - Google News | 1h | |
|
|
|
 | |
| Mar. 20 Assessment Highlight: #Russia requested that the UN Security Council discuss #Israeli airstrikes... |
 ISW (Twitter) ISW (Twitter) | 1h | |
|
|
|
| |
| ISW retweeted: As #China catches up to US aeronautics, we must double... |
 ISW (Twitter) ISW (Twitter) | 1h | |
|
|
|
 | |
| #Russian sources accused unknown actors of planting a bomb that exploded near a gas pipeline in occupied... |
 ISW (Twitter) ISW (Twitter) | 1h | |
|
|
|
 | |
| Southern #Ukraine: #Russian sources claim that Russian forces are building up defensive fortifications... |
 ISW (Twitter) ISW (Twitter) | 1h | |
|
|
|
| Trump indictment would be unprecedented in US history - KCRA Sacramento |
| Trump indictment would be unprecedented in US history KCRA Sacramento |
 "Mar-a-Lago documents" - Google News "Mar-a-Lago documents" - Google News | 1h | |
|
|
|
| Japan PM expresses 'strong indignation' visiting Ukraine's Bucha: AFP - Kalkine Media |
| Japan PM expresses 'strong indignation' visiting Ukraine's Bucha: AFP Kalkine Media |
 "Bucha" - Google News "Bucha" - Google News | 1h | |
|
|
|
| Japan PM Expresses 'Strong Indignation' Visiting Ukraine's Bucha - Barron's |
| Japan PM Expresses 'Strong Indignation' Visiting Ukraine's Bucha Barron's |
 "Bucha" - Google News "Bucha" - Google News | 1h | |
|
|
|
| Live: Japan's PM Kishida pays respects at Bucha in surprise Ukraine visit - FRANCE... |
| Live: Japan's PM Kishida pays respects at Bucha in surprise Ukraine visit FRANCE 24 English |
 "Bucha" - Google News "Bucha" - Google News | 1h | |
|
|
|
| Putin asks China for 'lethal weapons' which is 'being considered in ... - London... |
| Putin asks China for 'lethal weapons' which is 'being considered in ... London Loves Business |
 "Putin in Beijing" - Google News "Putin in Beijing" - Google News | 1h | |
|
|
|
| |
| Two years after a fire devastated Paul Newman's Hole in the Wall Gang camp for seriously ill children,... |
 The Associated Press (Twitter) The Associated Press (Twitter) | 1h | |
|
|
|
 | |
| Gwyneth Paltrow is scheduled to stand trial on Tuesday in a lawsuit filed by a retired optometrist claiming... |
 The Associated Press (Twitter) The Associated Press (Twitter) | 1h | |
|
|
|
| |
| A Virginia teacher who was shot and wounded by her 6-year-old student said she has vivid memories and... |
 The Associated Press (Twitter) The Associated Press (Twitter) | 1h | |
|
|
|
| McCarthy again slams Manhattan DA in defense of Trump - ABC News |
| McCarthy again slams Manhattan DA in defense of Trump ABC News |
 trump - Google News trump - Google News | 1h | |
|
|
|
| Porn star Stormy Daniels says she'll 'dance down the street' if Trump goes to jail... |
| Porn star Stormy Daniels says she'll 'dance down the street' if Trump goes to jail CNBC |
 trump - Google News trump - Google News | 1h | |
|
|
|
| New Trump Accountants Are Withholding Records, New York AG Says - Bloomberg |
| New Trump Accountants Are Withholding Records, New York AG Says Bloomberg |
 trump - Google News trump - Google News | 1h | |
|
|
|
| Crafty Prankster Sneaks Unfiltered Truth About Trump Onto Right-Wing Newscast - Yahoo... |
| Crafty Prankster Sneaks Unfiltered Truth About Trump Onto Right-Wing Newscast Yahoo News |
 trump - Google News trump - Google News | 1h | |
|
|
|
| US announces sanctions on Iran drone procurement network |
| |
 All Stories All Stories | 1h | |
|
|
|
| 'Succession' star Sarah Snook pregnant with 1st child |
| |
 All Stories All Stories | 1h | |
|
|
|
| Video shows Irvo Otieno pinned to floor before his death |
| |
 All Stories All Stories | 1h | |
|
|
|
| Defense budget speeds toward $1 trillion, with China in mind - The Associated Press |
| Defense budget speeds toward $1 trillion, with China in mind The Associated Press |
 "Air Superiority Over Ukraine" - Google News "Air Superiority Over Ukraine" - Google News | 1h | |
|
|
|
| City of Odessa Parks and Recreation to host 'Take Me Fishing' event - NewsWest9.com |
| City of Odessa Parks and Recreation to host 'Take Me Fishing' event NewsWest9.com |
 "Odessa" - Google News "Odessa" - Google News | 1h | |
|
|
|
| Putin, Xi Begin Formal Talks, China's Proposal On Ukraine War On Agenda - Radio Free... |
| Putin, Xi Begin Formal Talks, China's Proposal On Ukraine War On Agenda Radio Free Europe / Radio Liberty |
 "russia-ukraine war" - Google News "russia-ukraine war" - Google News | 1h | |
|
|
|
| Putin-Xi Jinping, a friendship of convenience? Experts share their ... - Economic... |
| Putin-Xi Jinping, a friendship of convenience? Experts share their ... Economic Times |
 "Putin and Xi Jinping" - Google News "Putin and Xi Jinping" - Google News | 1h | |
|
|
|
| Владимир Путин и Си Цзиньпин обменялись статьями - КузПресс |
| Владимир Путин и Си Цзиньпин обменялись статьями КузПресс |
 "русско украинские мирные переговоры" - Google Новости "русско украинские мирные переговоры" - Google Новости | 1h | |
|
|
|
| Владимир Путин и Си Цзиньпин обменялись статьями - КузПресс |
| Владимир Путин и Си Цзиньпин обменялись статьями КузПресс |
 "русско украинские мирные переговоры" - Google Новости "русско украинские мирные переговоры" - Google Новости | 1h | |
|
|
|
| Zelensky holds Supreme CinC Staff meeting to discuss arms supplies, protection against... |
| Zelensky holds Supreme CinC Staff meeting to discuss arms supplies, protection against information leakage Ukrinform |
 "zelensky" - Google News "zelensky" - Google News | 1h | |
|
|
|
| Zelensky sacks commander of Ukraine's joint forces - Yahoo News |
| Zelensky sacks commander of Ukraine's joint forces Yahoo News |
 "zelensky" - Google News "zelensky" - Google News | 1h | |
|
|
|
 | Boris Johnson's Partygate Defence Dossier Says He Did Not 'Intentionally Mislead'... |
| A dossier presented by former Prime Minister Boris Johnson to the House of Commons Committee of Privileges... |
 The Epoch Times | The Epoch Times The Epoch Times | The Epoch Times | 1h | |
|
|
|
 | China Purges Top Executives in Finance, Nuclear, Petrochemicals, Real Estate, and... |
| With China's Communist Party leader Xi Jinping now in his third term, his anti-graft probes are continuing—with millions... |
 The Epoch Times | The Epoch Times The Epoch Times | The Epoch Times | 1h | |
|
|
|
 | Tech Layoffs in 2023 Near 150,000 Mark as Amazon, Facebook Shed Thousands More Employees |
| The technology industry is continuing to lay off thousands of employees, and is approaching 150,000 employees... |
 The Epoch Times | The Epoch Times The Epoch Times | The Epoch Times | 1h | |
|
|
|
 | Massive Fire Destroys New Jersey Church |
| A major fire burned a large church in Burlington, New Jersey to the ground on Monday, its roof collapsing... |
 The Epoch Times | The Epoch Times The Epoch Times | The Epoch Times | 1h | |
|
|
|
 | New Show 'Mysteries of Life' Explores the Big Questions of Human Existence |
| What happens when we die? A new show by NTD Television sets out to explore answers to this question,... |
 The Epoch Times | The Epoch Times The Epoch Times | The Epoch Times | 1h | |
|
|
|
 | Brian Giesbrecht: Bishop Grandin Played an Honourable Part in Manitoba's History... |
| Commentary Winnipeg is close to saying goodbye to Bishop Grandin. Soon, the streets, and anything else... |
 The Epoch Times | The Epoch Times The Epoch Times | The Epoch Times | 1h | |
|
|
|
 | Readers Inspired to Be Best Versions of Themselves by 'How Humankind Came To Be' |
| Readers said that Falun Gong founder Mr. Li Hongzhi's article "How Humankind Came To Be" inspired them... |
 The Epoch Times | The Epoch Times The Epoch Times | The Epoch Times | 1h | |
|
|
|
 | New York Trump Supporters Say Indictment a 'Politicized Prosecution' During Protest |
| The possible impending indictment of former President Donald Trump is a "politicized prosecution," according... |
 The Epoch Times | The Epoch Times The Epoch Times | The Epoch Times | 1h | |
|
|
|
 | Earthing Might Have Therapeutic Effect on COVID-19, 2 Simple Ways to Do It |
| The term "earthing" refers to making direct contact between the human body and the Earth, allowing the... |
 The Epoch Times | The Epoch Times The Epoch Times | The Epoch Times | 1h | |
|
|
|
 | Judge OKs Lawsuits Against JPMorgan, Deutsche Bank for Epstein Connections |
| JPMorgan Chase & Co. and Deutsche Bank will face lawsuits over claims they enabled disgraced financier... |
 The Epoch Times | The Epoch Times The Epoch Times | The Epoch Times | 1h | |
|
|
|
| Spinal Imaging Global Market Report 2023 - GlobeNewswire |
| Spinal Imaging Global Market Report 2023 GlobeNewswire |
 "Intelligence Assessments of Russia Ukraine War 2022" - Google News "Intelligence Assessments of Russia Ukraine War 2022" - Google News | 1h | |
|
|
|
| Revenue Cycle Management (RCM) Global Market Report 2023 - GlobeNewswire |
| Revenue Cycle Management (RCM) Global Market Report 2023 GlobeNewswire |
 "Intelligence Assessments of Russia Ukraine War 2022" - Google News "Intelligence Assessments of Russia Ukraine War 2022" - Google News | 1h | |
|
|
|
| Russia Is Expected To Free Violent Offenders Who Fought In Ukraine, UK Claims - Yahoo... |
| Russia Is Expected To Free Violent Offenders Who Fought In Ukraine, UK Claims Yahoo Eurosport UK |
 "Intelligence Assessments of Russia Ukraine War 2022" - Google News "Intelligence Assessments of Russia Ukraine War 2022" - Google News | 1h | |
|
|
|
| Credit crisis surges to top of investors' list of worries |
| Bank of America fund manager survey shows inflation is no longer seen as biggest risk to markets |
 Markets and Business News Review Markets and Business News Review | 1h | |
|
|
|
| The Fed is likely to hike rates by a quarter point but it must also reassure it can... |
| The Fed is likely to hike rates by a quarter point but it must also reassure it can contain a banking... |
 Markets and Business News Review Markets and Business News Review | 1h | |
|
|
|
| Trafigura chief says LME nickel contract is 'not fit for purpose' |
| Jeremy Weir says sector needs 'contracts to reflect the underlying business' |
 Markets and Business News Review Markets and Business News Review | 1h | |
|
|
|
| Credit Suisse Sets a Frightening Precedent for $250 Billion in Bonds - Barron's |
| Credit Suisse Sets a Frightening Precedent for $250 Billion in Bonds Barron'sGreek shipping still coming... |
 Markets and Business News Review Markets and Business News Review | 1h | |
|
|
|
 | Trump 2024 Campaign: More Professional and Disciplined? |
| Former President Donald Trump's 2024 presidential campaign is more professional and disciplined than... |
 19FortyFive 19FortyFive | 1h | |
|
|
|
 | US home sales surged in February as mortgage rates dipped |
| LOS ANGELES (AP) — Sales of previously occupied U.S. homes surged in February to the fastest pace in... |
 Associated Press News: Breaking News | Latest News Today Associated Press News: Breaking News | Latest News Today | 1h | |
|
|
|
| Louisville or London? U.S. Beyoncé fans share why they're opting for European... |
| Louisville or London? U.S. Beyoncé fans share why they're opting for European tickets AOL |
 "Crimean Bridge explosion" - Google News "Crimean Bridge explosion" - Google News | 1h | |
|
|
|
| Ukraine says an explosion destroyed some Russian missiles in ... - Ruetir |
| Ukraine says an explosion destroyed some Russian missiles in ... Ruetir |
 "Crimean Bridge explosion" - Google News "Crimean Bridge explosion" - Google News | 1h | |
|
|
|
| Ukrainian attack 'destroys Russian cruise missiles' in Crimea - Daily Mail |
| Ukrainian attack 'destroys Russian cruise missiles' in Crimea Daily Mail |
 "Crimean Bridge explosion" - Google News "Crimean Bridge explosion" - Google News | 1h | |
|
|
|
| Deadly fungal infection spreading at an alarming rate, CDC says - AOL |
| Deadly fungal infection spreading at an alarming rate, CDC says AOL |
 "Crimean Bridge explosion" - Google News "Crimean Bridge explosion" - Google News | 1h | |
|
|
|
| Lantern Pharma Reports Fourth Quarter and Fiscal Year 2022 ... - StreetInsider.com |
| Lantern Pharma Reports Fourth Quarter and Fiscal Year 2022 ... StreetInsider.com |
 "Millions of NYC Rats Could Be Carrying COVID-19" - Google News "Millions of NYC Rats Could Be Carrying COVID-19" - Google News | 1h | |
|
|
|
| Xi, Putin begin summit talks in Moscow | NHK WORLD-JAPAN News - NHK WORLD |
| Xi, Putin begin summit talks in Moscow | NHK WORLD-JAPAN News NHK WORLD |
 "Putin and Xi" - Google News "Putin and Xi" - Google News | 1h | |
|
|
|
| Xi doubles down on China's support for Putin - Yahoo! Voices |
| Xi doubles down on China's support for Putin Yahoo! Voices |
 "Putin and Xi" - Google News "Putin and Xi" - Google News | 1h | |
|
|
|
| Chinese President Xi to meet with Russia's Vladimir Putin - WOAI |
| Chinese President Xi to meet with Russia's Vladimir Putin WOAI |
 "Putin and Xi" - Google News "Putin and Xi" - Google News | 1h | |
|
|
|
| Russian President Vladimir Putin Meets with Wang Yi - MFA China |
| Russian President Vladimir Putin Meets with Wang Yi MFA China |
 "Putin and Xi" - Google News "Putin and Xi" - Google News | 1h | |
|
|
|
| Where Did COVID-19 Really Originate? Biden Signs Bill To Declassify Origins Information... |
| Where Did COVID-19 Really Originate? Biden Signs Bill To Declassify Origins Information Yahoo Finance |
 "COVID" - Google News "COVID" - Google News | 1h | |
|
|
|
| Biden signs bill that directs declassification of COVID-19 origins - TODAY |
| Biden signs bill that directs declassification of COVID-19 origins TODAY |
 "COVID" - Google News "COVID" - Google News | 1h | |
|
|
|
 | Van Zweden to end NY Philharmonic tenure with Mahler's 2nd |
| NEW YORK (AP) — Jaap van Zweden will conduct Mahler's Second Symphony in his farewell concerts as the... |
 Associated Press News: Breaking News | Latest News Today Associated Press News: Breaking News | Latest News Today | 1h | |
|
|
|
 | Notable legal clouds that continue to hang over Donald Trump in 2023 |
| It's been nearly eight years since he rode down the escalator in Trump Tower and more than two years... |
 CNN.com - Top Stories CNN.com - Top Stories | 1h | |
|
|
|
 | Trump's Republican allies in the House are doing what the former president taught... |
| Donald Trump's Republican allies in the House are doing what the former president taught them to do --... |
 CNN.com - Top Stories CNN.com - Top Stories | 1h | |
|
|
|
 | Opinion: Trump's risky call for protests |
| Former President Donald Trump knows his base better than anyone. He should understand that his words... |
 CNN.com - Top Stories CNN.com - Top Stories | 1h | |
|
|
|
 | Analysis: House Republicans have not received the memo on Trump |
| Amid all the other uncertainties surrounding the possible indictment of Donald Trump, the flurry of events... |
 CNN.com - Top Stories CNN.com - Top Stories | 1h | |
|
|
|
 | He was the assistant DA in Manhattan. Hear how likely he thinks a Trump arrest is |
| As New York and Washington DC prepare for a possible indictment of former President Donald Trump for... |
 CNN.com - Top Stories CNN.com - Top Stories | 1h | |
|
|
|
 | Video shows man's final moment before his death at a mental health facility |
| • Live updates: Video released of man's death at Virginia mental health facility |
 CNN.com - Top Stories CNN.com - Top Stories | 1h | |
|
|
|
| Zelensky defiant on anniversary of Russian invasion as war in Ukraine reaches 1-year... |
| Zelensky defiant on anniversary of Russian invasion as war in Ukraine reaches 1-year anniversary The... |
 "Zelensky" - Google News "Zelensky" - Google News | 1h | |
|
|
|
| The Gulag Legacy. Memory of Stalinism in Today's Russia – Nikolai ... - The Moscow... |
| The Gulag Legacy. Memory of Stalinism in Today's Russia – Nikolai ... The Moscow Times |
 "Will Russia turn to the West?" - Google News "Will Russia turn to the West?" - Google News | 1h | |
|
|
|
| China doesn't want Russia to 'go down in flames,' US official says - Business Insider |
| China doesn't want Russia to 'go down in flames,' US official says Business Insider |
 "Will Russia turn to the West?" - Google News "Will Russia turn to the West?" - Google News | 1h | |
|
|
|
| Cyber security in the boardroom — Financier Worldwide - Financier Worldwide |
| Cyber security in the boardroom — Financier Worldwide Financier Worldwide |
 "global threats to U.S. security" - Google News "global threats to U.S. security" - Google News | 1h | |
|
|
|
| Oleria Scores $8M Seed Funding for ID Authentication Technology - SecurityWeek |
| Oleria Scores $8M Seed Funding for ID Authentication Technology SecurityWeek |
 "global threats to U.S. security" - Google News "global threats to U.S. security" - Google News | 1h | |
|
|
|
| Lexmark Named a Leader in Security Solutions and Services ... - PR Newswire |
| Lexmark Named a Leader in Security Solutions and Services ... PR Newswire |
 "global threats to U.S. security" - Google News "global threats to U.S. security" - Google News | 1h | |
|
|
|
| Schuman Security and Defence Forum: Press remarks by High ... - EEAS |
| Schuman Security and Defence Forum: Press remarks by High ... EEAS |
 "global threats to U.S. security 2023" - Google News "global threats to U.S. security 2023" - Google News | 1h | |
|
|
|
| Biden weighs TikTok ban as CEO Shou Zi Chew prepares to testify before Congress -... |
| Biden weighs TikTok ban as CEO Shou Zi Chew prepares to testify before Congress Vox.com |
 "global threats to U.S. security 2023" - Google News "global threats to U.S. security 2023" - Google News | 1h | |
|
|
|
| Uprooted from Ukraine, promising tennis player finds her footing on … – New Hampshire... |
| Uprooted from Ukraine, promising tennis player finds her footing on … New Hampshire Public Radio The... |
 Russia - Ukraine War | The Russia News Russia - Ukraine War | The Russia News | 1h | |
|
|
|
| Japan PM Kishida Arrives In Kyiv: Japanese Media – Barron's |
| Japan PM Kishida Arrives In Kyiv: Japanese Media Barron's The post Japan PM Kishida Arrives In Kyiv:... |
 Russia - Ukraine War | The Russia News Russia - Ukraine War | The Russia News | 1h | |
|
|
|
| Ukrainian soldiers outside Kyiv destress with horse therapy – Euronews |
| Ukrainian soldiers outside Kyiv destress with horse therapy Euronews The post Ukrainian soldiers outside... |
 Russia - Ukraine War | The Russia News Russia - Ukraine War | The Russia News | 1h | |
|
|
|
| Ukraine news: Japan PM visits Kyiv – CTV News |
| Ukraine news: Japan PM visits Kyiv CTV News The post Ukraine news: Japan PM visits Kyiv – CTV News... |
 Russia - Ukraine War | The Russia News Russia - Ukraine War | The Russia News | 1h | |
|
|
|
| Russian missiles destroyed in Crimea, would have been used to devastate Ukraine cities:... |
| Russian missiles destroyed in Crimea, would have been used to devastate Ukraine cities: Japan's leader... |
 Russia - Ukraine War | The Russia News Russia - Ukraine War | The Russia News | 1h | |
|
|
|
| Ocean Energy Market Size 2023 Share, Key Trends and SWOT Analysis by Top Key Players... |
| Ocean Energy Market Size 2023 Share, Key Trends and SWOT Analysis by Top Key Players – Albatern Ltd.... |
 Russia - Ukraine War | The Russia News Russia - Ukraine War | The Russia News | 1h | |
|
|
|
 | Xi Putin meeting: What to expect from China-Russia talks - BBC |
| BBC |
 "russia-ukraine war 2022" - Google News "russia-ukraine war 2022" - Google News | 1h | |
|
|
|
| Putin has made a surprise visit to the occupied city of Mariupol in Ukraine - Utah... |
| Putin has made a surprise visit to the occupied city of Mariupol in Ukraine Utah Public Radio |
 "russia-ukraine war 2022" - Google News "russia-ukraine war 2022" - Google News | 1h | |
|
|
|
| Interview: 7 Questions for Pabllo Vittar - Metro Weekly |
| Interview: 7 Questions for Pabllo Vittar Metro Weekly |
 "project raven" - Google News "project raven" - Google News | 1h | |
|
|
|
| Apex Legends Adds Third Studio To Help Develop The Shooter's ... - MMOBomb |
| Apex Legends Adds Third Studio To Help Develop The Shooter's ... MMOBomb |
 "project raven" - Google News "project raven" - Google News | 1h | |
|
|
|
| Uprooted from Ukraine, promising tennis player finds her footing on ... - New Hampshire... |
| Uprooted from Ukraine, promising tennis player finds her footing on ... New Hampshire Public Radio |
 "Ukraine" - Google News "Ukraine" - Google News | 1h | |
|
|
|
 | Analysis: How Trump will use any indictment to fire up his 2024 campaign |
| 2023-03-21T15:15:11ZSupporters of former U.S. President Donald Trump attend a gathering outside his Mar-a-Lago... |
 Reuters Reuters | 1h | |
|
|
|
 | London police institutionally racist and sexist, report finds |
| 2023-03-21T14:57:24ZBritain's biggest police force is institutionally racist, misogynistic and homophobic... |
 Reuters Reuters | 1h | |
|
|
|
 | US House committee threatens to subpoena State Dept over Afghan documents |
| 2023-03-21T14:58:12ZU.S. Representative Michael McCaul (R-TX) participates in a Republican-led forum... |
 Reuters Reuters | 1h | |
|
|
|
 | Kremlin says Putin and Xi discussed Chinese peace proposal |
| 2023-03-21T10:10:38ZRussian President Vladimir Putin and Chinese President Xi Jinping attend a meeting... |
 Reuters Reuters | 1h | |
|
|
|
 | Stunned bank stocks make gains as Fed comes into focus |
| 2023-03-21T15:15:22ZInvestors crept cautiously into bank stocks on Tuesday, with share prices including... |
 Reuters Reuters | 1h | |
|
|
|
| Russian missiles destroyed in Crimea, would have been used to devastate Ukraine cities:... |
| Russian missiles destroyed in Crimea, would have been used to devastate Ukraine cities: Japan's leader... |
 "kyiv" - Google News "kyiv" - Google News | 1h | |
|
|
|
| Ukraine news: Japan PM visits Kyiv - CTV News |
| Ukraine news: Japan PM visits Kyiv CTV News |
 "kyiv" - Google News "kyiv" - Google News | 1h | |
|
|
|
| Japan PM Kishida Arrives In Kyiv: Japanese Media - Barron's |
| Japan PM Kishida Arrives In Kyiv: Japanese Media Barron's |
 "kyiv" - Google News "kyiv" - Google News | 1h | |
|
|
|
| Ukrainian soldiers outside Kyiv destress with horse therapy - Euronews |
| Ukrainian soldiers outside Kyiv destress with horse therapy Euronews |
 "kyiv" - Google News "kyiv" - Google News | 1h | |
|
|
|
 | These educators help students spot misinformation. #shorts |
| The Associated Press is the essential global news network, delivering fast, unbiased news from every... |
 Associated Press Associated Press | 1h | |
|
|
|
| Wartime Reconstruction—Building Barriers Against Corruption Risks - Government Accountability... |
| Wartime Reconstruction—Building Barriers Against Corruption Risks Government Accountability Office |
 "russia - ukraine war 2022" - Google News "russia - ukraine war 2022" - Google News | 1h | |
|
|
|
| India's Russia exports in Feb up 25% to hit pre-Ukraine war level - Mint |
| India's Russia exports in Feb up 25% to hit pre-Ukraine war level Mint |
 "russia - ukraine war 2022" - Google News "russia - ukraine war 2022" - Google News | 1h | |
|
|
|
| Ukraine, Russia extend grain deal - CP24 |
| Ukraine, Russia extend grain deal CP24 |
 "russia - ukraine war 2022" - Google News "russia - ukraine war 2022" - Google News | 1h | |
|
|
|
| Communications minister unveils plan to close TV regulator, nix license requirement... |
| Communications minister unveils plan to close TV regulator, nix license requirement The Times of Israel |
 "Putin seeks foreign volunteers" - Google News "Putin seeks foreign volunteers" - Google News | 1h | |
|
|
|
| Работа ПВО, сбито не менее 5 беспилотников: что известно о взрывах в Кременчуге на... |
| Работа ПВО, сбито не менее 5 беспилотников: что известно о взрывах в Кременчуге на Полтавщине Факты... |
 "Kremenchuk - Кременчуг" - Google Новости "Kremenchuk - Кременчуг" - Google Новости | 1h | |
|
|
|
| Xi and Putin discuss Beijing's 'peace proposal' for Ukraine - TVP World |
| Xi and Putin discuss Beijing's 'peace proposal' for Ukraine TVP World |
 "Putin in Beijing" - Google News "Putin in Beijing" - Google News | 1h | |
|
|
|
| 'This is what awaits all traitors' – Ukrainian intel on death of Kherson collaborator... |
| 'This is what awaits all traitors' – Ukrainian intel on death of Kherson collaborator Yahoo News |
 "kherson" - Google News "kherson" - Google News | 1h | |
|
|
|
| Russia Flies Bomber Planes Near Japan As Its PM Visits Ukraine - NDTV |
| Russia Flies Bomber Planes Near Japan As Its PM Visits Ukraine NDTV |
 "weapons for ukraine" - Google News "weapons for ukraine" - Google News | 1h | |
|
|
|
| Putin begs Xi to send Russia lethal weapons in Ukraine during Moscow talks – NATO... |
| Putin begs Xi to send Russia lethal weapons in Ukraine during Moscow talks – NATO chief Express |
 "weapons for ukraine" - Google News "weapons for ukraine" - Google News | 1h | |
|
|
|
| Ocean Energy Market Size 2023 Share, Key Trends and SWOT Analysis by Top Key Players... |
| Ocean Energy Market Size 2023 Share, Key Trends and SWOT Analysis by Top Key Players - Albatern Ltd.... |
 "intelligence assessments and analysis of the Russia - Ukraine War 2022" - Google News "intelligence assessments and analysis of the Russia - Ukraine War 2022" - Google News | 1h | |
|
|
|
| Ukraine war - latest: Putin and Xi to make statements today - as ... - Sky News |
| Ukraine war - latest: Putin and Xi to make statements today - as ... Sky News |
 "Russians halt their offensive in Ukraine" - Google News "Russians halt their offensive in Ukraine" - Google News | 1h | |
|
|
|
| 'I really feel great anger': Japan PM visits Ukraine's Bucha massacre site - Better... |
| 'I really feel great anger': Japan PM visits Ukraine's Bucha massacre site Better Life |
 "Bucha" - Google News "Bucha" - Google News | 1h | |
|
|
|
| In Ukraine to offer solidarity, Japan's Kishida tours Bucha massacre site - CNA |
| In Ukraine to offer solidarity, Japan's Kishida tours Bucha massacre site CNA |
 "Bucha" - Google News "Bucha" - Google News | 1h | |
|
|
|
| Japan PM Kishida visits Bucha as part of Ukraine visit: AFP - Kalkine Media |
| Japan PM Kishida visits Bucha as part of Ukraine visit: AFP Kalkine Media |
 "Bucha" - Google News "Bucha" - Google News | 1h | |
|
|
|
| Japan PM Kishida arrives in Kyiv for talks with Zelenskiy - Financial Post |
| Japan PM Kishida arrives in Kyiv for talks with Zelenskiy Financial Post |
 "Bucha" - Google News "Bucha" - Google News | 1h | |
|
|
|
| International Criminal Court issues arrest warrant for Putin over ... - St. Louis... |
| International Criminal Court issues arrest warrant for Putin over ... St. Louis Post-Dispatch |
 "Bucha" - Google News "Bucha" - Google News | 1h | |
|
|
|
| Russian attacks against civilians in Ukraine amount to war crimes ... - The Daily... |
| Russian attacks against civilians in Ukraine amount to war crimes ... The Daily Progress |
 "Bucha" - Google News "Bucha" - Google News | 1h | |
|
|
|
| |
| The Ringling Bros. and Barnum & Bailey circus is back, without the animals. Here's a look at how... |
 The Associated Press (Twitter) The Associated Press (Twitter) | 1h | |
|
|
|
 | |
| A few ways to spot misinformation online: 1. Double-check sources 2. Diversify newsfeeds 3. Employ... |
 The Associated Press (Twitter) The Associated Press (Twitter) | 1h | |
|
|
|
| |
| Geolocated footage posted on March 19 additionally indicates that #Russian forces have advanced near... |
 ISW (Twitter) ISW (Twitter) | 1h | |
|
|
|
| |
| Geolocated footage posted on March 20 also indicates that #Wagner forces have made advances near the... |
 ISW (Twitter) ISW (Twitter) | 1h | |
|
|
|
| |
| #Donetsk Oblast: Geolocated footage posted on Mar. 19 shows that #Russian forces have advanced in... |
 ISW (Twitter) ISW (Twitter) | 1h | |
|
|
|
| |
| ISW retweeted: Thank you @michael_wasiura for letting me share some of... |
 ISW (Twitter) ISW (Twitter) | 1h | |
|
|
|
 | |
| ISW retweeted: 6. We expanded Russian claims northward in the direction... |
 ISW (Twitter) ISW (Twitter) | 1h | |
|
|
|
 | |
| ISW retweeted: 5. We expanded Russian claims over Kamianka, Donetsk Oblast,... |
 ISW (Twitter) ISW (Twitter) | 1h | |
|
|
|
 | |
| ISW retweeted: 4. We expanded Russian claims slightly westward to the... |
 ISW (Twitter) ISW (Twitter) | 1h | |
|
|
|
 | |
| ISW retweeted: 3. We expanded Russian claims westward, over the T-0513... |
 ISW (Twitter) ISW (Twitter) | 1h | |
|
|
|
 | |
| ISW retweeted: 2. We expanded Russian claims further east to the western... |
 ISW (Twitter) ISW (Twitter) | 1h | |
|
|
|
 | |
| ISW retweeted: 1. We expanded assessed Russian advances northward in the... |
 ISW (Twitter) ISW (Twitter) | 1h | |
|
|
|
| |
| ISW retweeted: March 20 Ukraine Control of Terrain map update for @TheStudyofWar.... |
 ISW (Twitter) ISW (Twitter) | 1h | |
|
|
|
| |
| #Russian authorities are likely unsure of how to redefine #Wagner's new role following #Prigozhin's overextension... |
 ISW (Twitter) ISW (Twitter) | 1h | |
|
|
|
| |
| Mar. 20 Assessment Highlight: #Wagner Group financier Yevgeny #Prigozhin appears to maintain powerful... |
 ISW (Twitter) ISW (Twitter) | 1h | |
|
|
|
| Trump lawyer: If he's indicted 'this is an all-out war' - The Hill |
| Trump lawyer: If he's indicted 'this is an all-out war' The Hill |
 trump - Google News trump - Google News | 1h | |
|
|
|
| DeSantis sees lowest level of support since December in new poll, trails Trump by... |
| DeSantis sees lowest level of support since December in new poll, trails Trump by 28 points The Hill |
 trump - Google News trump - Google News | 1h | |
|
|
|
| A major misconception about a potential Trump indictment in New York - MSNBC |
| A major misconception about a potential Trump indictment in New York MSNBC |
 trump - Google News trump - Google News | 1h | |
|
|
|
| Analysis: How Trump will use any indictment to fire up his 2024 campaign - Reuters.com |
| Analysis: How Trump will use any indictment to fire up his 2024 campaign Reuters.com |
 trump - Google News trump - Google News | 1h | |
|
|
|
| Trump arrest warning spikes shares in SPAC seeking to buy Truth Social - Axios |
| Trump arrest warning spikes shares in SPAC seeking to buy Truth Social Axios |
 trump - Google News trump - Google News | 1h | |
|
|
|
| What to know about Alvin Bragg, Manhattan district attorney - Spectrum News |
| What to know about Alvin Bragg, Manhattan district attorney Spectrum News |
 "Election 2016 Investigations" - Google News "Election 2016 Investigations" - Google News | 1h | |
|
|
|
| Learnings from the Ukraine battlefield for armed forces - msnNOW |
| Learnings from the Ukraine battlefield for armed forces msnNOW |
 "Air Superiority Over Ukraine" - Google News "Air Superiority Over Ukraine" - Google News | 1h | |
|
|
|
| Itching to start spring garden cleanup? Not so fast! |
| |
 All Stories All Stories | 1h | |
|
|
|
| Vladimir Putin's war chiefs in bitter spat as he begs China's Xi for ... - The Mirror |
| Vladimir Putin's war chiefs in bitter spat as he begs China's Xi for ... The Mirror |
 "shoigu" - Google News "shoigu" - Google News | 1h | |
|
|
|
| A veteran's lasting impact on his community and his country - KMID - Local 2 News |
| A veteran's lasting impact on his community and his country KMID - Local 2 News |
 "Odessa" - Google News "Odessa" - Google News | 1h | |
|
|
|
| Obituary | Odessa Coward Dixon of Wilmington, North Carolina - Andrews Mortuary &... |
| Obituary | Odessa Coward Dixon of Wilmington, North Carolina Andrews Mortuary & Crematory |
 "Odessa" - Google News "Odessa" - Google News | 1h | |
|
|
|
| Xi invites Putin to China for third Belt and Road Forum - Xinhua - The Business Standard |
| Xi invites Putin to China for third Belt and Road Forum - Xinhua The Business Standard |
 "ukraine neutrality" - Google News "ukraine neutrality" - Google News | 1h | |
|
|
|
| Boris Johnson says 'partygate' untruths were honest mistake |
| AP correspondent Charles de Ledesma reports on Britain Partygate. |
 AP Audio Wire AP Audio Wire | 1h | |
|
|
|
| Uyghurs demand Xi Jinping's arrest after international court issues warrant for Putin... |
| Uyghurs demand Xi Jinping's arrest after international court issues warrant for Putin Fox News |
 "Putin and Xi Jinping" - Google News "Putin and Xi Jinping" - Google News | 1h | |
|
|
|
| Опрос показал намерение каждого третьего школьника ... - Форпост-Севастополь - информационный... |
| Опрос показал намерение каждого третьего школьника ... Форпост-Севастополь - информационный портал Крыма |
 "русско украинские мирные переговоры" - Google Новости "русско украинские мирные переговоры" - Google Новости | 1h | |
|
|
|
| Idaho murders: State Senate passes bill to reinstate execution by firing squad -... |
| Idaho murders: State Senate passes bill to reinstate execution by firing squad Fox News |
 "Idaho murders" - Google News "Idaho murders" - Google News | 1h | |
|
|
|
| Russia and Ukraine extend grain deal despite disagreement - bbc.com |
| Russia and Ukraine extend grain deal despite disagreement bbc.com |
 "russia-ukraine war news" - Google News "russia-ukraine war news" - Google News | 1h | |
|
|
|
| Uvalde cops admit they were too scared of school shooter's AR-15 'battle rifle' -... |
| Uvalde cops admit they were too scared of school shooter's AR-15 'battle rifle' New York Post |
 "Uvalde" - Google News "Uvalde" - Google News | 1h | |
|
|
|
| Japan PM Fumio Kishida's Ukraine visit overshadows Xi-Putin talks - CNBCTV18 |
| Japan PM Fumio Kishida's Ukraine visit overshadows Xi-Putin talks CNBCTV18 |
 "Russia Ukraine peace talks" - Google News "Russia Ukraine peace talks" - Google News | 1h | |
|
|
|
| Xi's “peace” plan for Ukraine: China “wins” - GZERO Media |
| Xi's "peace" plan for Ukraine: China "wins" GZERO Media |
 "Russia Ukraine peace talks" - Google News "Russia Ukraine peace talks" - Google News | 1h | |
|
|
|
 | AP Headline News - Mar 21 2023 11:00 (EDT) |
| |
 Associated Press Bulletins Associated Press Bulletins | 1h | |
|
|
|
| Report to Congress on Transferring Fighter Aircraft to Ukraine ... - USNI News |
| Report to Congress on Transferring Fighter Aircraft to Ukraine ... USNI News |
 "Intelligence Assessments of Russia Ukraine War 2022" - Google News "Intelligence Assessments of Russia Ukraine War 2022" - Google News | 1h | |
|
|
|
| Revenue Cycle Management (RCM) Global Market Report 2023 - Yahoo Finance |
| Revenue Cycle Management (RCM) Global Market Report 2023 Yahoo Finance |
 "Intelligence Assessments of Russia Ukraine War 2022" - Google News "Intelligence Assessments of Russia Ukraine War 2022" - Google News | 1h | |
|
|
|
 | Oil Is On Sale And Buffett Is Buying, Should You? |
| It be a good bet to frontrun Joe Biden's stated intentions to refill the Strategic Petroleum Reserve. |
 Markets and Business News Review Markets and Business News Review | 1h | |
|
|
|
 | Superhero Films Just Don't Feel Essential Anymore |
| The times are changing, and superhero films are no longer a novelty. |
 Markets and Business News Review Markets and Business News Review | 1h | |
|
|
|
 | Yellen Testifies Banking Crisis 'Different From 2008'—But Fund Managers Worry... |
| "2008 was a solvency crisis… What we're seeing are contagious bank runs," Yellen testified before Congress... |
 Markets and Business News Review Markets and Business News Review | 1h | |
|
|
|
 | Amazon Begins Second Round Of Layoffs, But Wall Street Is Unimpressed |
| Amazon announces 9,000-strong layoff round for its corporate departments including cloud services and... |
 Markets and Business News Review Markets and Business News Review | 1h | |
|
|
|
 | What To Expect From Nike's Stock Post Q3 Results? |
| We expect Nike's stock to see little to no movement with revenues coming in line with the consensus estimates... |
 Markets and Business News Review Markets and Business News Review | 1h | |
|
|
|
 | Businesses Have A Growing Range Of Options For Waste Reduction |
| If an item has potential value for reuse, recycling or re-purposing it doesn't have to become waste. |
 Markets and Business News Review Markets and Business News Review | 1h | |
|
|
|
 | Crystal Palace Hiring Roy Hodgson Is Depressing And Short-Term |
| Premier League clubs who panic have a habit of making ultra-conservative choices, but this one beggars... |
 Markets and Business News Review Markets and Business News Review | 1h | |
|
|
|
 | Willy Loman, And When It Is Never Too Late In The Job Market |
| Like Willy Loman, most workers find the job world less welcoming and colder as they age. For workers... |
 Markets and Business News Review Markets and Business News Review | 1h | |
|
|
|
 | 'Shadow And Bone' Season 3 And 'Six Of Crows' Spin-Off Depends On Season 2 |
| At least so far, Shadow and Bone season 2 is performing quite well on Netflix, unseating the second half... |
 Markets and Business News Review Markets and Business News Review | 1h | |
|
|
|
 | Adam Duvall Brings His Power To The Boston Red Sox And The Green Monster |
| Right-handed hitting Adam Duvall has the type of power that is built to put more dents in the Fenway... |
 Markets and Business News Review Markets and Business News Review | 1h | |
|
|
|
| The Worst State for Doctors |
| According to a new study, Hawaii is the worst state for doctors. They face harsh competition and a difficult... |
 Markets and Business News Review Markets and Business News Review | 1h | |
|
|
|
 | Martina Navratilova says doctors told her she is cancer-free |
| LONDON (AP) — Martina Navratilova has been told by doctors that, "as far as they know, I'm cancer-free,"... |
 Associated Press News: Breaking News | Latest News Today Associated Press News: Breaking News | Latest News Today | 1h | |
|
|
|
 | New Ukraine Video Shows Russian Cruise Missile Shipment Attacked |
| Videos posted to the Telegram social media platform showed a series of blasts that reportedly targeted... |
 19FortyFive 19FortyFive | 1h | |
|
|
|
 | Donald Has a Problem: Could Face Racketeering Charges in Georgia |
| As everyone knows, former President Donald Trump is expected to be indicted this week on charges related... |
 19FortyFive 19FortyFive | 1h | |
|
|
|
 | Problem: Kamala Harris 'Seems To Be An Albatross' |
| Can Kamala Harris Bounce Back? – Vice President Kamala Harris will mount a vigorous campaign once President... |
 19FortyFive 19FortyFive | 1h | |
|
|
|
 | USS America: The Aircraft Carrier the U.S. Navy Tried and Failed to Sink |
| The intentional scuttling of the USS America proved that sinking a carrier is easier said than done.... |
 19FortyFive 19FortyFive | 1h | |
|
|
|
| Ukraine hints it blew up Russian missiles in occupied Crimea - NBC News |
| Ukraine hints it blew up Russian missiles in occupied Crimea NBC News |
 "Crimean Bridge explosion" - Google News "Crimean Bridge explosion" - Google News | 1h | |
|
|
|
| 9 Types of Ticks to Watch Out for This Year—and Which Ones Can ... - Bob Vila |
| 9 Types of Ticks to Watch Out for This Year—and Which Ones Can ... Bob Vila |
 "aggressive squirrels in new york city" - Google News "aggressive squirrels in new york city" - Google News | 1h | |
|
|
|
| Kremlin says Putin and Xi discussed Chinese peace proposal - Reuters.com |
| Kremlin says Putin and Xi discussed Chinese peace proposal Reuters.com |
 "Putin and Xi" - Google News "Putin and Xi" - Google News | 1h | |
|
|
|
| Ukraine war has made it easier for US to isolate China in the Pacific - CNN |
| Ukraine war has made it easier for US to isolate China in the Pacific CNN |
 "Putin and Xi" - Google News "Putin and Xi" - Google News | 1h | |
|
|
|
| 'Urgent threat': Study reports dramatic increase in highly contagious fungal infection... |
| 'Urgent threat': Study reports dramatic increase in highly contagious fungal infection Express |
 "Is Putin ill with blood cancer?" - Google News "Is Putin ill with blood cancer?" - Google News | 1h | |
|
|
|
| 'You're a street fighter,' Madigan confidant counseled former speaker ... - WGLT |
| 'You're a street fighter,' Madigan confidant counseled former speaker ... WGLT |
 "FBI AND ITS ROLE IN ELECTION 2016" - Google News "FBI AND ITS ROLE IN ELECTION 2016" - Google News | 1h | |
|
|
|
| Why We Shouldn't Expect the Russian Economy to Collapse ... - The Moscow Times |
| Why We Shouldn't Expect the Russian Economy to Collapse ... The Moscow Times |
 "Will Russia turn to the West?" - Google News "Will Russia turn to the West?" - Google News | 1h | |
|
|
|
 | Smoked Salmon in a Cozy Chowder Is Perfect on Cool, Rainy Days |
| Our love of smoked salmon knows no boundaries: We pile it onto toast for breakfast, flake it into mayonnaise... |
 The Epoch Times | The Epoch Times The Epoch Times | The Epoch Times | 1h | |
|
|
|
 | LIVE 4 PM ET: 'Superpower in Peril': A Conversation with David McCormick—An Event... |
| David H. McCormick, former CEO of Bridgewater Associates, discusses his new book 'Superpower in Peril:... |
 The Epoch Times | The Epoch Times The Epoch Times | The Epoch Times | 1h | |
|
|
|
 | A Third of Toronto Food-Bank Users Work Full-Time, Says Largest Food Bank |
| Canadians with full-time salaries are having trouble affording groceries, according to testimony before... |
 The Epoch Times | The Epoch Times The Epoch Times | The Epoch Times | 1h | |
|
|
|
| Americans taking fewer steps than they did pre-COVID - CBS Minnesota |
| Americans taking fewer steps than they did pre-COVID CBS Minnesota |
 "COVID" - Google News "COVID" - Google News | 1h | |
|
|
|
| FDA May Authorize Additional Covid-19 Booster Shots - WSJ - The Wall Street Journal |
| FDA May Authorize Additional Covid-19 Booster Shots - WSJ The Wall Street Journal |
 "COVID" - Google News "COVID" - Google News | 1h | |
|
|
|
| What is a raccoon dog and why is it being linked to COVID-19's origin? - Global News |
| What is a raccoon dog and why is it being linked to COVID-19's origin? Global News |
 "COVID" - Google News "COVID" - Google News | 1h | |
|
|
|
| Three years into COVID, how is Oklahoma stacking up in cases, deaths? - Oklahoman.com |
| Three years into COVID, how is Oklahoma stacking up in cases, deaths? Oklahoman.comIndia reports 699... |
 "COVID" - Google News "COVID" - Google News | 1h | |
|
|
|
| Parents confess to sending kids to school after COVID exposure - Insider |
| Parents confess to sending kids to school after COVID exposure Insider |
 "COVID" - Google News "COVID" - Google News | 1h | |
|
|
|
| US claims senior Russian officials gave order to bring down drone, vows to continue... |
| US claims senior Russian officials gave order to bring down drone, vows to continue flying drones over... |
 "US Intel: Putin gave orders to invade Ukraine" - Google News "US Intel: Putin gave orders to invade Ukraine" - Google News | 1h | |
|
|
|
| Here's what's coming to Netflix in March 2023 - Bakersfield Now |
| Here's what's coming to Netflix in March 2023 Bakersfield Now |
 "wanda vázquez" - Google News "wanda vázquez" - Google News | 1h | |
|
|
|
| News Analysis: UK Commits $3 Billion to Support National Quantum Strategy - SecurityWeek |
| News Analysis: UK Commits $3 Billion to Support National Quantum Strategy SecurityWeek |
 "global threats to U.S. security" - Google News "global threats to U.S. security" - Google News | 1h | |
|
|
|
| Ukraine war – latest updates: Putin makes surprise trip to Crimea as ... - msnNOW |
| Ukraine war – latest updates: Putin makes surprise trip to Crimea as ... msnNOW |
 "Gen. Gerasimov was wounded" - Google News "Gen. Gerasimov was wounded" - Google News | 1h | |
|
|
|
| Majority of NATO members still short of alliance's spending pledge - EURACTIV |
| Majority of NATO members still short of alliance's spending pledge EURACTIV |
 "Stoltenberg" - Google News "Stoltenberg" - Google News | 1h | |
|
|
|
| Seven out of 30 allies met NATO military spending target in 2022 - The Union Leader |
| Seven out of 30 allies met NATO military spending target in 2022 The Union Leader |
 "Stoltenberg" - Google News "Stoltenberg" - Google News | 1h | |
|
|
|
| U.S. Speeds Up Abrams Tank Delivery To Ukraine War Zone - Radio Free Europe / Radio... |
| U.S. Speeds Up Abrams Tank Delivery To Ukraine War Zone Radio Free Europe / Radio Liberty |
 "Stoltenberg" - Google News "Stoltenberg" - Google News | 1h | |
|
|
|
| Two new candidates preparing to join incumbent returning to ... - Chicago Tribune |
| Two new candidates preparing to join incumbent returning to ... Chicago Tribune |
 "Robb Elementary Uvalde" - Google News "Robb Elementary Uvalde" - Google News | 1h | |
|
|
|
| After Arlington shooting, how can Texas schools prevent crime outside their buildings?... |
| After Arlington shooting, how can Texas schools prevent crime outside their buildings? Yahoo News |
 "Robb Elementary Uvalde" - Google News "Robb Elementary Uvalde" - Google News | 1h | |
|
|
|
| Russia says US obsessed with idea of inflicting 'strategic defeat' on ... - Anadolu... |
| Russia says US obsessed with idea of inflicting 'strategic defeat' on ... Anadolu Agency |
 "U.S. and Russia" - Google News "U.S. and Russia" - Google News | 1h | |
|
|
|
| Why the Proposed Saudi Security Pact Doesn't Serve U.S. Interests - Foreign Policy |
| Why the Proposed Saudi Security Pact Doesn't Serve U.S. Interests Foreign Policy |
 "global threats to U.S. security 2023" - Google News "global threats to U.S. security 2023" - Google News | 1h | |
|
|
|
| North Korea launches missile into sea amid US-SKorea drills - The Associated Press |
| North Korea launches missile into sea amid US-SKorea drills The Associated Press |
 "global threats to U.S. security 2023" - Google News "global threats to U.S. security 2023" - Google News | 1h | |
|
|
|
| Ukraine Anticipates Lower 2023 Grain Harvest, Kansas Wheat … – Farm Policy News |
| Ukraine Anticipates Lower 2023 Grain Harvest, Kansas Wheat … Farm Policy News The post Ukraine Anticipates... |
 Russia - Ukraine War | The Russia News Russia - Ukraine War | The Russia News | 1h | |
|
|
|
| 'Inevitable' Ukraine Victory To Reshape Region: Georgia's Saakashvili – Barron's |
| 'Inevitable' Ukraine Victory To Reshape Region: Georgia's Saakashvili Barron's The post 'Inevitable'... |
 Russia - Ukraine War | The Russia News Russia - Ukraine War | The Russia News | 1h | |
|
|
|
| Is Death Spiral of Silicon Valley Bank an Omen for California? - gvwire.com |
| Is Death Spiral of Silicon Valley Bank an Omen for California? gvwire.com |
 "aggressive rats in new york city" - Google News "aggressive rats in new york city" - Google News | 1h | |
|
|
|
| Food Testing Kits Global Market Report 2023: Ukraine-Russia War - Yahoo Finance |
| Food Testing Kits Global Market Report 2023: Ukraine-Russia War Yahoo Finance |
 "russia-ukraine war 2022" - Google News "russia-ukraine war 2022" - Google News | 1h | |
|
|
|
| Kishida's surprise visit to Kiev driven by self-calculations seems ... - Global Times |
| Kishida's surprise visit to Kiev driven by self-calculations seems ... Global Times |
 "G7" - Google News "G7" - Google News | 1h | |
|
|
|
 | Yellen vows to safeguard U.S. bank deposits, may need more interventions |
| 2023-03-21T14:27:01ZU.S. Treasury Secretary Janet Yellen takes questions on the Biden administration's... |
 Reuters Reuters | 1h | |
|
|
|
| 'Inevitable' Ukraine Victory To Reshape Region: Georgia's Saakashvili - Barron's |
| 'Inevitable' Ukraine Victory To Reshape Region: Georgia's Saakashvili Barron's |
 "Ukraine" - Google News "Ukraine" - Google News | 1h | |
|
|
|
| Ukraine Anticipates Lower 2023 Grain Harvest, Kansas Wheat ... - Farm Policy News |
| Ukraine Anticipates Lower 2023 Grain Harvest, Kansas Wheat ... Farm Policy News |
 "Ukraine" - Google News "Ukraine" - Google News | 1h | |
|
|
|
 | Selected Articles Review at 11 a.m. [Inoreader digest] |
| ... |
 The News And Times The News And Times | 2h | |
|
|
|
| Putin and Xi Jinping Hold Further Talks Amid Western Criticism That Beijing is Providing... |
| Putin and Xi Jinping Hold Further Talks Amid Western Criticism That Beijing is Providing ... - Latest... |
 "Putin in Beijing" - Google News "Putin in Beijing" - Google News | 2h | |
|
|
|
| Chinese public not buying Beijing's rosy view of Xi-Putin meeting following arrest... |
| Chinese public not buying Beijing's rosy view of Xi-Putin meeting following arrest warrant Fox News |
 "Putin in Beijing" - Google News "Putin in Beijing" - Google News | 2h | |
|
|
|
 | When One Zombie Eats Another: Why UBS's Rescue of Credit Suisse Changes Nothing |
| Commentary What happens when one zombie eats another? All the disgusting and fetid zombie parts of the... |
 The Epoch Times | The Epoch Times The Epoch Times | The Epoch Times | 2h | |
|
|
|
 | Nadal out of Top 10 for 1st Time Since 2005 |
| Rafa Nadal's absence from Indian Wells saw the 22-time Grand Slam champion slip out of the top 10 for... |
 The Epoch Times | The Epoch Times The Epoch Times | The Epoch Times | 2h | |
|
|
|
 | New York DA Office Responds to Demands for Information About Trump Arrest |
| The Manhattan district attorney's office on Monday issued a response to House Republicans' demands to... |
 The Epoch Times | The Epoch Times The Epoch Times | The Epoch Times | 2h | |
|
|
|
| Kyiv amends 2023 budget to increase defense spending - TVP World |
| Kyiv amends 2023 budget to increase defense spending TVP World |
 "kyiv" - Google News "kyiv" - Google News | 2h | |
|
|
|
| Visa application centre in Kyiv, Ukraine has re-opened for limited ... - Freeths |
| Visa application centre in Kyiv, Ukraine has re-opened for limited ... Freeths |
 "kyiv" - Google News "kyiv" - Google News | 2h | |
|
|
|
| Japan Prime Minister Kishida Arrives in Kyiv - The Japan News |
| Japan Prime Minister Kishida Arrives in Kyiv The Japan News |
 "kyiv" - Google News "kyiv" - Google News | 2h | |
|
|
|
| Prime Minister Kishida to Pay a Surprise Visit to Kyiv, Ukraine - The Japan News |
| Prime Minister Kishida to Pay a Surprise Visit to Kyiv, Ukraine The Japan News |
 "kyiv" - Google News "kyiv" - Google News | 2h | |
|
|
|
| Ukraine Latest: Saudis Support Kyiv With $400 Million Aid Plan - BNN Bloomberg |
| Ukraine Latest: Saudis Support Kyiv With $400 Million Aid Plan BNN Bloomberg |
 "kyiv" - Google News "kyiv" - Google News | 2h | |
|
|
|
| The Hill's Morning Report — Possible Trump indictment ... - The Hill |
| The Hill's Morning Report — Possible Trump indictment ... The Hill |
 "National security adviser Jake Sullivan" - Google News "National security adviser Jake Sullivan" - Google News | 2h | |
|
|
|
| Japan's Prime Minister offers Ukraine support as China's Xi backs ... - Northwest... |
| Japan's Prime Minister offers Ukraine support as China's Xi backs ... Northwest Arkansas Democrat-Gazette |
 "Bucha" - Google News "Bucha" - Google News | 2h | |
|
|
|
| 'Outraged by the cruelty': Japan PM Kishida visits Bucha - Euronews |
| 'Outraged by the cruelty': Japan PM Kishida visits Bucha Euronews |
 "Bucha" - Google News "Bucha" - Google News | 2h | |
|
|
|
| International Criminal Court issues arrest warrant for Putin over ... - The Daily... |
| International Criminal Court issues arrest warrant for Putin over ... The Daily News |
 "Bucha" - Google News "Bucha" - Google News | 2h | |
|
|
|
| Don't let Ukraine become just another partisan divide - The Hill |
| Don't let Ukraine become just another partisan divide The Hill |
 "Russians halt their offensive in Ukraine" - Google News "Russians halt their offensive in Ukraine" - Google News | 2h | |
|
|
|
| Factbox: China's new line-up of top government leaders - Reuters |
| Factbox: China's new line-up of top government leaders Reuters |
 "covid -19 origins" - Google News "covid -19 origins" - Google News | 2h | |
|
|
|
| |
| The Associated Press retweeted: London's police chief says he's "upset,... |
 The Associated Press (Twitter) The Associated Press (Twitter) | 2h | |
|
|
|
 | |
| Keanu Reeves and Laurence Fishburne were among the "John Wick: Chapter 4" stars honoring Lance Reddick,... |
 The Associated Press (Twitter) The Associated Press (Twitter) | 2h | |
|
|
|
 | |
| The Associated Press retweeted: HAPPY TO BE A MEME - At the "Succession"season... |
 The Associated Press (Twitter) The Associated Press (Twitter) | 2h | |
|
|
|
| |
| A two-week strike by Paris garbage collectors is among the most visible signs of opposition to Emmanuel... |
 The Associated Press (Twitter) The Associated Press (Twitter) | 2h | |
|
|
|
 | |
| Eastern #Kharkiv/Western #Luhansk Oblast: #Russian sources claimed that #Ukrainian and Russian forces... |
 ISW (Twitter) ISW (Twitter) | 2h | |
|
|
|
| |
| ".@matthew_mcinnis, a senior fellow for @TheStudyofWar's #China program, explained that the desire to... |
 ISW (Twitter) ISW (Twitter) | 2h | |
|
|
|
| Manhattan DA issues scathing response to GOP letter on possible Trump indictment:... |
| Manhattan DA issues scathing response to GOP letter on possible Trump indictment: 'We will not be intimidated' Fox... |
 trump - Google News trump - Google News | 2h | |
|
|
|
| Trump Hits No. 1 With 'Justice For All' Song Made With Jan. 6 Arrestees - Forbes |
| Trump Hits No. 1 With 'Justice For All' Song Made With Jan. 6 Arrestees Forbes |
 trump - Google News trump - Google News | 2h | |
|
|
|
| Stormy Daniels Speaks Out About Possible Trump Indictment - Newsweek |
| Stormy Daniels Speaks Out About Possible Trump Indictment Newsweek |
 trump - Google News trump - Google News | 2h | |
|
|
|
| Trump's Stormy Weather Could Be DeSantis's Ray of Sunshine - Bloomberg |
| Trump's Stormy Weather Could Be DeSantis's Ray of Sunshine Bloomberg |
 trump - Google News trump - Google News | 2h | |
|
|
|
| The key reason the DOJ didn't prosecute Trump's hush money case - MSNBC |
| The key reason the DOJ didn't prosecute Trump's hush money case MSNBC |
 trump - Google News trump - Google News | 2h | |
|
|
|
| Stormy Daniels beefs up security over death threats in Trump case - New York Post |
| Stormy Daniels beefs up security over death threats in Trump case New York Post |
 trump - Google News trump - Google News | 2h | |
|
|
|
| Japan's PM offers Ukraine support as China's Xi backs Russia - Press Herald |
| Japan's PM offers Ukraine support as China's Xi backs Russia Press Herald |
 "russia-ukraine war" - Google News "russia-ukraine war" - Google News | 2h | |
|
|
|
 | A veteran's lasting impact on his community and his country - KMID - Local 2 News |
| KMID - Local 2 News |
 "Odessa" - Google News "Odessa" - Google News | 2h | |
|
|
|
| Humanity on 'thin ice' - The Daily Star |
| Humanity on 'thin ice' The Daily Star |
 "ukraine neutrality" - Google News "ukraine neutrality" - Google News | 2h | |
|
|
|
 | Japan's Leader Arrives in Ukraine for Meeting With Zelenskyy |
| Japan's Prime Minister Fumio Kishida visited Kyiv in war-hit Ukraine on Tuesday to meet with President... |
 The Epoch Times | The Epoch Times The Epoch Times | The Epoch Times | 2h | |
|
|
|
 | The Founders and the Constitution, Part 1: Introduction |
| Commentary This series of essays focuses on those American Founders who exercised the most influence... |
 The Epoch Times | The Epoch Times The Epoch Times | The Epoch Times | 2h | |
|
|
|
 | Insurers Scrapping Low-Mileage EVs Because of Battery Non-Repairability |
| Industry experts are warning electric vehicle (EV) makers like Tesla to produce battery packs that are... |
 The Epoch Times | The Epoch Times The Epoch Times | The Epoch Times | 2h | |
|
|
|
 | In Michigan, a Modicum of Justice for a COVID-Exploiting Teachers' Union |
| Commentary America's teachers' unions exploited the COVID-19 pandemic to maximum effect, leveraging... |
 The Epoch Times | The Epoch Times The Epoch Times | The Epoch Times | 2h | |
|
|
|
 | Putin welcomes Xi Kremlin with pomp |
| (21 Mar 2023) Russian President Putin warmly welcomed Chinese leader Xi Jinping to Kremlin sending powerful... |
 Associated Press Associated Press | 2h | |
|
|
|
| Putin, Xi discuss China's peace proposal for Ukraine - CBC News |
| Putin, Xi discuss China's peace proposal for Ukraine CBC News |
 "Russian troops enter Donbas" - Google News "Russian troops enter Donbas" - Google News | 2h | |
|
|
|
| UPDATE 1-Scholz plays down threat of SVB meltdown to Germany - Yahoo Finance |
| UPDATE 1-Scholz plays down threat of SVB meltdown to Germany Yahoo Finance |
 "scholz" - Google News "scholz" - Google News | 2h | |
|
|
|
| Ukraine war – latest news: US shares footage of Russian aircraft 'dumping fuel' on... |
| Ukraine war – latest news: US shares footage of Russian aircraft 'dumping fuel' on drone The Independent |
 "russia-ukraine war news" - Google News "russia-ukraine war news" - Google News | 2h | |
|
|
|
| Multiplex Assays Market Size 2022 Latest Insights, Growth Rate ... - Digital Journal |
| Multiplex Assays Market Size 2022 Latest Insights, Growth Rate ... Digital Journal |
 "Intelligence Assessments of Russia Ukraine War 2022" - Google News "Intelligence Assessments of Russia Ukraine War 2022" - Google News | 2h | |
|
|
|
| Blockchain IoT Market Trend 2022: Industry Upcoming ... - Digital Journal |
| Blockchain IoT Market Trend 2022: Industry Upcoming ... Digital Journal |
 "Intelligence Assessments of Russia Ukraine War 2022" - Google News "Intelligence Assessments of Russia Ukraine War 2022" - Google News | 2h | |
|
|
|
| Banks, Financial Industry Hit by Rising Ransomware Attacks - Wealth Management |
| Banks, Financial Industry Hit by Rising Ransomware Attacks Wealth Management |
 "Intelligence Assessments of Russia Ukraine War 2022" - Google News "Intelligence Assessments of Russia Ukraine War 2022" - Google News | 2h | |
|
|
|
| AI-based Surgical Robots Global Market Report 2023 - Yahoo Finance |
| AI-based Surgical Robots Global Market Report 2023 Yahoo Finance |
 "Intelligence Assessments of Russia Ukraine War 2022" - Google News "Intelligence Assessments of Russia Ukraine War 2022" - Google News | 2h | |
|
|
|
 | Earnings Previews: Chewy, KB Home |
| In the first half-hour of Tuesday's trading, the Dow Jones industrials were up 0.964%, the S&P 500... |
 Markets and Business News Review Markets and Business News Review | 2h | |
|
|
|
 | Pete Buttigieg: Could He Make a Comeback and Run for President? |
| What If Pete Buttigieg Mounts Makes a Comeback and Runs for President Again? – Transportation Secretary Pete... |
 19FortyFive 19FortyFive | 2h | |
|
|
|
 | A Trump Indictment: Does It Make Him President in 2024 or End His Political Career? |
| 3 Reasons the New York Indictment Could Get Trump Re-Elected, and 3 Reasons it Could Cost Him the Race... |
 19FortyFive 19FortyFive | 2h | |
|
|
|
| Some Democrats fear arresting Trump could backfire, question strength of charges... |
| Some Democrats fear arresting Trump could backfire, question strength of charges Fox News |
 "special counsel jack smith" - Google News "special counsel jack smith" - Google News | 2h | |
|
|
|
| This Day in History: Selma to Montgomery March Begins - Yahoo Lifestyle UK |
| This Day in History: Selma to Montgomery March Begins Yahoo Lifestyle UK |
 "Crimean Bridge explosion" - Google News "Crimean Bridge explosion" - Google News | 2h | |
|
|
|
| Putin, Xi discuss Chinese peace proposal as US denounces visit - Cyprus Mail |
| Putin, Xi discuss Chinese peace proposal as US denounces visit Cyprus Mail |
 "Putin and Xi" - Google News "Putin and Xi" - Google News | 2h | |
|
|
|
| Putin welcomes China's Xi to Kremlin amid Ukraine fighting - GazetteNET |
| Putin welcomes China's Xi to Kremlin amid Ukraine fighting GazetteNET |
 "Putin and Xi" - Google News "Putin and Xi" - Google News | 2h | |
|
|
|
| Putin, Xi discuss Chinese peace proposal for Ukraine as US ... - Colorado Springs... |
| Putin, Xi discuss Chinese peace proposal for Ukraine as US ... Colorado Springs Gazette |
 "Putin and Xi" - Google News "Putin and Xi" - Google News | 2h | |
|
|
|
| What Putin and Xi Stand to Gain From Their Moscow Meeting - Bloomberg |
| What Putin and Xi Stand to Gain From Their Moscow Meeting Bloomberg |
 "Putin and Xi" - Google News "Putin and Xi" - Google News | 2h | |
|
|
|
| China leader Xi Jinping to visit Moscow in apparent show of support for Putin - WBAL... |
| China leader Xi Jinping to visit Moscow in apparent show of support for Putin WBAL Radio |
 "Putin and Xi" - Google News "Putin and Xi" - Google News | 2h | |
|
|
|
| Putin Congratulates China’s Xi on Third Term, Hails 'Strengthening ... - The... |
| Putin Congratulates China's Xi on Third Term, Hails 'Strengthening ... The Moscow Times |
 "Putin and Xi" - Google News "Putin and Xi" - Google News | 2h | |
|
|
|
| Belarus dictator Lukashenko, a key Putin ally, lauds China's "peaceful foreign policy"... |
| Belarus dictator Lukashenko, a key Putin ally, lauds China's "peaceful foreign policy" before meeting... |
 "Putin and Xi" - Google News "Putin and Xi" - Google News | 2h | |
|
|
|
| Putin says Xi will visit Russia amid US warnings over Ukraine - The Hill |
| Putin says Xi will visit Russia amid US warnings over Ukraine The Hill |
 "Putin and Xi" - Google News "Putin and Xi" - Google News | 2h | |
|
|
|
| Xi Jinping to visit Moscow for summit with Putin: Report - Hindustan Times |
| Xi Jinping to visit Moscow for summit with Putin: Report Hindustan Times |
 "Putin and Xi" - Google News "Putin and Xi" - Google News | 2h | |
|
|
|
 | Reborn Ringling Bros. circus to leap on tour — minus animals |
| NEW YORK (AP) — The Ringling Bros. and Barnum & Bailey circus has been reimagined and reborn without... |
 Associated Press News: Breaking News | Latest News Today Associated Press News: Breaking News | Latest News Today | 2h | |
|
|
|
 | 'Winnie the Pooh' film pulled from Hong Kong cinemas |
| HONG KONG (AP) — Public screenings of a slasher film that features Winnie the Pooh were scrapped abruptly... |
 Associated Press News: Breaking News | Latest News Today Associated Press News: Breaking News | Latest News Today | 2h | |
|
|
|
| Live updates: Russia's war in Ukraine, Xi's visit to Moscow - CNN International |
| Live updates: Russia's war in Ukraine, Xi's visit to Moscow CNN International |
 "Zelensky" - Google News "Zelensky" - Google News | 2h | |
|
|
|
| Canada's foreign minister says China peace talks in Moscow will ... - Lethbridge... |
| Canada's foreign minister says China peace talks in Moscow will ... Lethbridge News Now |
 "G7 and Russia Ukraine war" - Google News "G7 and Russia Ukraine war" - Google News | 2h | |
|
|
|
| Putin hails China's willingness to help settle Ukraine conflict - Arab News |
| Putin hails China's willingness to help settle Ukraine conflict Arab News |
 "G7 and Russia Ukraine war" - Google News "G7 and Russia Ukraine war" - Google News | 2h | |
|
|
|
| Ukraine-Russia news – live: Kremlin says Putin discussed China's peace plan in 'thorough'... |
| Ukraine-Russia news – live: Kremlin says Putin discussed China's peace plan in 'thorough' talks Yahoo!... |
 "Zelensky and Putin" - Google News "Zelensky and Putin" - Google News | 2h | |
|
|
|
| Ukraine news latest — NATO says ‘Russia has asked China for lethal aid’... |
| Ukraine news latest — NATO says 'Russia has asked China for lethal aid' as Putin & Xi Jinping to... |
 "US Intel: Putin gave orders to invade Ukraine" - Google News "US Intel: Putin gave orders to invade Ukraine" - Google News | 2h | |
|
|
|
| Fox News producer accuses 'misogynistic' network of setting her up to take blame... |
| Fox News producer accuses 'misogynistic' network of setting her up to take blame in Dominion case AOL |
 "US Intel: Putin gave orders to invade Ukraine" - Google News "US Intel: Putin gave orders to invade Ukraine" - Google News | 2h | |
|
|
|
| Irvo Otieno's death: Video shows Virginia deputies and medical workers appearing... |
| Irvo Otieno's death: Video shows Virginia deputies and medical workers appearing to pile on top of him... |
 "US Intel: Putin gave orders to invade Ukraine" - Google News "US Intel: Putin gave orders to invade Ukraine" - Google News | 2h | |
|
|
|
| Mindy Kaling and Bruce Springsteen set to be honoured with humanities medals by Joe... |
| Mindy Kaling and Bruce Springsteen set to be honoured with humanities medals by Joe Biden AOL |
 "US Intel: Putin gave orders to invade Ukraine" - Google News "US Intel: Putin gave orders to invade Ukraine" - Google News | 2h | |
|
|
|
| 'You're a street fighter,' Madigan confidant counseled former speaker: wiretapped... |
| 'You're a street fighter,' Madigan confidant counseled former speaker: wiretapped call Capitol News... |
 "FBI AND ITS ROLE IN ELECTION 2016" - Google News "FBI AND ITS ROLE IN ELECTION 2016" - Google News | 2h | |
|
|
|
| Significant decline in physical activity in the wake of COVID - CBS Miami |
| Significant decline in physical activity in the wake of COVID CBS Miami |
 "COVID" - Google News "COVID" - Google News | 2h | |
|
|
|
| Leading in the workplace in a post-COVID world - 69News WFMZ-TV |
| Leading in the workplace in a post-COVID world 69News WFMZ-TV |
 "COVID" - Google News "COVID" - Google News | 2h | |
|
|
|
| Ignoring experts, China's sudden zero-COVID exit cost lives - Los Angeles Times |
| Ignoring experts, China's sudden zero-COVID exit cost lives Los Angeles Times |
 "COVID" - Google News "COVID" - Google News | 2h | |
|
|
|
| FEMA sending millions of dollars to Maine for COVID-19 response - Press Herald |
| FEMA sending millions of dollars to Maine for COVID-19 response Press Herald |
 "COVID" - Google News "COVID" - Google News | 2h | |
|
|
|
| Online Scalper Busted for Selling $700 Reservations to Michelin ... - Eater NY |
| Online Scalper Busted for Selling $700 Reservations to Michelin ... Eater NY |
 "Sunset park brooklyn" - Google News "Sunset park brooklyn" - Google News | 2h | |
|
|
|
| Seven Out of 30 Allies Met NATO Military Spending Target in 2022-Stoltenberg - U.S.... |
| Seven Out of 30 Allies Met NATO Military Spending Target in 2022-Stoltenberg U.S. News & World Report |
 "Stoltenberg" - Google News "Stoltenberg" - Google News | 2h | |
|
|
|
| Value of assets seized from Rotenberg family, their partners is $300 mln – security... |
| Value of assets seized from Rotenberg family, their partners is $300 mln – security service Interfax-Ukraine |
 "Crimean bridge" - Google News "Crimean bridge" - Google News | 2h | |
|
|
|
| Today on Texas Standard: Indigenous chefs take center stage at ... - Texas Standard |
| Today on Texas Standard: Indigenous chefs take center stage at ... Texas Standard |
 "Robb Elementary Uvalde" - Google News "Robb Elementary Uvalde" - Google News | 2h | |
|
|
|
| How Delaware school death threat worsened rift between police ... - The News Journal |
| How Delaware school death threat worsened rift between police ... The News Journal |
 "Robb Elementary Uvalde" - Google News "Robb Elementary Uvalde" - Google News | 2h | |
|
|
|
| Assembly Bill increases age to buy semi-automatic weapon in Nevada - KOLO |
| Assembly Bill increases age to buy semi-automatic weapon in Nevada KOLO |
 "Robb Elementary Uvalde" - Google News "Robb Elementary Uvalde" - Google News | 2h | |
|
|
|
| Biden Vetoes Anti-ESG Bill, Accomplishing the Barest of Minimums ... - The New Republic |
| Biden Vetoes Anti-ESG Bill, Accomplishing the Barest of Minimums ... The New Republic |
 "Robb Elementary Uvalde" - Google News "Robb Elementary Uvalde" - Google News | 2h | |
|
|
|
| Days After Biden Approves Willow, IPCC Says That Current Fossil ... - The New Republic |
| Days After Biden Approves Willow, IPCC Says That Current Fossil ... The New Republic |
 "Robb Elementary Uvalde" - Google News "Robb Elementary Uvalde" - Google News | 2h | |
|
|
|
| The Chechens Fighting on the Ukrainian Side: Acrylic Paints and … – DER SPIEGEL International... |
| The Chechens Fighting on the Ukrainian Side: Acrylic Paints and … DER SPIEGEL International Edition... |
 Russia - Ukraine War | The Russia News Russia - Ukraine War | The Russia News | 2h | |
|
|
|
 | Michael Novakhov retweeted: This CIA doctor's team investigated... |
| Michael Novakhov retweeted: This CIA doctor's team investigated the mysterious health... |
 Russia - Ukraine War | The Russia News Russia - Ukraine War | The Russia News | 2h | |
|
|
|
 | Putin and Xi Jinping – 10:05 AM 3/21/2023 thenewsandtimes.blogspot.com/2023/03/putin-… |
| Putin and Xi Jinping – 10:05 AM 3/21/2023 thenewsandtimes.blogspot.com/2023/03/putin-… The post... |
 Russia - Ukraine War | The Russia News Russia - Ukraine War | The Russia News | 2h | |
|
|
|
| Japanese Leader Arrives In Kyiv As China's Xi Visits Russia – news9.com KWTV |
| Japanese Leader Arrives In Kyiv As China's Xi Visits Russia news9.com KWTV The post Japanese Leader... |
 Russia - Ukraine War | The Russia News Russia - Ukraine War | The Russia News | 2h | |
|
|
|
| Japanese leader arrives in Kyiv as China's Xi visits Russia – The Seattle Times |
| Japanese leader arrives in Kyiv as China's Xi visits Russia The Seattle Times The post Japanese leader... |
 Russia - Ukraine War | The Russia News Russia - Ukraine War | The Russia News | 2h | |
|
|
|
| Xi, Putin Begin Talks at Kremlin With Ukraine on Agenda – The Moscow Times |
| Xi, Putin Begin Talks at Kremlin With Ukraine on Agenda The Moscow Times The post Xi, Putin Begin Talks... |
 Russia - Ukraine War | The Russia News Russia - Ukraine War | The Russia News | 2h | |
|
|
|
| US, Russia ratchet up their rhetoric over downing of drone – WALB |
| US, Russia ratchet up their rhetoric over downing of drone WALB The post US, Russia ratchet up their... |
 Russia - Ukraine War | The Russia News Russia - Ukraine War | The Russia News | 2h | |
|
|
|
| Russian missiles blown up in Crimea – The Spectator |
| Russian missiles blown up in Crimea The Spectator The post Russian missiles blown up in Crimea – The... |
 Russia - Ukraine War | The Russia News Russia - Ukraine War | The Russia News | 2h | |
|
|
|
| On Xi-Putin visit, the US sees only threats - Responsible Statecraft |
| On Xi-Putin visit, the US sees only threats Responsible Statecraft |
 "global threats to U.S. security 2023" - Google News "global threats to U.S. security 2023" - Google News | 2h | |
|
|
|
| 'Yeah, I was wrong': Anthony Fauci opens up on his regrets in new PBS 'American Masters'... |
| 'Yeah, I was wrong': Anthony Fauci opens up on his regrets in new PBS 'American Masters' documentary Fortune |
 "global threats to U.S. security 2023" - Google News "global threats to U.S. security 2023" - Google News | 2h | |
|
|
|
| Ambassador Bonnie Denise Jenkins to Visit Tuskegee University - Tuskegee University |
| Ambassador Bonnie Denise Jenkins to Visit Tuskegee University Tuskegee University |
 "global threats to U.S. security 2023" - Google News "global threats to U.S. security 2023" - Google News | 2h | |
|
|
|
| ZERO-EMISSION PUBLIC TRANSPORT: 177 MILLION CONTRACT ... - Leonardo |
| ZERO-EMISSION PUBLIC TRANSPORT: 177 MILLION CONTRACT ... Leonardo |
 "global threats to U.S. security 2023" - Google News "global threats to U.S. security 2023" - Google News | 2h | |
|
|
|
| North Korea launches missile into sea amid US-SKorea drills - Lock Haven Express |
| North Korea launches missile into sea amid US-SKorea drills Lock Haven Express |
 "global threats to U.S. security 2023" - Google News "global threats to U.S. security 2023" - Google News | 2h | |
|
|
|
| Cancer: Your Ultimate Guide To The Zodiac Sign - Glam |
| Cancer: Your Ultimate Guide To The Zodiac Sign Glam |
 "aggressive rats in new york city" - Google News "aggressive rats in new york city" - Google News | 2h | |
|
|
|
| Militia sympathizer pleads guilty to having machine gun, grenade ... - Star Tribune |
| Militia sympathizer pleads guilty to having machine gun, grenade ... Star Tribune |
 "Mar-a-Lago searched by FBI 2022" - Google News "Mar-a-Lago searched by FBI 2022" - Google News | 2h | |
|
|
|
| Possible NYC protests: In case of Donald Trump indictment, New ... - WLS-TV |
| Possible NYC protests: In case of Donald Trump indictment, New ... WLS-TV |
 "Mar-a-Lago searched by FBI 2022" - Google News "Mar-a-Lago searched by FBI 2022" - Google News | 2h | |
|
|
|
| Ukraine latest: NATO chief warns China against lethal aid - Nikkei Asia |
| Ukraine latest: NATO chief warns China against lethal aid Nikkei Asia |
 "Wallace - Shoigu talks" - Google News "Wallace - Shoigu talks" - Google News | 2h | |
|
|
|
| Who is Alvin Bragg: Manhattan DA investigating Trump |
| AP correspondent Julie Walker reports on Trump Legal Troubles-Alvin Bragg |
 AP Audio Wire AP Audio Wire | 2h | |
|
|
|
| France: Protests continue after Macron's pension plan push |
| AP correspondent Charles de Ledesma reports on France Pensions-Protests. |
 AP Audio Wire AP Audio Wire | 2h | |
|
|
|
 | Putin, Xi discuss Chinese peace proposal for Ukraine in visit denounced by US |
| 2023-03-21T14:05:49ZChinese President Xi Jinping met his President Vladimir Putin in Moscow on Monday,... |
 Reuters Reuters | 2h | |
|
|
|
 | Seven out of 30 allies met NATO military spending target in 2022-Stoltenberg |
| 2023-03-21T13:59:51ZNATO Secretary-General Jens Stoltenberg holds a news conference to present NATO's... |
 Reuters Reuters | 2h | |
|
|
|
 | Analysis: Social media-driven bank runs burden regulators with a bigger problem |
| 2023-03-21T14:03:24ZFDIC representatives Luis Mayorga and Igor Fayermark speak with customers outside... |
 Reuters Reuters | 2h | |
|
|
|
 | Google begins opening access to its ChatGPT competitor Bard |
| 2023-03-21T14:07:07ZAlphabet Inc's (GOOGL.O) Google on Tuesday began the public release of its chatbot... |
 Reuters Reuters | 2h | |
|
|
|
 | Wall St gains as bank contagion fears ebb, focus on Fed meet |
| 2023-03-21T14:13:03ZInvestors on Tuesday (March 21) took some heart from the rescue of troubled lender... |
 Reuters Reuters | 2h | |
|
|
|
 | Candida auris fungus spreading in U.S. hospitals - CDC |
| 2023-03-21T14:16:28ZA strain of Candida auris cultured in a petri dish at the Centers for Disease Control... |
 Reuters Reuters | 2h | |
|
|
|
 | Ukraine to receive Abrams tanks from US as soon as this fall-sources |
| 2023-03-21T14:19:10ZUS soldiers stand with Polish and US flags near M1/A2 Abrams tank outside a hall... |
 Reuters Reuters | 2h | |
|
|
|
 | Fox, Dominion pursue pretrial wins in $1.6 billion defamation case |
| 2023-03-21T13:58:15ZA headline for a story on the health of U.S. President Joe Biden is displayed at... |
 Reuters Reuters | 2h | |
|
|
|
 | Bad Boys | I Married Joan Season 1, Ep.8 |
| Joan and Judge Bradley try to reform a young juvenile delinquent whose father recently received a stiff... |
 The Epoch Times | The Epoch Times The Epoch Times | The Epoch Times | 2h | |
|
|
|
 | Attorney Robert Costello Says 'Convicted Perjurer' Michael Cohen Has No 'Solid Evidence'... |
| A former legal adviser to Michael Cohen, a key witness in the New York grand jury investigation into... |
 The Epoch Times | The Epoch Times The Epoch Times | The Epoch Times | 2h | |
|
|
|
 | Memories of Pre-Dawn Raids at Gunpoint Haunt Pro-Life Activists, Friends, and Family |
| Jonathan Darnel woke at 5:30 a.m. to fists pounding on his door. There was a crash as it was torn from... |
 The Epoch Times | The Epoch Times The Epoch Times | The Epoch Times | 2h | |
|
|
|
 | Reparations Are a Statist Cudgel for Bludgeoning Property Owners |
| Commentary San Francisco's panel on reparations has issued a recommendation that qualified black residents... |
 The Epoch Times | The Epoch Times The Epoch Times | The Epoch Times | 2h | |
|
|
|
 | Profiles in History: W.W. Keen: The President's Surgeon |
| By the time 1893 rolled around, W.W. Keen (1837–1932) was arguably the most prominent doctor in the country.... |
 The Epoch Times | The Epoch Times The Epoch Times | The Epoch Times | 2h | |
|
|
|
 | Nordstrom Canada Liquidation Sales Expected to Begin Today as Store Prepares for... |
| Nordstrom is expected to begin liquidating its stores across Canada today. The start of the department... |
 The Epoch Times | The Epoch Times The Epoch Times | The Epoch Times | 2h | |
|
|
|
 | Wyoming Becomes 19th State to Ban Biological Males From Girls Sports |
| Wyoming has joined 18 other U.S. states to ban biological male students from competing on girls' or women's... |
 The Epoch Times | The Epoch Times The Epoch Times | The Epoch Times | 2h | |
|
|
|
| Facing arrest warrant, Russia's Putin visits annexed Crimea - Fulton Sun |
| Facing arrest warrant, Russia's Putin visits annexed Crimea Fulton Sun |
 "International criminal court issues arrest warrant for Putin" - Google News "International criminal court issues arrest warrant for Putin" - Google News | 2h | |
|
|
|
| ICC judges issue arrest warrant for Putin over Ukraine - Bay 93.9 |
| ICC judges issue arrest warrant for Putin over Ukraine Bay 93.9 |
 "International criminal court issues arrest warrant for Putin" - Google News "International criminal court issues arrest warrant for Putin" - Google News | 2h | |
|
|
|
 | |
| Michael Novakhov retweeted: This CIA doctor's team investigated the mysterious... |
 Tweets by @mikenov Tweets by @mikenov | 2h | |
|
|
|
 | |
| Putin and Xi Jinping - 10:05 AM 3/21/2023 thenewsandtimes.blogspot.com/2023/03/putin-… |
 Tweets by @mikenov Tweets by @mikenov | 2h | |
|
|
|
| Japanese Leader Arrives In Kyiv As China's Xi Visits Russia - news9.com KWTV |
| Japanese Leader Arrives In Kyiv As China's Xi Visits Russia news9.com KWTV |
 "kyiv" - Google News "kyiv" - Google News | 2h | |
|
|
|
| Japanese leader arrives in Kyiv as China's Xi visits Russia - The Seattle Times |
| Japanese leader arrives in Kyiv as China's Xi visits Russia The Seattle Times |
 "kyiv" - Google News "kyiv" - Google News | 2h | |
|
|
|
| Zelensky visits village of Moshchun near Kyiv - Ukrinform |
| Zelensky visits village of Moshchun near Kyiv Ukrinform |
 "Bucha" - Google News "Bucha" - Google News | 2h | |
|
|
|
| Japanese PM Kishida offers Ukraine support as China's president ... - msnNOW |
| Japanese PM Kishida offers Ukraine support as China's president ... msnNOW |
 "Bucha" - Google News "Bucha" - Google News | 2h | |
|
|
|
| Xi calls Russia ties priority on Moscow trip - 코리아타임스 |
| Xi calls Russia ties priority on Moscow trip 코리아타임스 |
 "Bucha" - Google News "Bucha" - Google News | 2h | |
|
|
|
| Google suspends China's Pinduoduo app on security concerns - Yahoo Eurosport UK |
| Google suspends China's Pinduoduo app on security concerns Yahoo Eurosport UK |
 "Bucha" - Google News "Bucha" - Google News | 2h | |
|
|
|
| Biden administration lets Ukrainians who fled war stay in US - St. Louis Post-Dispatch |
| Biden administration lets Ukrainians who fled war stay in US St. Louis Post-Dispatch |
 "Bucha" - Google News "Bucha" - Google News | 2h | |
|
|
|
| Ukraine, Russia trade claims after blast rocks Crimean town - ABC News |
| Ukraine, Russia trade claims after blast rocks Crimean town ABC News |
 "kherson" - Google News "kherson" - Google News | 2h | |
|
|
|
| Cue Health receives FDA emergency use authorization for ... - LabPulse |
| Cue Health receives FDA emergency use authorization for ... LabPulse |
 "monkeypox" - Google News "monkeypox" - Google News | 2h | |
|
|
|
| |
| The Associated Press retweeted: Minnesota regulators knew four months... |
 The Associated Press (Twitter) The Associated Press (Twitter) | 2h | |
|
|
|
 | |
| Treasury Secretary Janet Yellen says the U.S. banking system is "sound" but additional rescue arrangements... |
 The Associated Press (Twitter) The Associated Press (Twitter) | 2h | |
|
|
|
| |
| The Associated Press retweeted: President Biden is establishing national... |
 The Associated Press (Twitter) The Associated Press (Twitter) | 2h | |
|
|
|
| |
| A New York grand jury investigating Donald Trump over a hush money payment to a porn actress Stormy Daniels... |
 The Associated Press (Twitter) The Associated Press (Twitter) | 2h | |
|
|
|
 | |
| A massive fire destroyed a New Jersey church, collapsing its roof as more than 150 firefighters fought... |
 The Associated Press (Twitter) The Associated Press (Twitter) | 2h | |
|
|
|
| Remembering Leonid Gambarov, 82 - Yahoo Sports |
| Remembering Leonid Gambarov, 82 Yahoo Sports |
 "kharkiv" - Google News "kharkiv" - Google News | 2h | |
|
|
|
| Remembering Hryhoriy Grigoriev, 35 - Yahoo Sports |
| Remembering Hryhoriy Grigoriev, 35 Yahoo Sports |
 "kharkiv" - Google News "kharkiv" - Google News | 2h | |
|
|
|
| 470000 Hectares Of Fields In 9 Regions Need To Be Demined For ... - Ukrainian News... |
| 470000 Hectares Of Fields In 9 Regions Need To Be Demined For ... Ukrainian News Agency |
 "kharkiv" - Google News "kharkiv" - Google News | 2h | |
|
|
|
| Jim Jordan's Defense of Trump a 'Gross Abuse of Power,' Kirschner Says - Newsweek |
| Jim Jordan's Defense of Trump a 'Gross Abuse of Power,' Kirschner Says Newsweek |
 trump - Google News trump - Google News | 2h | |
|
|
|
| Opinion | Trump hush money case involving Daniels is driven by three truths - The... |
| Opinion | Trump hush money case involving Daniels is driven by three truths The Washington Post |
 trump - Google News trump - Google News | 2h | |
|
|
|
| Alvin Bragg Gets to Decide If Trump Is Right - National Review |
| Alvin Bragg Gets to Decide If Trump Is Right National Review |
 trump - Google News trump - Google News | 2h | |
|
|
|
| Martina Navratilova says doctors told her she is cancer-free |
| |
 All Stories All Stories | 2h | |
|
|
|
| Scholz spoke about telephone conversations with Putin. - PoliticalLore.com |
| Scholz spoke about telephone conversations with Putin. PoliticalLore.com |
 "scholz and putin" - Google News "scholz and putin" - Google News | 2h | |
|
|
|
| Diplomacy: Chancellor Scholz gives insights into telephone calls ... - INDONEWYORK |
| Diplomacy: Chancellor Scholz gives insights into telephone calls ... INDONEWYORK |
 "scholz and putin" - Google News "scholz and putin" - Google News | 2h | |
|
|
|
| Radio Station WHMI 93.5 FM — Livingston County Michigan News ... - WHMI |
| Radio Station WHMI 93.5 FM — Livingston County Michigan News ... WHMI |
 "blinken and lavrov" - Google News "blinken and lavrov" - Google News | 2h | |
|
|
|
| Single Dose of Smallpox Vaccine Highly Effective Against Mpox - Contagionlive.com |
| Single Dose of Smallpox Vaccine Highly Effective Against Mpox Contagionlive.com |
 "2022 monkeypox outbreak" - Google News "2022 monkeypox outbreak" - Google News | 2h | |
|
|
|
 | Central Bank Rate Bets Send Dollar, Sterling, Franc Different Ways |
| LONDON—The dollar fell and sterling steadied on Tuesday as traders reckoned banking stress could keep... |
 The Epoch Times | The Epoch Times The Epoch Times | The Epoch Times | 2h | |
|
|
|
 | China's Influence in Canada Worse Than Expected |
| Commentary Canada is in an uproar. On Saturday, the New York Times called Canadian concerns about China's... |
 The Epoch Times | The Epoch Times The Epoch Times | The Epoch Times | 2h | |
|
|
|
 | Oil Rises for 2nd Day as Banking Fears Ease for Now |
| LONDON—Oil rose on Tuesday, extending a recovery from a 15-month low hit the previous day, as the rescue... |
 The Epoch Times | The Epoch Times The Epoch Times | The Epoch Times | 2h | |
|
|
|
| Odessa Police looking for help finding missing woman - KOSA |
| Odessa Police looking for help finding missing woman KOSA |
 "Odessa" - Google News "Odessa" - Google News | 2h | |
|
|
|
| The fall of Russia's Odesa – POLITICO - POLITICO Europe |
| The fall of Russia's Odesa – POLITICO POLITICO Europe |
 "Odessa" - Google News "Odessa" - Google News | 2h | |
|
|
|
| The tragedy of war – Canadian Dimension - Canadian Dimension |
| The tragedy of war – Canadian Dimension Canadian Dimension |
 "Russian troops enter Donbas" - Google News "Russian troops enter Donbas" - Google News | 2h | |
|
|
|
| Putin, Xi discuss Chinese peace proposal for Ukraine as US ... - TODAY |
| Putin, Xi discuss Chinese peace proposal for Ukraine as US ... TODAY |
 "Putin and Xi Jinping" - Google News "Putin and Xi Jinping" - Google News | 2h | |
|
|
|
| Putin wants more than Xi Jinping offered – ISW - Yahoo! Voices |
| Putin wants more than Xi Jinping offered – ISW Yahoo! Voices |
 "Putin and Xi Jinping" - Google News "Putin and Xi Jinping" - Google News | 2h | |
|
|
|
| 'He has a battle rifle': Police feared Uvalde gunman's AR-15 - 12newsnow.com KBMT-KJAC |
| 'He has a battle rifle': Police feared Uvalde gunman's AR-15 12newsnow.com KBMT-KJAC |
 "Uvalde" - Google News "Uvalde" - Google News | 2h | |
|
|
|
| Letters March 21, 2023: 'Russia should lose their seat at UN's Security Council.'... |
| Letters March 21, 2023: 'Russia should lose their seat at UN's Security Council.' Calgary Sun |
 "National Security Council" - Google News "National Security Council" - Google News | 2h | |
|
|
|
| Google launches Bard chatbot to rival OpenAI's ChatGPT |
| Tech giant seeks to make up lost ground in race to commercialise generative AI technology |
 Markets and Business News Review Markets and Business News Review | 2h | |
|
|
|
| Bafta Game Awards show ingenuity of smaller developers |
| Titles such as 'Cult of the Lamb' and 'Trombone Champ' prove that nimble indies can compete with big... |
 Markets and Business News Review Markets and Business News Review | 2h | |
|
|
|
| First Republic shares rebound after Yellen signals support for smaller banks |
| Lender's stock jumps 30% per cent as bank shares bounce back |
 Markets and Business News Review Markets and Business News Review | 2h | |
|
|
|
 | Yelp Stock Down 14% Over Six Months. What's Next? |
| After a 14% decline over the last six months, at the current price of around $31 per share, we believe... |
 Markets and Business News Review Markets and Business News Review | 2h | |
|
|
|
 | Drag Story Hours Spark Angry Anti-LGBTQ Rallies—Latest In NYC Included Proud Boys |
| Anti-drag protests are ramping up, and story hour events, where a drag performer reads to children, are... |
 Markets and Business News Review Markets and Business News Review | 2h | |
|
|
|
| Amazon’s Cruel CEO |
| Amazon's relatively new chief executive, Andy Jassy, has laid off another 9,000 people, bringing the... |
 Markets and Business News Review Markets and Business News Review | 2h | |
|
|
|
 | Paris Saint Germain Prepare New Contract Renewal Offer For Lionel Messi Stay To Snub... |
| Paris Saint Germain are preparing a fresh contract renewal offer it is hoped will convince Lionel Messi... |
 Markets and Business News Review Markets and Business News Review | 2h | |
|
|
|
 | Good Enough To Beat Barcelona and Porto, But Not Spezia And Empoli - The Return Of... |
| Inter have had a very weird season. Good enough to beat Barcelona and Porto, yet lose to Spezia, Bologna... |
 Markets and Business News Review Markets and Business News Review | 2h | |
|
|
|
 | Despite Injury To Jose Altuve, Houston Astros Remain AL West Favorite |
| The youthful Mariners and the improved Angels and Rangers are lying in wait should the World Champions... |
 Markets and Business News Review Markets and Business News Review | 2h | |
|
|
|
 | Does Diageo Stock Have More Room For Growth? |
| Diageo's stock (NYSE: DEO) has seen a fall of 4% this year, compared with 2% returns for the broader... |
 Markets and Business News Review Markets and Business News Review | 2h | |
|
|
|
 | U.K.'s Biggest Police Force Is Institutionally Sexist, Racist And Homophobic, Report... |
| The scathing independent report cataloged abuse and bullying including competitions to make female students... |
 Markets and Business News Review Markets and Business News Review | 2h | |
|
|
|
 | Women's Sweet 16 features new format and historic field |
| The Sweet 16 features a new format and a bit of history when it begins later this week.The NCAA changed... |
 Associated Press News: Breaking News | Latest News Today Associated Press News: Breaking News | Latest News Today | 2h | |
|
|
|
| BBC Sport presenter expertly shuts down troll who asked her a vile question - indy100 |
| BBC Sport presenter expertly shuts down troll who asked her a vile question indy100 |
 "twitter down" - Google News "twitter down" - Google News | 2h | |
|
|
|
| Biden shredded after issuing first veto of his presidency to protect ... - Fox News |
| Biden shredded after issuing first veto of his presidency to protect ... Fox News |
 "twitter down" - Google News "twitter down" - Google News | 2h | |
|
|
|
| Recovering teacher shot by 6-year-old: 'It's changed me' - Tulsa World |
| Recovering teacher shot by 6-year-old: 'It's changed me' Tulsa World |
 "Tulsa shooting" - Google News "Tulsa shooting" - Google News | 2h | |
|
|
|
 | Just Incredible: See Ukrainian Soldier Firing TOW 2B Missile |
| This week, an incredible series of photographs shared on social media shows the moment a Ukrainian soldier... |
 19FortyFive 19FortyFive | 2h | |
|
|
|
| Russia, China united against U.S. but not in everything else - Los Angeles Times |
| Russia, China united against U.S. but not in everything else Los Angeles Times |
 "Will Russia turn to the West?" - Google News "Will Russia turn to the West?" - Google News | 2h | |
|
|
|
| Indonesia to phase out Visa and Mastercard, develop own payment ... - OpIndia |
| Indonesia to phase out Visa and Mastercard, develop own payment ... OpIndia |
 "Will Russia turn to the West?" - Google News "Will Russia turn to the West?" - Google News | 2h | |
|
|
|
| Russia's reliance on China rises amid Ukraine sanctions - ABC News |
| Russia's reliance on China rises amid Ukraine sanctions ABC News |
 "Will Russia turn to the West?" - Google News "Will Russia turn to the West?" - Google News | 2h | |
|
|
|
| Russia's War in Ukraine Is Affecting Egypt's Trade and Diplomacy - Business Insider |
| Russia's War in Ukraine Is Affecting Egypt's Trade and Diplomacy Business Insider |
 "Will Russia turn to the West?" - Google News "Will Russia turn to the West?" - Google News | 2h | |
|
|
|
| No, the US hasn't 'lost' Vietnam - Asia Times |
| No, the US hasn't 'lost' Vietnam Asia Times |
 "Will Russia turn to the West?" - Google News "Will Russia turn to the West?" - Google News | 2h | |
|
|
|
 | Chamber of Commerce Warns of 'Serious Threat to Privacy of Canadians' |
| A parliamentary committee has requested internal and external documents from tech companies to see what... |
 The Epoch Times | The Epoch Times The Epoch Times | The Epoch Times | 2h | |
|
|
|
 | Hypertension Medications Can Increase Stroke Risk: Pressing 2 Acupoints May Effectively... |
| High blood pressure or hypertension is called the "silent killer" because it often has no symptoms to... |
 The Epoch Times | The Epoch Times The Epoch Times | The Epoch Times | 2h | |
|
|
|
 | Shares Rise After Credit Suisse Deal, but Bank 'Whack-a-Mole' Not Over |
| LONDON/SINGAPORE—Global shares rose on Tuesday, after the rescue of Credit Suisse arrested a rout in... |
 The Epoch Times | The Epoch Times The Epoch Times | The Epoch Times | 2h | |
|
|
|
 | Obese Young Man Weighed 820 Pounds Now Unrecognizable After Dropping 600 Pounds |
| A formerly-obese man whose weight crisis was aired on global TV has amazingly turned his life around.... |
 The Epoch Times | The Epoch Times The Epoch Times | The Epoch Times | 2h | |
|
|
|
 | Alabama's Quinerly seeking sweet ending in March Madness |
| Jahvon Quinerly's knee injury that helped doom Alabama's NCAA Tournament chances a year ago is hardly... |
 Associated Press News: Breaking News | Latest News Today Associated Press News: Breaking News | Latest News Today | 2h | |
|
|
|
| Palm Beach warns of traffic delays near Mar-a-Lago ahead of possible Trump arrest... |
| Palm Beach warns of traffic delays near Mar-a-Lago ahead of possible Trump arrest Palm Beach Daily News |
 "Mar-a-Lago" - Google News "Mar-a-Lago" - Google News | 2h | |
|
|
|
| Battling Corruption in Ukraine—and the U.S. - The New Yorker |
| Battling Corruption in Ukraine—and the U.S. The New Yorker |
 "Zelensky and Putin" - Google News "Zelensky and Putin" - Google News | 2h | |
|
|
|
 | Video released of man's death at Virginia mental health facility |
| • Video shows man's final moment before his death at a mental health facility |
 CNN.com - Top Stories CNN.com - Top Stories | 2h | |
|
|
|
 | Kitchen renovation unearths paintings nearly 400 years old |
| Murals believed to be nearly 400 years old have been discovered at an apartment in northern England following... |
 CNN.com - Top Stories CNN.com - Top Stories | 2h | |
|
|
|
 | Video: 5 years later, Taylor Swift makes good on promise to young fan |
| After a bad accident caused Isabella McCune to miss Taylor Swift's 2018 "Reputation" tour, the singer... |
 CNN.com - Top Stories CNN.com - Top Stories | 2h | |
|
|
|
| Is there a war on? Big EU powers miss NATO spending targets again - POLITICO Europe |
| Is there a war on? Big EU powers miss NATO spending targets again POLITICO Europe |
 "Stoltenberg" - Google News "Stoltenberg" - Google News | 2h | |
|
|
|
| Seven out of 30 allies met NATO military spending target in 2022 ... - Reuters.com |
| Seven out of 30 allies met NATO military spending target in 2022 ... Reuters.com |
 "Stoltenberg" - Google News "Stoltenberg" - Google News | 2h | |
|
|
|
| Trump rally in Waco planned amid possible indictment and arrest - Austin American-Statesman |
| Trump rally in Waco planned amid possible indictment and arrest Austin American-Statesman |
 "FBI AND ITS ROLE IN ELECTION 2016" - Google News "FBI AND ITS ROLE IN ELECTION 2016" - Google News | 2h | |
|
|
|
 | Putin and Xi Jinping – 10:05 AM 3/21/2023 |
| Putin and Xi Jinping – 10:05 AM 3/21/2023 Ukraine war live updates: Russian mercenaries say Kyiv... |
 News-Links – news-links.org News-Links – news-links.org | 2h | |
|
|
|
| Reward offered for man in COVID mask accused of passing forged check at Amarillo... |
| Reward offered for man in COVID mask accused of passing forged check at Amarillo bank abc7amarillo.com |
 "COVID" - Google News "COVID" - Google News | 2h | |
|
|
|
| Winter's feared 'tripledemic' fizzled; new vaccines, at-home tests for flu, COVID-19,... |
| Winter's feared 'tripledemic' fizzled; new vaccines, at-home tests for flu, COVID-19, RSV on the horizon cleveland.com |
 "COVID" - Google News "COVID" - Google News | 2h | |
|
|
|
| Reason for Covid lockdown fine 'remains unclear', says Johnson - The Independent |
| Reason for Covid lockdown fine 'remains unclear', says Johnson The Independent |
 "COVID" - Google News "COVID" - Google News | 2h | |
|
|
|
| Local public health directors address state's potential changes to COVID data protocols... |
| Local public health directors address state's potential changes to COVID data protocols RochesterFirst |
 "COVID" - Google News "COVID" - Google News | 2h | |
|
|
|
| Ignoring experts, China's sudden zero-COVID exit cost lives - The Associated Press |
| Ignoring experts, China's sudden zero-COVID exit cost lives The Associated Press |
 "COVID" - Google News "COVID" - Google News | 2h | |
|
|
|
 | Putin and Xi Jinping - 10:05 AM 3/21/2023 |
| Putin and Xi Jinping - 10:05 AM 3/21/2023Ukraine war live updates: Russian mercenaries say Kyiv is preparing... |
 The News And Times The News And Times | 2h | |
|
|
|
| Xi, Putin Begin Talks at Kremlin With Ukraine on Agenda - The Moscow Times |
| Xi, Putin Begin Talks at Kremlin With Ukraine on Agenda The Moscow Times |
 "Russia-Ukraine war" - Google News "Russia-Ukraine war" - Google News | 2h | |
|
|
|
| US, Russia ratchet up their rhetoric over downing of drone - WALB |
| US, Russia ratchet up their rhetoric over downing of drone WALB |
 "U.S. and Russia" - Google News "U.S. and Russia" - Google News | 2h | |
|
|
|
| Russian missiles blown up in Crimea - The Spectator |
| Russian missiles blown up in Crimea The Spectator |
 "Crimean bridge" - Google News "Crimean bridge" - Google News | 2h | |
|
|
|
 | AP Headline News - Mar 21 2023 10:00 (EDT) |
| |
 Associated Press Bulletins Associated Press Bulletins | 2h | |
|
|
|
| Clario partners with Strados to offer respiratory tech for clinical trials - FierceBiotech |
| Clario partners with Strados to offer respiratory tech for clinical trials FierceBiotech |
 "aggressive rats in new york city" - Google News "aggressive rats in new york city" - Google News | 2h | |
|
|
|
| Putin and Xi must be taught the lessons Hitler and Mussolini learned the hard way... |
| Putin and Xi must be taught the lessons Hitler and Mussolini learned the hard way The Hill |
 "Putin Biden summit" - Google News "Putin Biden summit" - Google News | 2h | |
|
|
|
| Lebanon and Syria and the Saudi-Iran Detente - Arab Center Washington DC |
| Lebanon and Syria and the Saudi-Iran Detente Arab Center Washington DC |
 "Israel and Russia- Ukraine war 2022" - Google News "Israel and Russia- Ukraine war 2022" - Google News | 2h | |
|
|
|
| Explainer: Why the US doesn't recognise Palestine - The Business Standard |
| Explainer: Why the US doesn't recognise Palestine The Business Standard |
 "Israel and Russia- Ukraine war 2022" - Google News "Israel and Russia- Ukraine war 2022" - Google News | 2h | |
|
|
|
| What's It Like to Live in a Grocery Store? Surprisingly Comfortable. - The New York... |
| What's It Like to Live in a Grocery Store? Surprisingly Comfortable. The New York Times |
 "project raven" - Google News "project raven" - Google News | 2h | |
|
|
|
 | Nexus Trusted-Traveller Program to Fully Resume by April 24 After Yearlong Standoff |
| The Nexus trusted-traveller program will fully ramp back up within five weeks, allowing frequent border... |
 The Epoch Times | The Epoch Times The Epoch Times | The Epoch Times | 2h | |
|
|
|
 | Wall Street Opens Higher as Bank Fears Ease, Focus on Fed |
| Wall Street's main indexes opened higher on Tuesday as the rescue of Credit Suisse calmed nerves about... |
 The Epoch Times | The Epoch Times The Epoch Times | The Epoch Times | 2h | |
|
|
|
| Japan to Invite Global South, South Korea to G7 Summit - The Japan News |
| Japan to Invite Global South, South Korea to G7 Summit The Japan News |
 "G7" - Google News "G7" - Google News | 3h | |
|
|
|
| Diet Coke Valet Is Trump's Most Loyal Aide - New York Magazine |
| Diet Coke Valet Is Trump's Most Loyal Aide New York Magazine |
 "James Comey" - Google News "James Comey" - Google News | 3h | |
|
|
|
 | In Ukraine to offer solidarity, Japan"s Kishida tours Bucha massacre site |
| 2023-03-21T13:30:40ZJapan's Fumio Kishida arrived in Kyiv for a meeting with President Volodymyr Zelenskiy... |
 Reuters Reuters | 3h | |
|
|
|
 | Wall Street opens higher as bank fears ease, focus on Fed |
| 2023-03-21T13:35:37ZInvestors on Tuesday (March 21) took some heart from the rescue of troubled lender... |
 Reuters Reuters | 3h | |
|
|
|
 | Video shows Virginia deputies, medical staffers struggling to restrain Black man |
| 2023-03-21T13:24:18ZA portrait of Irvo Otieno, who died during an encouter with law enforcement in Petersburg,... |
 Reuters Reuters | 3h | |
|
|
|
| Ukraine amends 2023 budget to channel more funds for defence - Reuters.com |
| Ukraine amends 2023 budget to channel more funds for defence Reuters.com |
 "Ukraine" - Google News "Ukraine" - Google News | 3h | |
|
|
|
| US speeds up Abrams tank delivery to Ukraine war zone - Yahoo Finance |
| US speeds up Abrams tank delivery to Ukraine war zone Yahoo Finance |
 "Ukraine" - Google News "Ukraine" - Google News | 3h | |
|
|
|
| Italy's Meloni ready to risk unpopularity over support for Ukraine - Reuters |
| Italy's Meloni ready to risk unpopularity over support for Ukraine Reuters |
 "Ukraine" - Google News "Ukraine" - Google News | 3h | |
|
|
|
| Ukraine war - latest: China and Russia don't have 'power' of US ... - Sky News |
| Ukraine war - latest: China and Russia don't have 'power' of US ... Sky News |
 "International criminal court issues arrest warrant for Putin" - Google News "International criminal court issues arrest warrant for Putin" - Google News | 3h | |
|
|
|
| Biden says International Criminal Court 'justified' following Putin arrest warrant... |
| Biden says International Criminal Court 'justified' following Putin arrest warrant Yahoo Entertainment |
 "International criminal court issues arrest warrant for Putin" - Google News "International criminal court issues arrest warrant for Putin" - Google News | 3h | |
|
|
|
| International court issues war crimes warrant for Putin - Naharnet |
| International court issues war crimes warrant for Putin Naharnet |
 "International criminal court issues arrest warrant for Putin" - Google News "International criminal court issues arrest warrant for Putin" - Google News | 3h | |
|
|
|
| What's International Criminal Court that has issued arrest warrant against Putin... |
| What's International Criminal Court that has issued arrest warrant against Putin Economic Times |
 "International criminal court issues arrest warrant for Putin" - Google News "International criminal court issues arrest warrant for Putin" - Google News | 3h | |
|
|
|
| Dow jumps 200 points, First Republic leads regional banks higher: Live updates -... |
| Dow jumps 200 points, First Republic leads regional banks higher: Live updates CNBC |
 "g-7 2022" - Google News "g-7 2022" - Google News | 3h | |
|
|
|
| Japan PM Kishida visits Bucha in 'historic' Ukraine trip - Al Arabiya English |
| Japan PM Kishida visits Bucha in 'historic' Ukraine trip Al Arabiya English |
 "Bucha" - Google News "Bucha" - Google News | 3h | |
|
|
|
| Japan PM Kishida Visits Bucha In 'Historic' Ukraine Trip - Barron's |
| Japan PM Kishida Visits Bucha In 'Historic' Ukraine Trip Barron's |
 "Bucha" - Google News "Bucha" - Google News | 3h | |
|
|
|
| Xi, Putin begin talks at Kremlin with Ukraine on agenda - FRANCE 24 English |
| Xi, Putin begin talks at Kremlin with Ukraine on agenda FRANCE 24 English |
 "Bucha" - Google News "Bucha" - Google News | 3h | |
|
|
|
| Culture Ministry Closes Access To Caves In Kyiv-Pechersk Lavra To UOC MP - Ukrainian... |
| Culture Ministry Closes Access To Caves In Kyiv-Pechersk Lavra To UOC MP Ukrainian News Agency |
 "kyiv" - Google News "kyiv" - Google News | 3h | |
|
|
|
| Japan's PM offers Ukraine support as China's Xi backs Russia - Yahoo News |
| Japan's PM offers Ukraine support as China's Xi backs Russia Yahoo News |
 "kyiv" - Google News "kyiv" - Google News | 3h | |
|
|
|
| Ukraine Is Successfully Using a 140-Year-Old Machine Gun Against ... - VICE |
| Ukraine Is Successfully Using a 140-Year-Old Machine Gun Against ... VICE |
 "weapons for ukraine" - Google News "weapons for ukraine" - Google News | 3h | |
|
|
|
| Kharkiv's ghost towns: villages near Russian border deserted and ... - Yeni Şafak... |
| Kharkiv's ghost towns: villages near Russian border deserted and ... Yeni Şafak English |
 "kharkiv" - Google News "kharkiv" - Google News | 3h | |
|
|
|
 | |
| Bullfighting aficionados are raising money to try to fend off an effort to ban the fights in Colombia,... |
 The Associated Press (Twitter) The Associated Press (Twitter) | 3h | |
|
|
|
| |
| The Associated Press retweeted: The Paris Olympics is going underground... |
 The Associated Press (Twitter) The Associated Press (Twitter) | 3h | |
|
|
|
| Explosion of collaborator's car in Kherson Oblast kills "chief" of pre-trial detention... |
| Explosion of collaborator's car in Kherson Oblast kills "chief" of pre-trial detention centre Yahoo... |
 "kherson" - Google News "kherson" - Google News | 3h | |
|
|
|
| Trump Indictment Watch: All NYPD Cops Ordered to Patrol in Uniform, Ready for Mobilization... |
| Trump Indictment Watch: All NYPD Cops Ordered to Patrol in Uniform, Ready for Mobilization NBC New York |
 trump - Google News trump - Google News | 3h | |
|
|
|
| McCarthy downplays possible N.Y. case against Trump, dismisses it as 'personal money'... |
| McCarthy downplays possible N.Y. case against Trump, dismisses it as 'personal money' The Washington... |
 trump - Google News trump - Google News | 3h | |
|
|
|
| Graham, Franken bet $20 on Trump vs. Biden 2024 - The Hill |
| Graham, Franken bet $20 on Trump vs. Biden 2024 The Hill |
 trump - Google News trump - Google News | 3h | |
|
|
|
| Grand jury won't vote on Trump indictment Tuesday: Sources - NewsNation Now |
| Grand jury won't vote on Trump indictment Tuesday: Sources NewsNation Now |
 trump - Google News trump - Google News | 3h | |
|
|
|
| Here's more evidence Alvin Bragg's crusade against Donald Trump is political - Fox... |
| Here's more evidence Alvin Bragg's crusade against Donald Trump is political Fox News |
 trump - Google News trump - Google News | 3h | |
|
|
|
| Trump Asks Voters to Sign Petition Against Arrest, Then Asks for Money - Business... |
| Trump Asks Voters to Sign Petition Against Arrest, Then Asks for Money Business Insider |
 trump - Google News trump - Google News | 3h | |
|
|
|
 | Cold Water for Cleaner Hands? |
| I've heard that it is best to wash your hands in cold rather than warm water. This makes no sense to... |
 The Epoch Times | The Epoch Times The Epoch Times | The Epoch Times | 3h | |
|
|
|
 | Your Daughter for a Rat? |
| Commentary There are various degrees of acceptable insanity, but in general you would not want a person... |
 The Epoch Times | The Epoch Times The Epoch Times | The Epoch Times | 3h | |
|
|
|
 | House Freedom Caucus Opposes Unlimited Bank Deposit Guarantees |
| House conservatives have voiced their opposition to any increased guarantees on bank deposits, which... |
 The Epoch Times | The Epoch Times The Epoch Times | The Epoch Times | 3h | |
|
|
|
 | LIVE 10 AM ET: Treasury Secretary Yellen Speaks at Annual Bankers Summit in Washington |
| U.S. Treasury Secretary Janet Yellen speaks at American Bankers Association's annual Washington Summit... |
 The Epoch Times | The Epoch Times The Epoch Times | The Epoch Times | 3h | |
|
|
|
 | Income Tax Cuts Expected as Quebec Finance Minister to Table Budget Today |
| Quebec Finance Minister Eric Girard is scheduled to table the first budget of the Coalition Avenir Québec's... |
 The Epoch Times | The Epoch Times The Epoch Times | The Epoch Times | 3h | |
|
|
|
 | Latest Border Encounter Numbers Expose Biden's Ports of Entry Bait-and-Switch |
| Commentary As expected, the Biden administration has started using its port parole program shell game to... |
 The Epoch Times | The Epoch Times The Epoch Times | The Epoch Times | 3h | |
|
|
|
| US speeds up Abrams tank delivery to Ukraine war zone |
| |
 All Stories All Stories | 3h | |
|
|
|
 | |
| ISW retweeted: Prigozhin's claim that Russian forces control about 70%... |
 ISW (Twitter) ISW (Twitter) | 3h | |
|
|
|
| Soldier found shot to death in North Carolina. Now, fellow soldier charged with murder... |
| Soldier found shot to death in North Carolina. Now, fellow soldier charged with murder Idaho Statesman |
 "Idaho murders" - Google News "Idaho murders" - Google News | 3h | |
|
|
|
| Man Killed When run over by Train at Southern Idaho Railyard - bigcountrynewsconnection.com |
| Man Killed When run over by Train at Southern Idaho Railyard bigcountrynewsconnection.com |
 "Idaho murders" - Google News "Idaho murders" - Google News | 3h | |
|
|
|
| US speeds up Abrams tank delivery to Ukraine war zone - The Hill |
| US speeds up Abrams tank delivery to Ukraine war zone The Hill |
 "russia-ukraine war" - Google News "russia-ukraine war" - Google News | 3h | |
|
|
|
| Japan's PM offers Ukraine support as China's Xi backs Russia - Toronto Star |
| Japan's PM offers Ukraine support as China's Xi backs Russia Toronto Star |
 "russia-ukraine war" - Google News "russia-ukraine war" - Google News | 3h | |
|
|
|
 | Entrenamiento para la guerra en un mundo virtual |
| (21 Mar 2023) Los ejércitos modernos pronto podrían aprender a ir a la guerra utilizando juegos de computadora.... |
 Associated Press Associated Press | 3h | |
|
|
|
| E-bike Market size in Benelux to grow by 1,214.05 thousand units from 2022 to 2027,... |
| E-bike Market size in Benelux to grow by 1,214.05 thousand units from 2022 to 2027, Driven by health... |
 "Intelligence Assessments of Russia Ukraine War 2022" - Google News "Intelligence Assessments of Russia Ukraine War 2022" - Google News | 3h | |
|
|
|
| Sales intelligence Market 2023: Industrial Growth, Share, Emerging ... - Digital... |
| Sales intelligence Market 2023: Industrial Growth, Share, Emerging ... Digital Journal |
 "Intelligence Assessments of Russia Ukraine War 2022" - Google News "Intelligence Assessments of Russia Ukraine War 2022" - Google News | 3h | |
|
|
|
| Moving Forward Foundation hosting special presentation of new school in Uvalde Tuesday... |
| Moving Forward Foundation hosting special presentation of new school in Uvalde Tuesday KENS5.com |
 "Uvalde" - Google News "Uvalde" - Google News | 3h | |
|
|
|
| Virginia Teacher Shot by 6-Year-Old Student Breaks Silence - Newsweek |
| Virginia Teacher Shot by 6-Year-Old Student Breaks Silence Newsweek |
 "Uvalde" - Google News "Uvalde" - Google News | 3h | |
|
|
|
| KSAT 12 6 O'Clock News : Mar 20, 2023 - KSAT San Antonio |
| KSAT 12 6 O'Clock News : Mar 20, 2023 KSAT San Antonio |
 "Uvalde" - Google News "Uvalde" - Google News | 3h | |
|
|
|
| In the Aftermath of the Mass Shooting at an Elementary School in Uvalde, Texas, Right-wing... |
| In the Aftermath of the Mass Shooting at an Elementary School in Uvalde, Texas, Right-wing ... - Latest LatestLY |
 "Uvalde" - Google News "Uvalde" - Google News | 3h | |
|
|
|
| How will the Russia-Ukraine war end? | News | Palo Alto Online | - Palo Alto Online |
| How will the Russia-Ukraine war end? | News | Palo Alto Online | Palo Alto Online |
 "russia-ukraine war news" - Google News "russia-ukraine war news" - Google News | 3h | |
|
|
|
 | Austrian museum skews paintings to reflect climate change |
| VIENNA (AP) — A Vienna museum is hanging some of its paintings at an angle to reflect the possible effects... |
 Associated Press News: Breaking News | Latest News Today Associated Press News: Breaking News | Latest News Today | 3h | |
|
|
|
 | Analysis: Injuries slowed progress in Detroit, Charlotte |
| The Detroit Pistons entered the season with a young nucleus led by Cade Cunningham, the No. 1 pick in... |
 Associated Press News: Breaking News | Latest News Today Associated Press News: Breaking News | Latest News Today | 3h | |
|
|
|
| Opening Bell Analysts Research Calls for Tuesday, March 21 |
| This report was sent to Briefing.com subscribers earlier today. Research calls posted earlier this... |
 Markets and Business News Review Markets and Business News Review | 3h | |
|
|
|
| Who killed Credit Suisse? |
| The legality of liquidity versus solvency |
 Markets and Business News Review Markets and Business News Review | 3h | |
|
|
|
| Biden shredded after issuing first veto of his presidency to protect ESG: 'Such a... |
| Biden shredded after issuing first veto of his presidency to protect ESG: 'Such a liar' Fox News |
 "twitter down" - Google News "twitter down" - Google News | 3h | |
|
|
|
| Foreign Ministry Spokesperson Wang Wenbin's Regular Press ... - MFA China |
| Foreign Ministry Spokesperson Wang Wenbin's Regular Press ... MFA China |
 "Blinken: US to lead international Russia-Ukraine bloc against China" - Google News "Blinken: US to lead international Russia-Ukraine bloc against China" - Google News | 3h | |
|
|
|
| Following west's financial sanctions on Russia, Indonesia to phase out Visa and Mastercard,... |
| Following west's financial sanctions on Russia, Indonesia to phase out Visa and Mastercard, reduce dependence... |
 "Will Russia turn to the West?" - Google News "Will Russia turn to the West?" - Google News | 3h | |
|
|
|
| Indicting the 'Teflon president' - The Week |
| Indicting the 'Teflon president' The Week |
 "special counsel jack smith" - Google News "special counsel jack smith" - Google News | 3h | |
|
|
|
| Will Trump be arrested today? What you need to know - AL.com |
| Will Trump be arrested today? What you need to know AL.com |
 "special counsel jack smith" - Google News "special counsel jack smith" - Google News | 3h | |
|
|
|
| Former Vice President Mike Pence files motion to block Jan. 6 ... - Yahoo News |
| Former Vice President Mike Pence files motion to block Jan. 6 ... Yahoo News |
 "special counsel jack smith" - Google News "special counsel jack smith" - Google News | 3h | |
|
|
|
| Russian jet intercepts two US B-52 bombers moving towards its ... - Peoples Dispatch |
| Russian jet intercepts two US B-52 bombers moving towards its ... Peoples Dispatch |
 "donbass" - Google News "donbass" - Google News | 3h | |
|
|
|
| House clears COVID-19 intelligence measure - Roll Call |
| House clears COVID-19 intelligence measure Roll Call |
 "Avril Haines" - Google News "Avril Haines" - Google News | 3h | |
|
|
|
| The Marine Corps Needs to Modernize its Targeting Cycle—Here's ... - Modern... |
| The Marine Corps Needs to Modernize its Targeting Cycle—Here's ... Modern War Institute - |
 "Russia-Ukraine War: Lessons for the Electronic Warfare" - Google News "Russia-Ukraine War: Lessons for the Electronic Warfare" - Google News | 3h | |
|
|
|
| Ukraine war live updates: Xi invites Putin to China as talks continue; Russian mercenaries... |
| Ukraine war live updates: Xi invites Putin to China as talks continue; Russian mercenaries say Kyiv is... |
 "Putin and Xi" - Google News "Putin and Xi" - Google News | 3h | |
|
|
|
 | What Putin and Xi each get out of their "friendship" - Axios |
| Axios |
 "Putin and Xi" - Google News "Putin and Xi" - Google News | 3h | |
|
|
|
 | Putin, Xi discuss Chinese peace proposal for Ukraine as US ... - TODAY |
| TODAY |
 "Putin and Xi" - Google News "Putin and Xi" - Google News | 3h | |
|
|
|
| Putin, Xi discuss Chinese peace proposal for Ukraine in visit ... - Reuters |
| Putin, Xi discuss Chinese peace proposal for Ukraine in visit ... Reuters |
 "Putin and Xi" - Google News "Putin and Xi" - Google News | 3h | |
|
|
|
| Live updates: Xi Jinping, Vladimir Putin hold formal talks on Moscow visit day 2... |
| Live updates: Xi Jinping, Vladimir Putin hold formal talks on Moscow visit day 2 The Washington PostXi... |
 "Putin and Xi" - Google News "Putin and Xi" - Google News | 3h | |
|
|
|
 | 'He is my best friend': 10 years of strengthening ties between Putin and Xi - The... |
| The Guardian |
 "Putin and Xi" - Google News "Putin and Xi" - Google News | 3h | |
|
|
|
 | Xi invites Putin to visit China - Egypt Independent |
| Egypt Independent |
 "Putin and Xi" - Google News "Putin and Xi" - Google News | 3h | |
|
|
|
 | Putin hosts Xi in Moscow as alliance grows - Northwest Arkansas Democrat-Gazette |
| Northwest Arkansas Democrat-Gazette |
 "Putin and Xi" - Google News "Putin and Xi" - Google News | 3h | |
|
|
|
 | Xi, Putin meeting highlights US tensions with China - ABC News |
| ABC News |
 "Putin and Xi" - Google News "Putin and Xi" - Google News | 3h | |
|
|
|
 | China bills itself as a Ukraine peacemaker but US says Xi's talks with Putin provide... |
| CNN |
 "Putin and Xi" - Google News "Putin and Xi" - Google News | 3h | |
|
|
|
 | Ukraine war to dominate second day of Putin, Xi talks - RTE.ie |
| RTE.ie |
 "Putin and Xi" - Google News "Putin and Xi" - Google News | 3h | |
|
|
|
 | Putin-Xi Jinping meet: China seeks political solution to Ukraine crisis - Economic... |
| Economic Times |
 "Putin and Xi" - Google News "Putin and Xi" - Google News | 3h | |
|
|
|
 | Putin Xi Jinping: Western Australia Premier Mark McGowan weighs ... - WAtoday |
| WAtoday |
 "Putin and Xi" - Google News "Putin and Xi" - Google News | 3h | |
|
|
|
 | Hear what Chinese citizens think of Putin's war in Ukraine - CNN |
| CNN |
 "Putin and Xi" - Google News "Putin and Xi" - Google News | 3h | |
|
|
|
 | Putin to Xi: We will discuss your plan to end the war in Ukraine - BBC |
| BBC |
 "Putin and Xi" - Google News "Putin and Xi" - Google News | 3h | |
|
|
|
 | Putin and Xi finish first round of talks in Moscow as Blinken hits China's proposed... |
| Fox News |
 "Putin and Xi" - Google News "Putin and Xi" - Google News | 3h | |
|
|
|
 | China's Xi to Meet Putin as Beijing Seeks Bolder Global Role - The Diplomat |
| The Diplomat |
 "Putin and Xi" - Google News "Putin and Xi" - Google News | 3h | |
|
|
|
| Xi Jinping and Vladimir Putin shake hands in Moscow - BBC |
| Xi Jinping and Vladimir Putin shake hands in Moscow BBC |
 "Putin and Xi" - Google News "Putin and Xi" - Google News | 3h | |
|
|
|
 | Putin welcomes China's Xi to Kremlin amid Ukraine fighting ... - American Press |
| American Press |
 "Putin and Xi" - Google News "Putin and Xi" - Google News | 3h | |
|
|
|
 | Vladimir Putin welcomes Chinese leader Xi Jinping to Moscow amid ... - WABC-TV |
| WABC-TV |
 "Putin and Xi" - Google News "Putin and Xi" - Google News | 3h | |
|
|
|
 | Urgent: Xi meets Putin in Moscow - Xinhua |
| Xinhua |
 "Putin and Xi" - Google News "Putin and Xi" - Google News | 3h | |
|
|
|
 | China's Xi arrives in Moscow for first visit since Russia invaded Ukraine - CNN |
| CNN |
 "Putin and Xi" - Google News "Putin and Xi" - Google News | 3h | |
|
|
|
 | China's Xi makes 1st Moscow visit as Putin wages Ukraine war - Action News 5 |
| Action News 5 |
 "Putin and Xi" - Google News "Putin and Xi" - Google News | 3h | |
|
|
|
 | China, Russia relations: leaders Xi, Putin to meet - CP24 |
| CP24 |
 "Putin and Xi" - Google News "Putin and Xi" - Google News | 3h | |
|
|
|
 | Ukraine War: Putin, Xi Launch Talks in Kremlin - The Moscow Times |
| The Moscow Times |
 "Putin and Xi" - Google News "Putin and Xi" - Google News | 3h | |
|
|
|
 | On eve of Xi visit, Putin welcomes Chinese role in Ukraine crisis - The Business... |
| The Business Standard |
 "Putin and Xi" - Google News "Putin and Xi" - Google News | 3h | |
|
|
|
 | Putin to welcome China's Xi to Moscow at critical moment - The Business Standard |
| The Business Standard |
 "Putin and Xi" - Google News "Putin and Xi" - Google News | 3h | |
|
|
|
 | China's Xi to meet with Putin in Moscow Monday in show of support - WBAL Radio |
| WBAL Radio |
 "Putin and Xi" - Google News "Putin and Xi" - Google News | 3h | |
|
|
|
 | Uyghur group calls on ICC to arrest Chinese president Xi Jinping after Putin warrant... |
| Yahoo News |
 "Putin and Xi" - Google News "Putin and Xi" - Google News | 3h | |
|
|
|
 | China's Xi to meet Putin next week in first visit to Russia since ... - Egypt Independent |
| Egypt Independent |
 "Putin and Xi" - Google News "Putin and Xi" - Google News | 3h | |
|
|
|
 | Putin, Xi to declare 'new era' for ties, discuss Ukraine - The Business Standard |
| The Business Standard |
 "Putin and Xi" - Google News "Putin and Xi" - Google News | 3h | |
|
|
|
| Shugaba Xi zai tattauna da Putin a Moscow a makon gobe - BBC |
| Shugaba Xi zai tattauna da Putin a Moscow a makon gobe BBC |
 "Putin and Xi" - Google News "Putin and Xi" - Google News | 3h | |
|
|
|
 | Chinese President Xi to meet with Russia's Vladimir Putin - KRCR |
| KRCR |
 "Putin and Xi" - Google News "Putin and Xi" - Google News | 3h | |
|
|
|
 | President Xi Jinping to hold talks with Russian President Vladimir ... - Sky News... |
| Sky News Australia |
 "Putin and Xi" - Google News "Putin and Xi" - Google News | 3h | |
|
|
|
 | Taiwan is feeling the pressure from Russian and Chinese autocracy - Brookings Institution |
| Brookings Institution |
 "Putin and Xi" - Google News "Putin and Xi" - Google News | 3h | |
|
|
|
 | Putin congratulates China's Xi on third term, praises 'strategic cooperation' - Fox... |
| Fox News |
 "Putin and Xi" - Google News "Putin and Xi" - Google News | 3h | |
|
|
|
 | China and Russia have deep defense sector ties. Putin's war has not changed that,... |
| CNN |
 "Putin and Xi" - Google News "Putin and Xi" - Google News | 3h | |
|
|
|
 | Decoder: The West looks on as Putin pals with Xi Jinping - News-Decoder |
| News-Decoder |
 "Putin and Xi" - Google News "Putin and Xi" - Google News | 3h | |
|
|
|
 | Putin ally Lukashenko and Chinese leader Xi Jinping vow to deepen defense ties -... |
| CNN |
 "Putin and Xi" - Google News "Putin and Xi" - Google News | 3h | |
|
|
|
 | Russia's War in Ukraine Is Putting Xi and China on the Spot | WPR - World Politics... |
| World Politics Review |
 "Putin and Xi" - Google News "Putin and Xi" - Google News | 3h | |
|
|
|
 | The Limits of the No-Limits Partnership: China and Russia Can't Be ... - Foreign... |
| Foreign Affairs Magazine |
 "Putin and Xi" - Google News "Putin and Xi" - Google News | 3h | |
|
|
|
 | Paul deLespinasse: A radical idea for Putin and Xi - The Daily Telegram |
| The Daily Telegram |
 "Putin and Xi" - Google News "Putin and Xi" - Google News | 3h | |
|
|
|
 | Will Russia's struggle in Ukraine help Taiwan — or hurt it? - Al Jazeera English |
| Al Jazeera English |
 "Putin and Xi" - Google News "Putin and Xi" - Google News | 3h | |
|
|
|
 | Xi Jinping to visit Moscow for summit with Putin: Report - Al Jazeera English |
| Al Jazeera English |
 "Putin and Xi" - Google News "Putin and Xi" - Google News | 3h | |
|
|
|
 | Biden calls nuclear treaty suspension a 'big mistake'; Putin courts Beijing ahead... |
| CNBC |
 "Putin and Xi" - Google News "Putin and Xi" - Google News | 3h | |
|
|
|
 | There are many reasons why China may not be in a hurry to see Russia's war in Ukraine... |
| CNN |
 "Putin and Xi" - Google News "Putin and Xi" - Google News | 3h | |
|
|
|
| The Rising Costs of China's Bet on Putin - Bloomberg |
| The Rising Costs of China's Bet on Putin Bloomberg |
 "Putin and Xi" - Google News "Putin and Xi" - Google News | 3h | |
|
|
|
 | Pressuring Xi Jinping risks creating 'another Putin' - Nikkei Asia |
| Nikkei Asia |
 "Putin and Xi" - Google News "Putin and Xi" - Google News | 3h | |
|
|
|
| Ukraine War: Costs of Xi's Friendship With Putin Are Rising - Bloomberg |
| Ukraine War: Costs of Xi's Friendship With Putin Are Rising Bloomberg |
 "Putin and Xi" - Google News "Putin and Xi" - Google News | 3h | |
|
|
|
 | Opinion: Break up the Vladimir Putin-Xi Jinping 'no limits' partnership - CNN |
| CNN |
 "Putin and Xi" - Google News "Putin and Xi" - Google News | 3h | |
|
|
|
 | Meeting between Xi and Putin must have realistic expectations - South China Morning... |
| South China Morning Post |
 "Putin and Xi" - Google News "Putin and Xi" - Google News | 3h | |
|
|
|
 | Beyond the Putin-Xi Relationship: China, Russia, and Great Power ... - The Diplomat |
| The Diplomat |
 "Putin and Xi" - Google News "Putin and Xi" - Google News | 3h | |
|
|
|
 | China's Xi Jinping To Visit Putin, Russian Ministry Says - TIME |
| TIME |
 "Putin and Xi" - Google News "Putin and Xi" - Google News | 3h | |
|
|
|
 | The Democracy vs Autocracy Battle May Finally End in 2023 | WPR - World Politics... |
| World Politics Review |
 "Putin and Xi" - Google News "Putin and Xi" - Google News | 3h | |
|
|
|
 | Retired general: A weak Russia would be satisfying for Xi - CNN |
| CNN |
 "Putin and Xi" - Google News "Putin and Xi" - Google News | 3h | |
|
|
|
 | Putin and Xi meet against backdrop of growing crises for both leaders - CNN |
| CNN |
 "Putin and Xi" - Google News "Putin and Xi" - Google News | 3h | |
|
|
|
 | How China Is Using Vladimir Putin - The Atlantic |
| The Atlantic |
 "Putin and Xi" - Google News "Putin and Xi" - Google News | 3h | |
|
|
|
 | Russia's Putin and China's Xi to confer this week - TASS quotes ... - Reuters |
| Reuters |
 "Putin and Xi" - Google News "Putin and Xi" - Google News | 3h | |
|
|
|
 | Analysis | Are Putin and Xi in Decline? Populism and Autocracy Still ... - The Washington... |
| The Washington Post |
 "Putin and Xi" - Google News "Putin and Xi" - Google News | 3h | |
|
|
|
 | Medvedev Discusses Strategic Partnership, Ukraine War With ... - The Moscow Times |
| The Moscow Times |
 "Putin and Xi" - Google News "Putin and Xi" - Google News | 3h | |
|
|
|
 | 2022 was a bad year for Putin, Xi, and other global bad guys - Vox.com |
| Vox.com |
 "Putin and Xi" - Google News "Putin and Xi" - Google News | 3h | |
|
|
|
 | Putin, Xi to hold talks by year-end - Vedomosti - Reuters |
| Reuters |
 "Putin and Xi" - Google News "Putin and Xi" - Google News | 3h | |
|
|
|
| China's Xi Doesn't Want to Follow the Russia's Putin into Diplomatic ... - Bloomberg |
| China's Xi Doesn't Want to Follow the Russia's Putin into Diplomatic ... Bloomberg |
 "Putin and Xi" - Google News "Putin and Xi" - Google News | 3h | |
|
|
|
 | Kevin Rudd: Xi thinks Putin is a "dummy" - GZERO Media |
| GZERO Media |
 "Putin and Xi" - Google News "Putin and Xi" - Google News | 3h | |
|
|
|
 | Pentagon: Xi and Putin 'edging toward an alliance' - Defense News |
| Defense News |
 "Putin and Xi" - Google News "Putin and Xi" - Google News | 3h | |
|
|
|
 | China's Xi warns Putin not to use nuclear arms in Ukraine - POLITICO Europe |
| POLITICO Europe |
 "Putin and Xi" - Google News "Putin and Xi" - Google News | 3h | |
|
|
|
 | How Putin and Xi Are Trying to Break Global Human Rights - Foreign Policy |
| Foreign Policy |
 "Putin and Xi" - Google News "Putin and Xi" - Google News | 3h | |
|
|
|
| Putin says China's Xi is 'close friend', hails 'unprecedented ... - Reuters |
| Reuters |
 "Putin and Xi" - Google News "Putin and Xi" - Google News | 3h | |
|
|
|
 | Putin congratulates China's Xi on unprecedented third term - Reuters |
| Reuters |
 "Putin and Xi" - Google News "Putin and Xi" - Google News | 3h | |
|
|
|
 | How Far Will Xi Go to Help a Desperate Putin? - Foreign Policy |
| Foreign Policy |
 "Putin and Xi" - Google News "Putin and Xi" - Google News | 3h | |
|
|
|
 | Think Putin is a global threat? Then we need to talk about Xi Jinping ... - The Guardian |
| The Guardian |
 "Putin and Xi" - Google News "Putin and Xi" - Google News | 3h | |
|
|
|
 | Putin, Xi Meets In Samarkand: China Is Russia's Senior Partner - Warsaw Institute |
| Warsaw Institute |
 "Putin and Xi" - Google News "Putin and Xi" - Google News | 3h | |
|
|
|
 | Modi, Putin and Xi Join the SCO Summit Amid Turbulent Times - United States Institute... |
| United States Institute of Peace |
 "Putin and Xi" - Google News "Putin and Xi" - Google News | 3h | |
|
|
|
 | The Xi-Putin Alliance Is Dead, Long Live The Xi-Putin Alliance - Worldcrunch |
| Worldcrunch |
 "Putin and Xi" - Google News "Putin and Xi" - Google News | 3h | |
|
|
|
 | Putin, Xi and the limits of friendship - Financial Times |
| Financial Times |
 "Putin and Xi" - Google News "Putin and Xi" - Google News | 3h | |
|
|
|
 | Putin concedes China has 'questions and concerns' over Russia's faltering invasion... |
| CNN |
 "Putin and Xi" - Google News "Putin and Xi" - Google News | 3h | |
|
|
|
 | Vladimir Putin and Xi Jinping: An increasingly unequal relationship - BBC |
| BBC |
 "Putin and Xi" - Google News "Putin and Xi" - Google News | 3h | |
|
|
|
 | Putin and Xi to meet at summit of authoritarian states that will embrace Iran - The... |
| The Independent |
 "Putin and Xi" - Google News "Putin and Xi" - Google News | 3h | |
|
|
|
 | Putin needs Xi Jinping's help more than ever after his setbacks in Ukraine - CNN |
| CNN |
 "Putin and Xi" - Google News "Putin and Xi" - Google News | 3h | |
|
|
|
 | Putin and Xi to meet in Uzbekistan next week, official says - CNBC |
| CNBC |
 "Putin and Xi" - Google News "Putin and Xi" - Google News | 3h | |
|
|
|
 | VIDEO: Trump praises Putin, applauds Xi for 'iron fist' at Pennsylvania rally - Business... |
| Business Insider |
 "Putin and Xi" - Google News "Putin and Xi" - Google News | 3h | |
|
|
|
 | Are Vladimir Putin and Xi Jinping Two of a Kind? – PRIO Blogs - Peace Research Institute... |
| Peace Research Institute Oslo |
 "Putin and Xi" - Google News "Putin and Xi" - Google News | 3h | |
|
|
|
 | Putin, Xi will attend G20 summit, Indonesian president says - POLITICO Europe |
| POLITICO Europe |
 "Putin and Xi" - Google News "Putin and Xi" - Google News | 3h | |
|
|
|
 | Putin and Xi to attend G20 summit, Indonesian president says, setting up showdown... |
| CNN |
 "Putin and Xi" - Google News "Putin and Xi" - Google News | 3h | |
|
|
|
 | Russia is becoming increasingly dependent on China - The Washington Post |
| The Washington Post |
 "Putin and Xi" - Google News "Putin and Xi" - Google News | 3h | |
|
|
|
 | The Banality of Putin and Xi - New Ideal |
| New Ideal |
 "Putin and Xi" - Google News "Putin and Xi" - Google News | 3h | |
|
|
|
 | China will support Russia on security, Xi tells Putin in birthday call - CNN |
| CNN |
 "Putin and Xi" - Google News "Putin and Xi" - Google News | 3h | |
|
|
|
| Xi talks with Putin over phone - MFA China |
| Xi talks with Putin over phone MFA China |
 "Putin and Xi" - Google News "Putin and Xi" - Google News | 3h | |
|
|
|
 | China and Russia: Exploring Ties Between Two Authoritarian Powers - Council on Foreign... |
| Council on Foreign Relations |
 "Putin and Xi" - Google News "Putin and Xi" - Google News | 3h | |
|
|
|
 | Xi Jinping Suffers From the Putin Effect - The Diplomat |
| The Diplomat |
 "Putin and Xi" - Google News "Putin and Xi" - Google News | 3h | |
|
|
|
 | What It Will Look Like if Trump Gets Arrested |
| Trump In Jail? Many political observers have been imagining for many years what it might look like if... |
 19FortyFive 19FortyFive | 3h | |
|
|
|
| Following Pope Francis - Monadnock Ledger Transcript |
| Following Pope Francis Monadnock Ledger Transcript |
 "pope francis" - Google News "pope francis" - Google News | 3h | |
|
|
|
| Judge: Trump's lawyer to face more Mar-a-Lago questions - The San Gabriel Valley... |
| Judge: Trump's lawyer to face more Mar-a-Lago questions The San Gabriel Valley Tribune |
 "Mar-a-Lago" - Google News "Mar-a-Lago" - Google News | 3h | |
|
|
|
| Japanese PM Kishida offers Ukraine support as China's president ... - The Irish News |
| Japanese PM Kishida offers Ukraine support as China's president ... The Irish News |
 "G7 and Russia Ukraine war" - Google News "G7 and Russia Ukraine war" - Google News | 3h | |
|
|
|
| Japan PM Kishida visits Bucha in 'historic' Ukraine trip - Kalkine Media |
| Japan PM Kishida visits Bucha in 'historic' Ukraine trip Kalkine Media |
 "G7 and Russia Ukraine war" - Google News "G7 and Russia Ukraine war" - Google News | 3h | |
|
|
|
| Seven out of 30 allies met NATO military spending target in 2022 -Stoltenberg - Yahoo... |
| Seven out of 30 allies met NATO military spending target in 2022 -Stoltenberg Yahoo Finance |
 "Stoltenberg" - Google News "Stoltenberg" - Google News | 3h | |
|
|
|
| GOP Senator John Cornyn Tweaks DeSantis Again, Touts Zelensky's 'Answer' on Ukraine... |
| GOP Senator John Cornyn Tweaks DeSantis Again, Touts Zelensky's 'Answer' on Ukraine Aid for Him Mediaite |
 "Zelensky" - Google News "Zelensky" - Google News | 3h | |
|
|
|
| Newly released Chinese Covid data points to infected animals in Wuhan - The Guardian |
| Newly released Chinese Covid data points to infected animals in Wuhan The GuardianChinese COVID data... |
 "COVID" - Google News "COVID" - Google News | 3h | |
|
|
|
| First-of-Its-Kind Post-COVID-19 Panels Available at questhealth.com - Yahoo Finance |
| First-of-Its-Kind Post-COVID-19 Panels Available at questhealth.com Yahoo Finance |
 "COVID" - Google News "COVID" - Google News | 3h | |
|
|
|
| Biden orders release of intelligence on COVID origins - Yahoo News |
| Biden orders release of intelligence on COVID origins Yahoo News |
 "COVID" - Google News "COVID" - Google News | 3h | |
|
|
|
| COVID long haulers have enlarged brain stems - Health Imaging |
| COVID long haulers have enlarged brain stems Health Imaging |
 "COVID" - Google News "COVID" - Google News | 3h | |
|
|
|
| How the war in Ukraine is driving growth in Arkansas – Defense News |
| How the war in Ukraine is driving growth in Arkansas Defense News The post How the war in Ukraine is... |
 Russia - Ukraine War | The Russia News Russia - Ukraine War | The Russia News | 3h | |
|
|
|
| US Announces More Weapons for Ukraine – World news – Tasnim … – Tasnim News Agency |
| US Announces More Weapons for Ukraine – World news – Tasnim … Tasnim News Agency The post US Announces... |
 Russia - Ukraine War | The Russia News Russia - Ukraine War | The Russia News | 3h | |
|
|
|
| Yevgeny Prigozhin: Putin's warlord planned to sue BBC with UK lawyers' help – openDemocracy |
| Yevgeny Prigozhin: Putin's warlord planned to sue BBC with UK lawyers' help openDemocracy The post... |
 Russia - Ukraine War | The Russia News Russia - Ukraine War | The Russia News | 3h | |
|
|
|
| Germany to put 2 percent NATO spending pledge in writing – POLITICO Europe |
| Germany to put 2 percent NATO spending pledge in writing POLITICO Europe The post Germany to put 2... |
 Russia - Ukraine War | The Russia News Russia - Ukraine War | The Russia News | 3h | |
|
|
|
| Xi and Putin Rekindle 'Strategic Bromance' in Russia – The Wall Street Journal |
| Xi and Putin Rekindle 'Strategic Bromance' in Russia The Wall Street Journal The post Xi and Putin... |
 Russia - Ukraine War | The Russia News Russia - Ukraine War | The Russia News | 3h | |
|
|
|
| Japanese Premier Visits Kyiv as Ukraine War Divides Asia – The Wall Street Journal |
| Japanese Premier Visits Kyiv as Ukraine War Divides Asia The Wall Street Journal The post Japanese... |
 Russia - Ukraine War | The Russia News Russia - Ukraine War | The Russia News | 3h | |
|
|
|
| Republicans quietly drop House investigation into Trump finances - AOL |
| Republicans quietly drop House investigation into Trump finances AOL |
 "Gen. Gerasimov was wounded" - Google News "Gen. Gerasimov was wounded" - Google News | 3h | |
|
|
|
| Some Trump supporters ambivalent on calls for protests - Fulton Sun |
| Some Trump supporters ambivalent on calls for protests Fulton Sun |
 "Mar-a-Lago documents" - Google News "Mar-a-Lago documents" - Google News | 3h | |
|
|
|
| Japan, China Push Opposing Visions in Top-Level Visits - U.S. News & World Report |
| Japan, China Push Opposing Visions in Top-Level Visits U.S. News & World Report |
 "global threats to U.S. security 2023" - Google News "global threats to U.S. security 2023" - Google News | 3h | |
|
|
|
| Italy pledges cash to support Tunisia amid uncertainty - Arab News |
| Italy pledges cash to support Tunisia amid uncertainty Arab News |
 "Israel and Russia- Ukraine war 2022" - Google News "Israel and Russia- Ukraine war 2022" - Google News | 3h | |
|
|
|
| Explainer: What are the 12-points in China's peace proposal - The Business Standard |
| Explainer: What are the 12-points in China's peace proposal The Business Standard |
 "Israel and Russia- Ukraine war 2022" - Google News "Israel and Russia- Ukraine war 2022" - Google News | 3h | |
|
|
|
| Your Evening Brief – Bangladesh maintains close ties with all – China, US and India:... |
| Your Evening Brief – Bangladesh maintains close ties with all – China, US and India: PM Hasina tells... |
 "Israel and Russia- Ukraine war 2022" - Google News "Israel and Russia- Ukraine war 2022" - Google News | 3h | |
|
|
|
| International Criminal Court Issues Arrest Warrant for Putin - The New York Times |
| International Criminal Court Issues Arrest Warrant for Putin The New York Times |
 "Putin in Beijing" - Google News "Putin in Beijing" - Google News | 3h | |
|
|
|
| China's Xi to meet Putin as Beijing seeks bolder global role - Caledonian Record |
| China's Xi to meet Putin as Beijing seeks bolder global role Caledonian Record |
 "Putin in Beijing" - Google News "Putin in Beijing" - Google News | 3h | |
|
|
|
| Rare Planetary Parade To Be Seen Above the Hudson Valley - wpdh.com |
| Rare Planetary Parade To Be Seen Above the Hudson Valley wpdh.com |
 "project raven" - Google News "project raven" - Google News | 3h | |
|
|
|
| DC's Justice League: Cosmic Chaos Review - TheXboxHub |
| DC's Justice League: Cosmic Chaos Review TheXboxHub |
 "project raven" - Google News "project raven" - Google News | 3h | |
|
|
|
| In the Book Ban Era, Queer Representation on Kids' TV Is More Important Than Ever... |
| In the Book Ban Era, Queer Representation on Kids' TV Is More Important Than Ever Them |
 "project raven" - Google News "project raven" - Google News | 3h | |
|
|
|
 | U.S. seeks to prevent China from benefiting from $52 billion chips funding |
| 2023-03-21T13:16:31ZFlags of China and U.S. are displayed on a printed circuit board with semiconductor... |
 Reuters Reuters | 3h | |
|
|
|
| How the war in Ukraine is driving growth in Arkansas - Defense News |
| How the war in Ukraine is driving growth in Arkansas Defense News |
 "Ukraine" - Google News "Ukraine" - Google News | 3h | |
|
|
|
| Russia's Vladimir Putin welcomes China's Xi Jinping to Moscow amid Ukraine war -... |
| Russia's Vladimir Putin welcomes China's Xi Jinping to Moscow amid Ukraine war KFSN-TV |
 "International criminal court issues arrest warrant for Putin" - Google News "International criminal court issues arrest warrant for Putin" - Google News | 3h | |
|
|
|
| Ukraine-Russia news – live: Putin hails China's 'constructive role' in war ahead... |
| Ukraine-Russia news – live: Putin hails China's 'constructive role' in war ahead of Xi Jinping visit The... |
 "International criminal court issues arrest warrant for Putin" - Google News "International criminal court issues arrest warrant for Putin" - Google News | 3h | |
|
|
|
| Japan's PM offers Ukraine support as China's Xi backs Russia - Detroit News |
| Japan's PM offers Ukraine support as China's Xi backs Russia Detroit News |
 "Bucha" - Google News "Bucha" - Google News | 3h | |
|
|
|
| Signature Gatherers Targeted in Bill to Curb Business Use of Ballot Process - gvwire.com |
| Signature Gatherers Targeted in Bill to Curb Business Use of Ballot Process gvwire.com |
 "Putin seeks foreign volunteers" - Google News "Putin seeks foreign volunteers" - Google News | 3h | |
|
|
|
| Putin has made a surprise visit to the occupied city of Mariupol in Ukraine - KGOU |
| Putin has made a surprise visit to the occupied city of Mariupol in Ukraine KGOU |
 "russia - ukraine war 2022" - Google News "russia - ukraine war 2022" - Google News | 3h | |
|
|
|
 | How war crimes prosecutions work - Kansas City - KMBC Kansas City |
| KMBC Kansas City |
 "russia - ukraine war 2022" - Google News "russia - ukraine war 2022" - Google News | 3h | |
|
|
|
| |
| The Pentagon is speeding up its delivery of Abrams tanks to Ukraine, opting to send a refurbished older... |
 The Associated Press (Twitter) The Associated Press (Twitter) | 3h | |
|
|
|
| |
| The Associated Press retweeted: Wildlife officials say they're searching... |
 The Associated Press (Twitter) The Associated Press (Twitter) | 3h | |
|
|
|
| |
| "We're all still in shock." Keanu Reeves and Laurence Fishburne were among the "John Wick: Chapter 4"... |
 The Associated Press (Twitter) The Associated Press (Twitter) | 3h | |
|
|
|
 | |
| The Associated Press retweeted: The White House press briefing featuring... |
 The Associated Press (Twitter) The Associated Press (Twitter) | 3h | |
|
|
|
| Kyiv says it is frustrated with pace of delivery on Israeli promises - The Times... |
| Kyiv says it is frustrated with pace of delivery on Israeli promises The Times of Israel |
 "kyiv" - Google News "kyiv" - Google News | 3h | |
|
|
|
| Japan PM Kishida arrives in Kyiv for talks with Zelenskyy - Deccan Herald |
| Japan PM Kishida arrives in Kyiv for talks with Zelenskyy Deccan Herald |
 "kyiv" - Google News "kyiv" - Google News | 3h | |
|
|
|
| Japanese leader arrives in Kyiv as China's Xi visits Russia - The Killeen Daily Herald |
| Japanese leader arrives in Kyiv as China's Xi visits Russia The Killeen Daily Herald |
 "kyiv" - Google News "kyiv" - Google News | 3h | |
|
|
|
| The Kyiv Independent to launch 'Ukraine's True History' project - Yahoo News |
| The Kyiv Independent to launch 'Ukraine's True History' project Yahoo News |
 "kyiv" - Google News "kyiv" - Google News | 3h | |
|
|
|
| Russia Accuses Kyiv of Drone Strike on Oil Facility Near Border - The Moscow Times |
| Russia Accuses Kyiv of Drone Strike on Oil Facility Near Border The Moscow Times |
 "kyiv" - Google News "kyiv" - Google News | 3h | |
|
|
|
| Russia's war in Ukraine: Live updates - CNN International |
| Russia's war in Ukraine: Live updates CNN International |
 "kyiv" - Google News "kyiv" - Google News | 3h | |
|
|
|
| Japan PM Kishida Arrives in Kyiv for Talks With Zelenskiy - U.S. News & World Report |
| Japan PM Kishida Arrives in Kyiv for Talks With Zelenskiy U.S. News & World Report |
 "kyiv" - Google News "kyiv" - Google News | 3h | |
|
|
|
| How the war in Ukraine is driving growth in Arkansas - C4ISRNET |
| How the war in Ukraine is driving growth in Arkansas C4ISRNET |
 "weapons for ukraine" - Google News "weapons for ukraine" - Google News | 3h | |
|
|
|
| Xi, Putin meet amid fears of sending lethal weapons - WCAX |
| Xi, Putin meet amid fears of sending lethal weapons WCAX |
 "weapons for ukraine" - Google News "weapons for ukraine" - Google News | 3h | |
|
|
|
| Emirates passenger awarded almost £7,000 after complaining about 'worn out' seat... |
| Emirates passenger awarded almost £7,000 after complaining about 'worn out' seat on plane Yahoo News... |
 "covid -19 origins" - Google News "covid -19 origins" - Google News | 3h | |
|
|
|
| 'Significant increase' in online threats as potential Trump indictment looms – live... |
| 'Significant increase' in online threats as potential Trump indictment looms – live The Guardian US |
 trump - Google News trump - Google News | 3h | |
|
|
|
| He used to be the Assistant DA in Manhattan. Hear how likely he thinks a Trump arrest... |
| He used to be the Assistant DA in Manhattan. Hear how likely he thinks a Trump arrest is CNN |
 trump - Google News trump - Google News | 3h | |
|
|
|
| Dismal Crowd At NYC Trump Rally Despite Ex-Prez's Call For Action As Arrest Looms... |
| Dismal Crowd At NYC Trump Rally Despite Ex-Prez's Call For Action As Arrest Looms HuffPost |
 trump - Google News trump - Google News | 3h | |
|
|
|
 | Wisconsin Is the Most Important Race in the Country in 2023 |
| Commentary Actress Julia Louis-Dreyfus tweeted seemingly out of nowhere last week about the Wisconsin... |
 The Epoch Times | The Epoch Times The Epoch Times | The Epoch Times | 3h | |
|
|
|
| Recovering teacher shot by 6-year-old: 'It's changed me' |
| |
 All Stories All Stories | 3h | |
|
|
|
| Paul Newman's camp for sick kids rises from the ashes |
| |
 All Stories All Stories | 3h | |
|
|
|
| Montana House passes bill bolstering sex assault investigations - Missoula Current |
| Montana House passes bill bolstering sex assault investigations Missoula Current |
 "Election 2016 Investigations" - Google News "Election 2016 Investigations" - Google News | 3h | |
|
|
|
| Mudbugs travel to Odessa after shutting out Rhinos - KTALnews.com |
| Mudbugs travel to Odessa after shutting out Rhinos KTALnews.com |
 "Odessa" - Google News "Odessa" - Google News | 3h | |
|
|
|
| Air Curtain Market Size, Share, Growth Analysis, and Forecast 2029 ... - Digital... |
| Air Curtain Market Size, Share, Growth Analysis, and Forecast 2029 ... Digital Journal |
 "Intelligence Assessments of Russia Ukraine War 2022" - Google News "Intelligence Assessments of Russia Ukraine War 2022" - Google News | 3h | |
|
|
|
| Machine Learning Chips Market Size in 2023 with [ STATISTICS ... - Digital Journal |
| Machine Learning Chips Market Size in 2023 with [ STATISTICS ... Digital Journal |
 "Intelligence Assessments of Russia Ukraine War 2022" - Google News "Intelligence Assessments of Russia Ukraine War 2022" - Google News | 3h | |
|
|
|
| Ransomware 'likely' to target transportation OT systems, warns EU ... - The Record... |
| Ransomware 'likely' to target transportation OT systems, warns EU ... The Record by Recorded Future |
 "Intelligence Assessments of Russia Ukraine War 2022" - Google News "Intelligence Assessments of Russia Ukraine War 2022" - Google News | 3h | |
|
|
|
| Should City Councils Draw Their Own Election Districts? Irvine Discusses Bucking... |
| Should City Councils Draw Their Own Election Districts? Irvine Discusses Bucking The Trend Voice of... |
 "twitter down" - Google News "twitter down" - Google News | 3h | |
|
|
|
| Paul Newman's camp for sick kids rises from the ashes |
| AP correspondent Donna Warder reports on the opening of a rebuilt creative center at Paul Newman's camp... |
 AP Audio Wire AP Audio Wire | 3h | |
|
|
|
 | Apaches get new chance to argue mine will harm sacred sites |
| PHOENIX (AP) — An Apache group battling a foreign mining firm that wants to build one of the largest... |
 Associated Press News: Breaking News | Latest News Today Associated Press News: Breaking News | Latest News Today | 3h | |
|
|
|
| Tuesday’s Top Analyst Upgrades and Downgrades: Conagra, Dell, Dow, EA, HPE,... |
| The futures traded up on Tuesday, after a bounce-back Monday that saw all the major indexes finish the... |
 Markets and Business News Review Markets and Business News Review | 3h | |
|
|
|
 | The Real Culture Wars Are Over Food |
| Restrictive food policies run counter culture to those who defend their right to eat anything. |
 Markets and Business News Review Markets and Business News Review | 3h | |
|
|
|
 | Biodiversity May Suffer From Some Climate Initiatives, Climate Czar Says |
| Solutions to the world's converging environmental crises may not always align, the Biden Administration's... |
 Markets and Business News Review Markets and Business News Review | 3h | |
|
|
|
 | Kingfisher Profits Slump 39% As Retailer Suffers Following Covid Reopening |
| Pre-tax profits dive as sales drop and the costs of expansion weigh. |
 Markets and Business News Review Markets and Business News Review | 3h | |
|
|
|
 | Treasury Explores Emergency Powers To Expand FDIC Coverage Amid Contagion Concerns,... |
| The move to expand FDIC protections to cover all deposits in U.S. banks is likely to face pushback from... |
 Markets and Business News Review Markets and Business News Review | 3h | |
|
|
|
 | Milwaukee Bucks Have Difficult Decisions To Make On The Wing |
| The Milwaukee Bucks have an embarrassment of riches on the wing, as they feature half a dozen players... |
 Markets and Business News Review Markets and Business News Review | 3h | |
|
|
|
 | New England Patriots Bought Into JuJu Smith-Schuster's Trajectory At The Right Time |
| JuJu Smith-Schuster exceeded the base value of his one-year contract with the Kansas City Chiefs on the... |
 Markets and Business News Review Markets and Business News Review | 3h | |
|
|
|
 | Still A Smash: 'Ted Lasso' Season 3 Premiere Sets Viewership Record |
| The debut of the new season on AppleTV+ soared by 60% compared to season 2's first episode, becoming... |
 Markets and Business News Review Markets and Business News Review | 3h | |
|
|
|
 | Do You Hear Me, Or Are You Just Listening? |
| Listening is more than just about hearing words; it's about understanding what the speaker is saying... |
 Markets and Business News Review Markets and Business News Review | 3h | |
|
|
|
| Exclusive: Virginia teacher Abigail Zwerner sprung into action after being shot:... |
| Exclusive: Virginia teacher Abigail Zwerner sprung into action after being shot: 'I just wanted to get... |
 Markets and Business News Review Markets and Business News Review | 3h | |
|
|
|
 | The Rise Of Jacksepticeye: How One Of The World's Richest YouTubers Became A Coffee... |
| Seán McLoughlin, the Irish YouTuber better known as "Jacksepticeye," has become a household name for... |
 Markets and Business News Review Markets and Business News Review | 3h | |
|
|
|
| ICC arrest warrants against Putin: what do experts say? - JusticeInfo.net |
| ICC arrest warrants against Putin: what do experts say? JusticeInfo.net |
 "Will Russia turn to the West?" - Google News "Will Russia turn to the West?" - Google News | 3h | |
|
|
|
 | 'Culture Wars' Come to Ontario Law Society Election |
| In the run-up to the Ontario law society's election in April, a group of lawyers is taking a stand against... |
 The Epoch Times | The Epoch Times The Epoch Times | The Epoch Times | 3h | |
|
|
|
 | Scandinavian Activist Who Wanted to Burn Quran in Wakefield Refused Entry Into UK |
| The British government has banned a Scandinavian politician from entering the country after he announced... |
 The Epoch Times | The Epoch Times The Epoch Times | The Epoch Times | 3h | |
|
|
|
 | LIVE 11:15 AM ET: House GOP Retreat Day 3: Speaker McCarthy and House Republicans... |
| On day 3 of the U.S. House Republicans' retreat, House Republicans' leadership and other lawmakers hold... |
 The Epoch Times | The Epoch Times The Epoch Times | The Epoch Times | 3h | |
|
|
|
 | Southern India | Tough Rides Season 2 Ep4 |
| On their journey down the Indian southwest coast, the Pyle brothers visit Mahindra's mega car factory,... |
 The Epoch Times | The Epoch Times The Epoch Times | The Epoch Times | 3h | |
|
|
|
 | Michigan Is Headed Back to Rust Belt Poverty |
| Commentary Since the early days of Henry Ford, Michigan was the proud symbol of America's industrial... |
 The Epoch Times | The Epoch Times The Epoch Times | The Epoch Times | 3h | |
|
|
|
 | China Will Wage Full-Scale 'Unrestricted' War Against US as Long as CCP in Power:... |
| As long as China is ruled by the Chinese Communist Party (CCP), it will wage full-scale constant war... |
 The Epoch Times | The Epoch Times The Epoch Times | The Epoch Times | 3h | |
|
|
|
| CDC Warns of Dangerous Fungal Infection Spreading Through US at 'Alarming Rate' |
| The Centers for Disease Control and Prevention (CDC) is warning of an increasingly drug-resistant emerging... |
 The Epoch Times | The Epoch Times The Epoch Times | The Epoch Times | 3h | |
|
|
|
 | California Gov. Newsom Unveils New Plan to Curb Oil Profits, Create Gas Price Watchdog |
| California Gov. Gavin Newsom released a new proposal on March 20 aimed at limiting how much profit large... |
 The Epoch Times | The Epoch Times The Epoch Times | The Epoch Times | 3h | |
|
|
|
 | UK Government Stands by Windsor Framework Deal on Brexit Despite DUP Objection |
| The UK government has no plans to seek changes to its new agreement with the EU on post-Brexit trading... |
 The Epoch Times | The Epoch Times The Epoch Times | The Epoch Times | 3h | |
|
|
|
 | Taxes Take Some of the Blame for High Grocery Prices, MPs Told |
| A committee studying high food prices in Canada heard that grocery store profits are not the villains... |
 The Epoch Times | The Epoch Times The Epoch Times | The Epoch Times | 3h | |
|
|
|
| US Announces More Weapons for Ukraine - World news - Tasnim ... - Tasnim News Agency |
| US Announces More Weapons for Ukraine - World news - Tasnim ... Tasnim News Agency |
 "donbass" - Google News "donbass" - Google News | 3h | |
|
|
|
| Trump Calls the Latest Special Counsel a 'Monster.' His Lawyer Used to Call Him a... |
| Trump Calls the Latest Special Counsel a 'Monster.' His Lawyer Used to Call Him a Friend Yahoo News |
 "special counsel jack smith" - Google News "special counsel jack smith" - Google News | 3h | |
|
|
|
| CIA chief: China has some doubt on ability to invade Taiwan - The Business Standard |
| CIA chief: China has some doubt on ability to invade Taiwan The Business Standard |
 "CIA Burns in Moscow" - Google News "CIA Burns in Moscow" - Google News | 3h | |
|
|
|
| Xi and Putin Rekindle 'Strategic Bromance' in Russia - The Wall Street Journal |
| Xi and Putin Rekindle 'Strategic Bromance' in Russia The Wall Street Journal |
 "Scholz and Putin" - Google News "Scholz and Putin" - Google News | 3h | |
|
|
|
| Germany to put 2 percent NATO spending pledge in writing - POLITICO Europe |
| Germany to put 2 percent NATO spending pledge in writing POLITICO Europe |
 "Scholz and Putin" - Google News "Scholz and Putin" - Google News | 3h | |
|
|
|
 | Paul Newman's camp for sick kids rises from the ashes |
| ASHFORD, Conn. (AP) — Amarey Brookshire was devastated when she heard about the fire at the Hole in the... |
 Associated Press News: Breaking News | Latest News Today Associated Press News: Breaking News | Latest News Today | 3h | |
|
|
|
 | US speeds up Abrams tank delivery to Ukraine war zone |
| WASHINGTON (AP) — The Pentagon is speeding up its delivery of Abrams tanks to Ukraine, opting to send... |
 Associated Press News: Breaking News | Latest News Today Associated Press News: Breaking News | Latest News Today | 3h | |
|
|
|
| Japanese Premier Visits Kyiv as Ukraine War Divides Asia - The Wall Street Journal |
| Japanese Premier Visits Kyiv as Ukraine War Divides Asia The Wall Street Journal |
 "Russia-Ukraine war" - Google News "Russia-Ukraine war" - Google News | 3h | |
|
|
|
| Japanese and Chinese leaders visit opposing capitals in Ukraine war - BBC |
| Japanese and Chinese leaders visit opposing capitals in Ukraine war BBC |
 "Russia-Ukraine war" - Google News "Russia-Ukraine war" - Google News | 3h | |
|
|
|
| US speeds up Abrams tank delivery to Ukraine war zone - WTOP |
| US speeds up Abrams tank delivery to Ukraine war zone WTOP |
 "Russia-Ukraine war" - Google News "Russia-Ukraine war" - Google News | 3h | |
|
|
|
| NATO releases annual report amid ongoing war in Ukraine - DW (English) |
| NATO releases annual report amid ongoing war in Ukraine DW (English) |
 "Russia-Ukraine war" - Google News "Russia-Ukraine war" - Google News | 3h | |
|
|
|
| Post-Ukraine War, Eurasian Security Needs India, EU To Pilot The Change - Swarajya |
| Post-Ukraine War, Eurasian Security Needs India, EU To Pilot The Change Swarajya |
 "Russia-Ukraine war" - Google News "Russia-Ukraine war" - Google News | 3h | |
|
|
|
 | Why the U.S. Economy Could Crash This Summer |
| America is Going to Default This Summer – Speaker of the House Kevin McCarthy (R-CA) wants to have a... |
 19FortyFive 19FortyFive | 3h | |
|
|
|
| US calls conditions in Rwanda's detention centres harsh to life-threatening - The... |
| US calls conditions in Rwanda's detention centres harsh to life-threatening The Guardian |
 "global threats to U.S. security" - Google News "global threats to U.S. security" - Google News | 3h | |
|
|
|
| How Mimecast thinks differently about email security - ComputerWeekly.com |
| How Mimecast thinks differently about email security ComputerWeekly.com |
 "global threats to U.S. security" - Google News "global threats to U.S. security" - Google News | 3h | |
|
|
|
 | Opinion: America's tastes in a family pet are changing -- for the better, in my view |
| It would be easy to dismiss French bulldogs, with their squidgy, cartoon faces and small squat bodies,... |
 CNN.com - Top Stories CNN.com - Top Stories | 3h | |
|
|
|
 | Bailed out, arrested again: These charities boomed after the murder of George Floyd.... |
| |
 CNN.com - Top Stories CNN.com - Top Stories | 3h | |
|
|
|
| Putin's plan/ Zelensky's zest: Where Russia's Ukraine war stands on anniversary?... |
| Putin's plan/ Zelensky's zest: Where Russia's Ukraine war stands on anniversary? Hindustan Times |
 "G7 and Russia Ukraine war" - Google News "G7 and Russia Ukraine war" - Google News | 3h | |
|
|
|
| Winter's feared 'tripledemic' fizzled; new vaccines, at-home tests for flu, COVID-19,... |
| Winter's feared 'tripledemic' fizzled; new vaccines, at-home tests for flu, COVID-19, RSV on the horizon cleveland.com |
 "COVID" - Google News "COVID" - Google News | 3h | |
|
|
|
| Kingfisher Profits Slump 39% As Retailer Suffers Following Covid Reopening - Forbes |
| Kingfisher Profits Slump 39% As Retailer Suffers Following Covid Reopening Forbes |
 "COVID" - Google News "COVID" - Google News | 3h | |
|
|
|
| Biden signs bill on covid origins declassification - TribLIVE |
| Biden signs bill on covid origins declassification TribLIVE |
 "COVID" - Google News "COVID" - Google News | 3h | |
|
|
|
| Biden vows US will 'declassify' information about COVID's origins - Sky News |
| Biden vows US will 'declassify' information about COVID's origins Sky News |
 "COVID" - Google News "COVID" - Google News | 3h | |
|
|
|
| Japan, China leaders begin visits to rivals in Ukraine war – WDIO |
| Japan, China leaders begin visits to rivals in Ukraine war WDIO The post Japan, China leaders begin... |
 Russia - Ukraine War | The Russia News Russia - Ukraine War | The Russia News | 3h | |
|
|
|
| Chester Football Club – Official Website » SENIOR BLUES | March ... - Chester Football... |
| Chester Football Club – Official Website » SENIOR BLUES | March ... Chester Football Club |
 "Is Putin MAD?" - Google News "Is Putin MAD?" - Google News | 3h | |
|
|
|
 | AP Headline News - Mar 21 2023 09:00 (EDT) |
| |
 Associated Press Bulletins Associated Press Bulletins | 3h | |
|
|
|
 | India Can Bridge the U.S.-Russia Divide Over Ukraine, If It Chooses - The Diplomat |
| The Diplomat |
 "U.S. and Russia" - Google News "U.S. and Russia" - Google News | 3h | |
|
|
|
| Ukraine, Russia Trade Claims After Blast Rocks Crimean Town - U.S. News & World Report |
| Ukraine, Russia Trade Claims After Blast Rocks Crimean Town U.S. News & World Report |
 "US Intel: Putin gave orders to invade Ukraine" - Google News "US Intel: Putin gave orders to invade Ukraine" - Google News | 3h | |
|
|
|
| US tells China a Taiwan president stopover is 'nothing new' - New Canaan Advertiser |
| US tells China a Taiwan president stopover is 'nothing new' New Canaan Advertiser |
 "US Intel: Putin gave orders to invade Ukraine" - Google News "US Intel: Putin gave orders to invade Ukraine" - Google News | 3h | |
|
|
|
| New York, DC prepare for possible Trump indictment in hush money probe - CNN |
| New York, DC prepare for possible Trump indictment in hush money probe CNN |
 "Investigations of US Elections 2016" - Google News "Investigations of US Elections 2016" - Google News | 3h | |
|
|
|
| Belarusian Supreme Court Rejects Darya Losik's Appeal Against Her Two-Year Prison... |
| Belarusian Supreme Court Rejects Darya Losik's Appeal Against Her Two-Year Prison Term Radio Free Europe... |
 "Putin Biden summit" - Google News "Putin Biden summit" - Google News | 3h | |
|
|
|
| US investigates TikTok owner ByteDance's surveillance of journalists - Ars Technica |
| US investigates TikTok owner ByteDance's surveillance of journalists Ars Technica |
 "project raven" - Google News "project raven" - Google News | 4h | |
|
|
|
| Putin hosts Xi in Moscow as alliance grows - Northwest Arkansas Democrat-Gazette |
| Putin hosts Xi in Moscow as alliance grows Northwest Arkansas Democrat-Gazette |
 "Russia - China new strategic alliance by Putin and Xi" - Google News "Russia - China new strategic alliance by Putin and Xi" - Google News | 4h | |
|
|
|
 | "Weakened" Macron sticks with pension bill, eyes new reforms - source |
| 2023-03-21T12:34:37ZDozens of people were arrested across France after sporadic protests broke out hours... |
 Reuters Reuters | 4h | |
|
|
|
 | Explainer: What California"s atmospheric rivers mean for drought, floods, fires |
| 2023-03-21T12:47:59ZA view of flooded mobile homes in the Haven Acres Mobile Home Park after the San... |
 Reuters Reuters | 4h | |
|
|
|
 | Wall St set to open higher as bank fears ebb, focus on Fed |
| 2023-03-21T12:32:15ZInvestors on Tuesday (March 21) took some heart from the rescue of troubled lender... |
 Reuters Reuters | 4h | |
|
|
|
| Biden says International Criminal Court 'justified' following Putin arrest warrant... |
| Biden says International Criminal Court 'justified' following Putin arrest warrant Yahoo Life |
 "International criminal court issues arrest warrant for Putin" - Google News "International criminal court issues arrest warrant for Putin" - Google News | 4h | |
|
|
|
| The expanding horizon of thought policing - The Daily Star |
| The expanding horizon of thought policing The Daily Star |
 "Zelensky rejects the idea of Ukraine neutrality" - Google News "Zelensky rejects the idea of Ukraine neutrality" - Google News | 4h | |
|
|
|
| China's call for Ukraine ceasefire rebuffed by Kyiv - The Straits Times |
| China's call for Ukraine ceasefire rebuffed by Kyiv The Straits Times |
 "Zelensky rejects the idea of Ukraine neutrality" - Google News "Zelensky rejects the idea of Ukraine neutrality" - Google News | 4h | |
|
|
|
| Haley: Backward to think US should ignore Ukraine and focus on China - The Hill |
| Haley: Backward to think US should ignore Ukraine and focus on China The Hill |
 "Ukraine" - Google News "Ukraine" - Google News | 4h | |
|
|
|
| Ukraine calls for Russia to remove forces as they are 'not ready to ... - Sky News... |
| Ukraine calls for Russia to remove forces as they are 'not ready to ... Sky News Australia |
 "Ukraine" - Google News "Ukraine" - Google News | 4h | |
|
|
|
| Japanese Prime Minister Fumio Kishida arrives in Kyiv for surprise visit - Business... |
| Japanese Prime Minister Fumio Kishida arrives in Kyiv for surprise visit Business Standard |
 "XBB.1.5" - Google News "XBB.1.5" - Google News | 4h | |
|
|
|
| Windfall tax on locally-produced crude oil cut to Rs 3500 per tonne from Rs 4400... |
| Windfall tax on locally-produced crude oil cut to Rs 3500 per tonne from Rs 4400 per tonne Business... |
 "XBB.1.5" - Google News "XBB.1.5" - Google News | 4h | |
|
|
|
| Putin has made a surprise visit to the occupied city of Mariupol in Ukraine - KTEP |
| Putin has made a surprise visit to the occupied city of Mariupol in Ukraine KTEP |
 "russia - ukraine war 2022" - Google News "russia - ukraine war 2022" - Google News | 4h | |
|
|
|
| |
| Medical experts presented Chinese leaders with plans to prepare for an exit from zero-COVID policies.... |
 The Associated Press (Twitter) The Associated Press (Twitter) | 4h | |
|
|
|
| |
| The Associated Press retweeted: Former U.K. Prime Minister Boris Johnson... |
 The Associated Press (Twitter) The Associated Press (Twitter) | 4h | |
|
|
|
| |
| Gwyneth Paltrow is scheduled to stand trial on Tuesday in a lawsuit filed by a retired optometrist who... |
 The Associated Press (Twitter) The Associated Press (Twitter) | 4h | |
|
|
|
| Queen Margaret student uses his skills in Ukraine - The Edinburgh Reporter |
| Queen Margaret student uses his skills in Ukraine The Edinburgh Reporter |
 "kharkiv" - Google News "kharkiv" - Google News | 4h | |
|
|
|
| Russia's most elite troops use Soviet-era paper maps - defence-blog.com |
| Russia's most elite troops use Soviet-era paper maps defence-blog.com |
 "kharkiv" - Google News "kharkiv" - Google News | 4h | |
|
|
|
| Ukraine Russia war live updates: Kyiv says Russian missiles destroyed - USA TODAY |
| Ukraine Russia war live updates: Kyiv says Russian missiles destroyed USA TODAY |
 "kyiv" - Google News "kyiv" - Google News | 4h | |
|
|
|
| Japan PM Kishida arrives in Kyiv - Ukrinform |
| Japan PM Kishida arrives in Kyiv Ukrinform |
 "kyiv" - Google News "kyiv" - Google News | 4h | |
|
|
|
| Wind Tunnel Market Share, Growth Based on Business ... - Digital Journal |
| Wind Tunnel Market Share, Growth Based on Business ... Digital Journal |
 "intelligence assessments and analysis of the Russia - Ukraine War 2022" - Google News "intelligence assessments and analysis of the Russia - Ukraine War 2022" - Google News | 4h | |
|
|
|
| Marine Electronic Navigation System Market to See Massive Growth ... - Digital Journal |
| Marine Electronic Navigation System Market to See Massive Growth ... Digital Journal |
 "intelligence assessments and analysis of the Russia - Ukraine War 2022" - Google News "intelligence assessments and analysis of the Russia - Ukraine War 2022" - Google News | 4h | |
|
|
|
| Stainless Steel Welded Tube Market to See Massive Growth by ... - Digital Journal |
| Stainless Steel Welded Tube Market to See Massive Growth by ... Digital Journal |
 "intelligence assessments and analysis of the Russia - Ukraine War 2022" - Google News "intelligence assessments and analysis of the Russia - Ukraine War 2022" - Google News | 4h | |
|
|
|
| Outsourced Semiconductor Assembly and Test (OSAT) Market to ... - Digital Journal |
| Outsourced Semiconductor Assembly and Test (OSAT) Market to ... Digital Journal |
 "intelligence assessments and analysis of the Russia - Ukraine War 2022" - Google News "intelligence assessments and analysis of the Russia - Ukraine War 2022" - Google News | 4h | |
|
|
|
| What Happens if Donald Trump Doesn't Turn Himself In - Newsweek |
| What Happens if Donald Trump Doesn't Turn Himself In Newsweek |
 trump - Google News trump - Google News | 4h | |
|
|
|
| Team Trump tries to quash Georgia special grand jury report - MSNBC |
| Team Trump tries to quash Georgia special grand jury report MSNBC |
 trump - Google News trump - Google News | 4h | |
|
|
|
| Can Donald Trump run for president again after being arrested? | khou.com - KHOU.com |
| Can Donald Trump run for president again after being arrested? | khou.com KHOU.com |
 trump - Google News trump - Google News | 4h | |
|
|
|
| Trump grand jury live updates: Waiting game on looming indictment in porn star Stormy... |
| Trump grand jury live updates: Waiting game on looming indictment in porn star Stormy Daniels payoff CNBC |
 trump - Google News trump - Google News | 4h | |
|
|
|
| Some Trump supporters gather outside Manhattan court in protest of case - FOX 5 New... |
| Some Trump supporters gather outside Manhattan court in protest of case FOX 5 New York |
 trump - Google News trump - Google News | 4h | |
|
|
|
| Opinion | Media take on Trump indictment is silly and wrong - The Washington Post |
| Opinion | Media take on Trump indictment is silly and wrong The Washington Post |
 trump - Google News trump - Google News | 4h | |
|
|
|
| Law enforcement prepare for possible indictment of Trump - CBS News |
| Law enforcement prepare for possible indictment of Trump CBS News |
 trump - Google News trump - Google News | 4h | |
|
|
|
| Trump claimed the 'radical left' hacked his phone during a prayer call - Business... |
| Trump claimed the 'radical left' hacked his phone during a prayer call Business Insider |
 trump - Google News trump - Google News | 4h | |
|
|
|
| Lindsey Graham: $20 says Trump beats Biden in 2024 - Yahoo! Voices |
| Lindsey Graham: $20 says Trump beats Biden in 2024 Yahoo! Voices |
 "covid -19 origins" - Google News "covid -19 origins" - Google News | 4h | |
|
|
|
| Huawei has replaced thousands of U.S.-banned parts in its products, founder says... |
| Huawei has replaced thousands of U.S.-banned parts in its products, founder says Yahoo Finance |
 "covid -19 origins" - Google News "covid -19 origins" - Google News | 4h | |
|
|
|
| (16) Top US and Russian diplomats meet on sidelines of G20 for first ... - CNN International |
| (16) Top US and Russian diplomats meet on sidelines of G20 for first ... CNN International |
 "blinken and lavrov" - Google News "blinken and lavrov" - Google News | 4h | |
|
|
|
| |
| ISW retweeted: #Xi's refusal to explicitly align #China with #Russia in... |
 ISW (Twitter) ISW (Twitter) | 4h | |
|
|
|
| |
| ISW retweeted: Chinese President #Xi Jinping met with Russian President... |
 ISW (Twitter) ISW (Twitter) | 4h | |
|
|
|
| TikTok updates content rulebook as pressure from West builds |
| |
 All Stories All Stories | 4h | |
|
|
|
| US probes reports of steering glitch on newer Honda Civics |
| |
 All Stories All Stories | 4h | |
|
|
|
| Russia's war in Ukraine: Live updates - CNN International |
| Russia's war in Ukraine: Live updates CNN International |
 "zelensky" - Google News "zelensky" - Google News | 4h | |
|
|
|
| Japan PM Kishida to meet Zelensky in Ukraine - ZAWYA |
| Japan PM Kishida to meet Zelensky in Ukraine ZAWYA |
 "zelensky" - Google News "zelensky" - Google News | 4h | |
|
|
|
| Israeli minister says there's 'no such thing as a Palestinian people,' inviting US... |
| Israeli minister says there's 'no such thing as a Palestinian people,' inviting US rebuke CNN |
 "National Security Council" - Google News "National Security Council" - Google News | 4h | |
|
|
|
 | On National Security | Space Force and commercial industry taking ... - SpaceNews |
| SpaceNews |
 "National Security Council" - Google News "National Security Council" - Google News | 4h | |
|
|
|
| Canada's foreign minister says China peace talks in Moscow will ... - CTV News |
| Canada's foreign minister says China peace talks in Moscow will ... CTV News |
 "Russia Ukraine peace talks" - Google News "Russia Ukraine peace talks" - Google News | 4h | |
|
|
|
| How Can Americans Outside the USA See The Idaho College Murders on Discovery Plus... |
| How Can Americans Outside the USA See The Idaho College Murders on Discovery Plus in 2023? විවර පුවත් |
 "Bryan Christopher Kohberger" - Google News "Bryan Christopher Kohberger" - Google News | 4h | |
|
|
|
| Attorney seeks to discredit Michael Cohen in Trump grand jury ... - CBS News |
| Attorney seeks to discredit Michael Cohen in Trump grand jury ... CBS News |
 "Election 2016 Investigations" - Google News "Election 2016 Investigations" - Google News | 4h | |
|
|
|
| Six cargo ships arrive at Odesa Coast after extension of Black Sea Grain Initiative... |
| Six cargo ships arrive at Odesa Coast after extension of Black Sea Grain Initiative - SAFETY4SEA SAFETY4SEA |
 "Odessa" - Google News "Odessa" - Google News | 4h | |
|
|
|
 | Boris Johnson says 'partygate' untruths were honest mistake |
| LONDON (AP) — Former U.K. Prime Minister Boris Johnson acknowledged Tuesday that he misled Parliament... |
 Associated Press News: Breaking News | Latest News Today Associated Press News: Breaking News | Latest News Today | 4h | |
|
|
|
| Modi Govt blocks pro-Khalistan Twitter accounts; Crackdown amid hunt for Amritpal... |
| Modi Govt blocks pro-Khalistan Twitter accounts; Crackdown amid hunt for Amritpal Singh Hindustan Times |
 "twitter down" - Google News "twitter down" - Google News | 4h | |
|
|
|
 | Should You Buy The Botox Maker Over Johnson & Johnson Stock? |
| Even if we look at a longer time frame, AbbVie fares better, with its sales rising at an average annual... |
 Markets and Business News Review Markets and Business News Review | 4h | |
|
|
|
| First Look Analysts Research Calls for Tuesday, March 21 |
| This report was sent to Briefing.com subscribers earlier today. Upgrades: > Assurant (AIZ) upgraded... |
 Markets and Business News Review Markets and Business News Review | 4h | |
|
|
|
 | EV Component Stocks Are Outperforming This Year. Should You Buy? |
| Our theme of EV Supplier stocks has fared relatively well this year, rising by about 8% year-to-date,... |
 Markets and Business News Review Markets and Business News Review | 4h | |
|
|
|
| Bed Bath & Beyond Collapses |
| The bottom fell out of the Bed Bath & Beyond Inc. (NASDAQ: BBBY) share price. A rescue effort was... |
 Markets and Business News Review Markets and Business News Review | 4h | |
|
|
|
| Preview of new Uvalde elementary school to be presented to public on Tuesday night... |
| Preview of new Uvalde elementary school to be presented to public on Tuesday night FOX 29 |
 "Uvalde" - Google News "Uvalde" - Google News | 4h | |
|
|
|
| New Report Shows Real-Time Events Surrounding Uvalde School Shooting - NBC 5 Dallas-Fort... |
| New Report Shows Real-Time Events Surrounding Uvalde School Shooting NBC 5 Dallas-Fort Worth |
 "Uvalde" - Google News "Uvalde" - Google News | 4h | |
|
|
|
| Pope Francis is praised in U.N. talks for efforts to combat anti-Muslim ... - Catholic... |
| Pope Francis is praised in U.N. talks for efforts to combat anti-Muslim ... Catholic Review of Baltimore |
 "pope francis" - Google News "pope francis" - Google News | 4h | |
|
|
|
| New Pope Francis Documentary Has One-Night Screening at Park ... - Broadway World |
| New Pope Francis Documentary Has One-Night Screening at Park ... Broadway World |
 "pope francis" - Google News "pope francis" - Google News | 4h | |
|
|
|
 | US probes reports of steering glitch on newer Honda Civics |
| DETROIT (AP) — U.S. auto safety regulators are investigating complaints from Honda Civic drivers that... |
 Associated Press News: Breaking News | Latest News Today Associated Press News: Breaking News | Latest News Today | 4h | |
|
|
|
| With DISA's award of a new Indo-Pacific network, one company is transforming DoD... |
| With DISA's award of a new Indo-Pacific network, one company is transforming DoD global networks Breaking... |
 "global threats to U.S. security" - Google News "global threats to U.S. security" - Google News | 4h | |
|
|
|
| Man is pushed into side of moving train unprovoked, left bleeding on ... - 1010 WINS |
| Man is pushed into side of moving train unprovoked, left bleeding on ... 1010 WINS |
 "Sunset park brooklyn" - Google News "Sunset park brooklyn" - Google News | 4h | |
|
|
|
| Will Trump supporters protest? Muted response so far raises doubts. - Tampa Bay Times |
| Will Trump supporters protest? Muted response so far raises doubts. Tampa Bay Times |
 "Mar-a-Lago" - Google News "Mar-a-Lago" - Google News | 4h | |
|
|
|
| Trump's call for protests met with mixed reaction - NewsNation Now |
| Trump's call for protests met with mixed reaction NewsNation Now |
 "Mar-a-Lago" - Google News "Mar-a-Lago" - Google News | 4h | |
|
|
|
 | Could Trump Really Be President From Prison? |
| World-famous attorney Alan Dershowitz, who contributed to O.J. Simpson's defense team and Donald Trump's... |
 19FortyFive 19FortyFive | 4h | |
|
|
|
 | Why Kamala Harris Is a Failure |
| Biden Has a Kamala Harris Problem: The African-American vote proved to be a decisive factor behind Joe... |
 19FortyFive 19FortyFive | 4h | |
|
|
|
 | New Ukraine Footage Shows Drone Attacking Russian Missiles |
| Watch Russian Missile Systems Get Hit By Ukrainian Loitering Munitions – Videos shared on Telegram and... |
 19FortyFive 19FortyFive | 4h | |
|
|
|
| news.google.com/rss/articles/C… |
| news.google.com/rss/articles/C…The post news.google.com/rss/articles/C… first appeared on The News Links... |
 News-Links – news-links.org News-Links – news-links.org | 4h | |
|
|
|
| Saudi Arabia frees American who was jailed over critical tweets about crown prince... |
| Saudi Arabia frees American who was jailed over critical tweets about crown prince AOL The post Saudi... |
 Russia - Ukraine War | The Russia News Russia - Ukraine War | The Russia News | 4h | |
|
|
|
| Russia shortages in Ukraine likely as prisoners pardoned: UK intel – Business Insider |
| Russia shortages in Ukraine likely as prisoners pardoned: UK intel Business Insider The post Russia... |
 Russia - Ukraine War | The Russia News Russia - Ukraine War | The Russia News | 4h | |
|
|
|
| Xi Jinping In Russia, Met Vladimir Putin In Moscow | Latest News | Russia Ukraine... |
| Xi Jinping In Russia, Met Vladimir Putin In Moscow | Latest News | Russia Ukraine War | News18 News18... |
 Russia - Ukraine War | The Russia News Russia - Ukraine War | The Russia News | 4h | |
|
|
|
| All the News That's Fit: Exercise bursts, lingering effects of COVID ... - The San... |
| All the News That's Fit: Exercise bursts, lingering effects of COVID ... The San Diego Union-Tribune |
 "COVID" - Google News "COVID" - Google News | 4h | |
|
|
|
| Biden signs bill on COVID origins declassification - ABC News |
| Biden signs bill on COVID origins declassification ABC News |
 "COVID" - Google News "COVID" - Google News | 4h | |
|
|
|
| Critics continue to question SMH's handling of COVID - WWSB |
| Critics continue to question SMH's handling of COVID WWSB |
 "COVID" - Google News "COVID" - Google News | 4h | |
|
|
|
| Cyprus court rules Briton's wife murder confession was lawfully obtained - Yahoo... |
| Cyprus court rules Briton's wife murder confession was lawfully obtained Yahoo Eurosport UK |
 "Is Putin ill with blood cancer?" - Google News "Is Putin ill with blood cancer?" - Google News | 4h | |
|
|
|
| Japan, China leaders begin visits to rivals in Ukraine war - WDIO |
| Japan, China leaders begin visits to rivals in Ukraine war WDIO |
 "Biden: Putin's war on Ukraine is a genocide" - Google News "Biden: Putin's war on Ukraine is a genocide" - Google News | 4h | |
|
|
|
| Ukraine latest: Putin makes visit to Crimea, Mariupol - Nikkei Asia |
| Ukraine latest: Putin makes visit to Crimea, Mariupol Nikkei Asia |
 "Biden: Putin's war on Ukraine is a genocide" - Google News "Biden: Putin's war on Ukraine is a genocide" - Google News | 4h | |
|
|
|
| Trump sweats an arrest. We should sweat a second term. - The Japan Times |
| Trump sweats an arrest. We should sweat a second term. The Japan Times |
 "Mar-a-Lago documents" - Google News "Mar-a-Lago documents" - Google News | 4h | |
|
|
|
| Biden urges compromise on Israeli judicial reform - The Jewish Chronicle |
| Biden urges compromise on Israeli judicial reform The Jewish Chronicle |
 "Biden in Israel" - Google News "Biden in Israel" - Google News | 4h | |
|
|
|
| Longtime Israel supporters in U.S. turn outraged critics - Los Angeles Times |
| Longtime Israel supporters in U.S. turn outraged critics Los Angeles Times |
 "Biden in Israel" - Google News "Biden in Israel" - Google News | 4h | |
|
|
|
| At Ukraine's front, police try to evacuate holdout families - The Journal |
| At Ukraine's front, police try to evacuate holdout families The Journal |
 "russia-ukraine war 2022" - Google News "russia-ukraine war 2022" - Google News | 4h | |
|
|
|
| Stop The Russia-Ukraine War For The Greater Good – OpEd - Eurasia Review |
| Stop The Russia-Ukraine War For The Greater Good – OpEd Eurasia Review |
 "russia-ukraine war 2022" - Google News "russia-ukraine war 2022" - Google News | 4h | |
|
|
|
| |
| news.google.com/rss/articles/C… |
 Tweets by @mikenov Tweets by @mikenov | 4h | |
|
|
|
| Pentagon video shows Russian jet dumping fuel on US drone - The Delaware County Daily... |
| Pentagon video shows Russian jet dumping fuel on US drone The Delaware County Daily Times |
 "Biden in Kyiv 2023" - Google News "Biden in Kyiv 2023" - Google News | 4h | |
|
|
|
| Coast Copper Signs MOU with five other Companies to Study Viability of Hub and Spoke... |
| Coast Copper Signs MOU with five other Companies to Study Viability of Hub and Spoke Mill Complex at... |
 "project raven" - Google News "project raven" - Google News | 4h | |
|
|
|
| Japan PM Kishida Visits Bucha As Part Of Ukraine Visit: AFP - Barron's |
| Japan PM Kishida Visits Bucha As Part Of Ukraine Visit: AFP Barron's |
 "Bucha" - Google News "Bucha" - Google News | 4h | |
|
|
|
 | Russia"s war on Ukraine latest: "Dear friends" Putin and Xi meet again |
| 2023-03-21T12:11:13ZRussian President Vladimir Putin and Chinese leader Xi Jinping discussed Beijing's... |
 Reuters Reuters | 4h | |
|
|
|
 | Putin, Xi discuss Chinese peace proposal for Ukraine as US denounces visit |
| 2023-03-21T11:57:51ZChinese President Xi Jinping met his President Vladimir Putin in Moscow on Monday,... |
 Reuters Reuters | 4h | |
|
|
|
 | Bank stocks steady after Swiss rescue as focus turns to Fed |
| 2023-03-21T12:01:29ZInvestors stepped cautiously into bank stocks on Tuesday, emboldened by the rescue... |
 Reuters Reuters | 4h | |
|
|
|
 | TikTok CEO says company at "pivotal" moment as some U.S. lawmakers seek ban |
| 2023-03-21T12:13:07ZThe TikTok logo is pictured outside the company's U.S. head office in Culver City,... |
 Reuters Reuters | 4h | |
|
|
|
 | India hunts Sikh preacher who has revived calls for homeland |
| 2023-03-21T11:55:51ZAmritpal Singh, a radical Sikh leader, leaves the holy Sikh shrine of the Golden... |
 Reuters Reuters | 4h | |
|
|
|
| South Jersey Times girls basketball postseason honors, 2022-23 - NJ.com |
| South Jersey Times girls basketball postseason honors, 2022-23 NJ.com |
 "g-7 2022" - Google News "g-7 2022" - Google News | 4h | |
|
|
|
| Putin Should 'Shut Up' After Comments Showed Weakness—Former Commander - Newsweek |
| Putin Should 'Shut Up' After Comments Showed Weakness—Former Commander Newsweek |
 "kharkiv" - Google News "kharkiv" - Google News | 4h | |
|
|
|
| |
| In remarks prepared for the American Bankers Association, Treasury Secretary Janet Yellen says the U.S.... |
 The Associated Press (Twitter) The Associated Press (Twitter) | 4h | |
|
|
|
| Indicting Trump with weak case undermines the justice system - The Arizona Republic |
| Indicting Trump with weak case undermines the justice system The Arizona Republic |
 trump - Google News trump - Google News | 4h | |
|
|
|
| Jordan pans Trump's hush money scandal as a 'bookkeeping error' - MSNBC |
| Jordan pans Trump's hush money scandal as a 'bookkeeping error' MSNBC |
 trump - Google News trump - Google News | 4h | |
|
|
|
| Fact Check: Did Donald Trump Sue Stormy Daniels and Win? - Newsweek |
| Fact Check: Did Donald Trump Sue Stormy Daniels and Win? Newsweek |
 trump - Google News trump - Google News | 4h | |
|
|
|
| Opinion | Make No Mistake, the Investigation of Donald Trump and the Stormy Daniels... |
| Opinion | Make No Mistake, the Investigation of Donald Trump and the Stormy Daniels Scheme Is Serious The... |
 trump - Google News trump - Google News | 4h | |
|
|
|
| What would actually happen if Ukraine joined the EU? - Euronews |
| What would actually happen if Ukraine joined the EU? Euronews |
 "russia - ukraine war 2022" - Google News "russia - ukraine war 2022" - Google News | 4h | |
|
|
|
| War pares back LGPS's post-covid recovery - Local Government Chronicle |
| War pares back LGPS's post-covid recovery Local Government Chronicle |
 "russia - ukraine war 2022" - Google News "russia - ukraine war 2022" - Google News | 4h | |
|
|
|
| Artificial Intelligence in Epidemiology Market 2023 Strategic ... - Digital Journal |
| Artificial Intelligence in Epidemiology Market 2023 Strategic ... Digital Journal |
 "intelligence assessments and analysis of the Russia - Ukraine War 2022" - Google News "intelligence assessments and analysis of the Russia - Ukraine War 2022" - Google News | 4h | |
|
|
|
| Japanese leader arrives in Kyiv as China's Xi visits Russia - The Hill |
| Japanese leader arrives in Kyiv as China's Xi visits Russia The Hill |
 "kyiv" - Google News "kyiv" - Google News | 4h | |
|
|
|
| Japan's PM offers Ukraine support as China's Xi backs Russia - Spectrum News NY1 |
| Japan's PM offers Ukraine support as China's Xi backs Russia Spectrum News NY1 |
 "kyiv" - Google News "kyiv" - Google News | 4h | |
|
|
|
| Kyiv and Moscow trade claims after 'attack on Russian cruise missiles' - Irish Examiner |
| Kyiv and Moscow trade claims after 'attack on Russian cruise missiles' Irish Examiner |
 "kyiv" - Google News "kyiv" - Google News | 4h | |
|
|
|
| Japanese leader arrives in Kyiv as China's Xi visits Russia - Daily Herald |
| Japanese leader arrives in Kyiv as China's Xi visits Russia Daily Herald |
 "kyiv" - Google News "kyiv" - Google News | 4h | |
|
|
|
| Japanese leader arrives in Kyiv as China's Xi visits Russia - Yahoo News |
| Japanese leader arrives in Kyiv as China's Xi visits Russia Yahoo News |
 "kyiv" - Google News "kyiv" - Google News | 4h | |
|
|
|
| Japanese Leader Arrives in Kyiv as China's Xi Visits Russia - U.S. News & World Report |
| Japanese Leader Arrives in Kyiv as China's Xi Visits Russia U.S. News & World Report |
 "kyiv" - Google News "kyiv" - Google News | 4h | |
|
|
|
| Japan PM Kishida arrives in Kyiv for talks with Zelenskyy - Nikkei Asia |
| Japan PM Kishida arrives in Kyiv for talks with Zelenskyy Nikkei Asia |
 "kyiv" - Google News "kyiv" - Google News | 4h | |
|
|
|
 | Biden Signs Resolution Blocking D.C. Bill That Would Reduce ... - National Review |
| National Review |
 "covid -19 origins" - Google News "covid -19 origins" - Google News | 4h | |
|
|
|
 | Toronto and UK Concern Groups Rally for Release of All 47 Pro-Democracy Political... |
| Political Prisoner Concern Groups launched rallies in Toronto and London on March 17, to urge the Hong... |
 The Epoch Times | The Epoch Times The Epoch Times | The Epoch Times | 4h | |



No comments:
Post a Comment